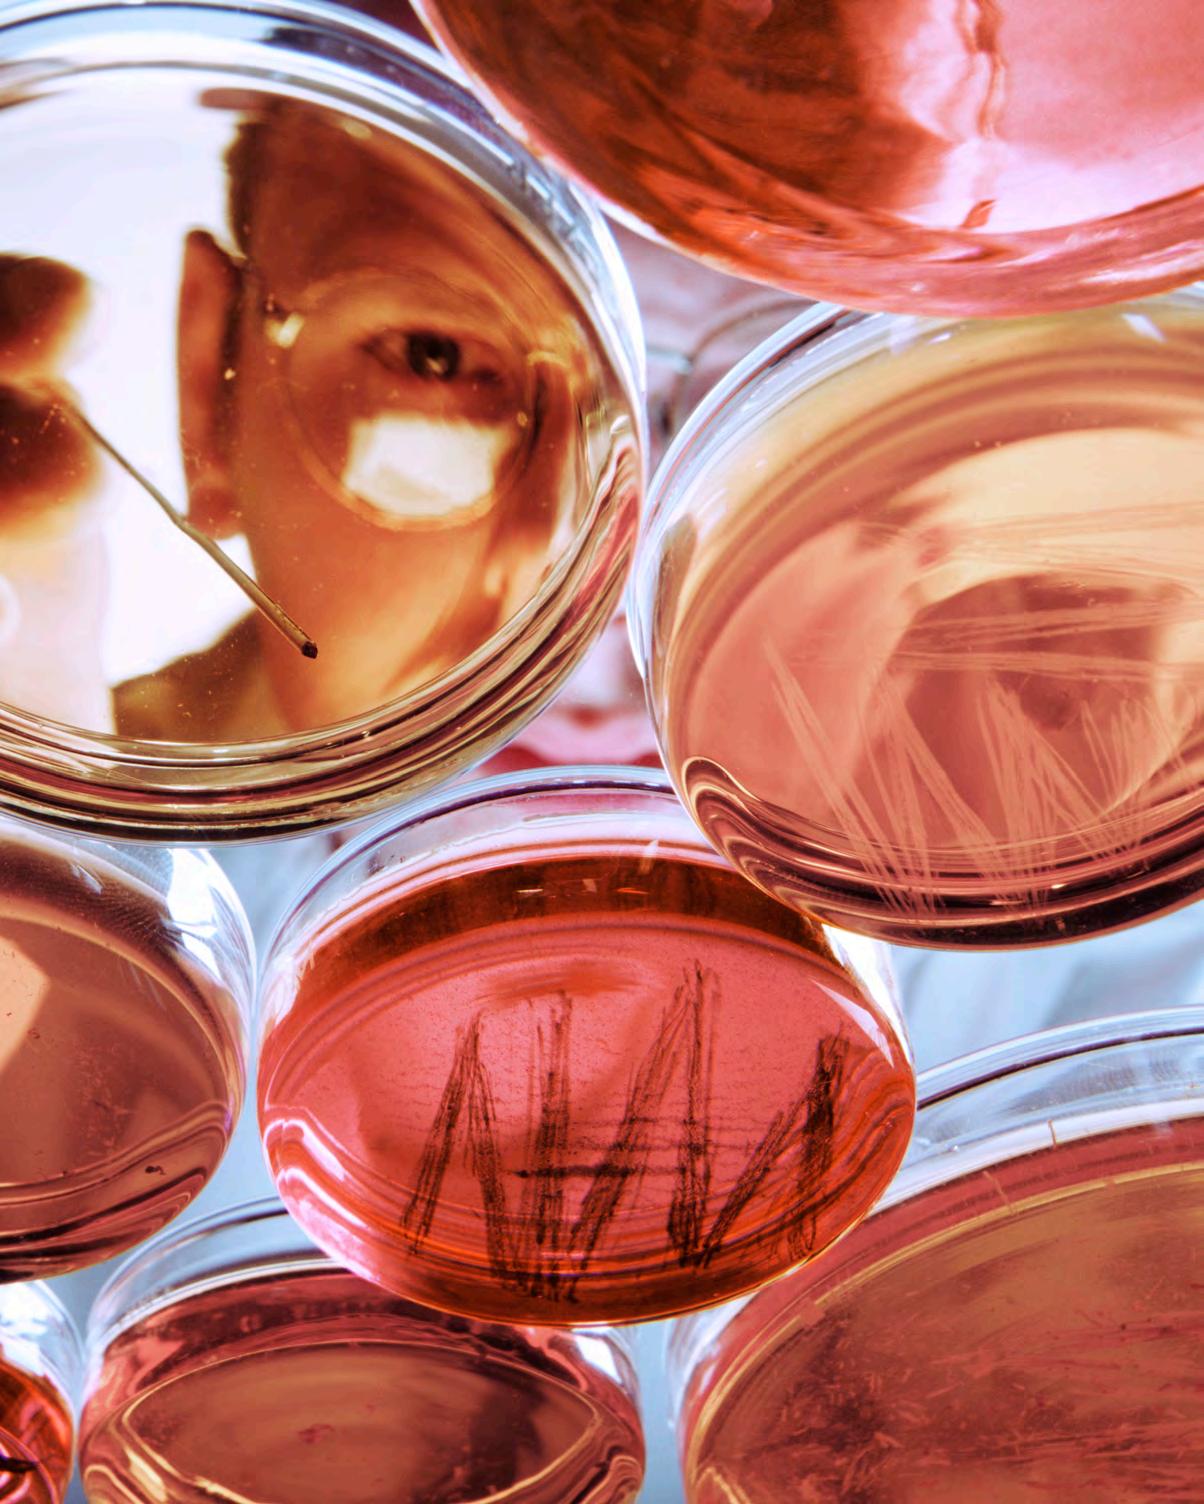

Ingeniera Bióloga Agrónomo
Empresario







Philadelphia Orlando Panamá Arecibo San Germán Ponce Bayamón Barranquitas Fajardo Guayama *Humacao *Caguas *Coamo Metro Aguadilla Optometría Derecho ¡BIENVENIDO A TU CASA DE ESTUDIOS! * Centros universitarios adscritos a recintos ** Centros de carreras técnicas (Intertec) PROGRAMAS ACADÉMICOS Presenciales Online WhatsApp 787.754.7597
Porque contribuimos a la sociedad, educando a personas que provienen de los diversos sectores socioeconómicos, dentro y fuera de Puerto Rico. Incorporamos en nuestros ofrecimientos y servicios, modalidades innovadoras de estudio apoyadas por la informática y las telecomunicaciones.
En la Universidad Interamericana de Puerto Rico aspiramos a que nuestros estudiantes y egresados sean ciudadanos responsables, cultos, con valores democráticos y cristianos, conscientes de su obligación social y ambiental, para que puedan desempeñarse competentemente y que ejerzan liderato en el contexto ocupacional o profesional.
Perseguimos maximizar el potencial educativo de los estudiantes en un ambiente libre de discrimen, en cumplimiento con la ley, la reglamentación y los estándares de acreditación; en armonía con la búsqueda de la excelencia académica, el pensamiento crítico, el conocimiento científico, la sensibilidad hacia las artes, la responsabilidad ética y las destrezas de convivencia social. Somos una universidad de vanguardia, con tradición de campeones que te acompañará en el camino de tu transformación hacia ese profesional de excelencia al que tanto aspiras.

3
AHORA PUEDES SOLICITAR
INFORMACIÓN A TRAVÉS DE



DIRECTORIO SISTÉMICO
Recinto de Aguadilla
(787) 891-0925
Recinto de Arecibo
(787) 878-5475
Recinto de Barranquitas
(787) 857-3600
Recinto de Bayamón
(787) 279-1912
Recinto de Fajardo
(787) 863-2390
Recinto de Guayama
(787) 864-2222
Recinto Metropolitano
(787) 767-1147
Recinto de Ponce
(787) 284-1912
Recinto de Germán
(787) 264-1912
Facultad de Derecho
(787) 751-1912
Escuela de Optometría
(787) 765-1915
Centros Universitarios:
Caguas
(787) 620-2077
Humacao
(787) 850-1774
aguadilla.inter.edu
arecibo.inter.edu
br.inter.edu
bayamon.inter.edu
fajardo.inter.edu
guayama.inter.edu
metro.inter.edu
ponce.inter.edu
sg.inter.edu
derecho.inter.edu
optonet.inter.edu
Escuela de INGENIERÍA
CONOCE NUESTRA ESCUELA
Desde el año 1997, cuando se inauguran sus nuevas instalaciones, la Escuela de Ingeniería de la Universidad Interamericana de Puerto Rico ha logrado posicionarse como uno de los centros educativos más innovadores en Puerto Rico y el Caribe, enfocada en el desarrollo de proyectos innovadores, investigativos y multidisciplinarios para industrias emergentes, entre ellas, la aeroespacial.
Su sede en el Recinto de Bayamón, cuenta con modernos laboratorios para la práctica de sus estudiantes. Sus instalaciones fomentan la interacción entre estudiantes y facultad, así como un ambiente de armonía, trabajo en equipo y desarrollo de ideas.
El 29 de agosto de 2021, un grupo de estudiantes y su profesor, hicieron historia al lograr colocar el primer satélite boricua en el espacio mediante un proyecto colaborativo con la NASA.

Sus programas de Bachillerato en Ingeniería Mecánica, Bachillerato
en Ingeniería Eléctrica, Bachillerato en Ingeniería de Computadoras y Bachillerato en Ingeniería Industrial están acreditados por la reconocida entidad Accreditation Board for Engineering and Technology.
El nuevo programa de Bachillerato en Ingeniería Arquitectónica, único en Puerto Rico, enfatiza aspectos de ingeniería civil, ingeniería mecánica e ingeniería eléctrica en el diseño de un edificio y en el proceso de su construcción.
Todos los recintos de la Universidad Interamericana de Puerto Rico ofrecen el programa de preingeniería, el cual permite que luego de aprobados los cursos requeridos, los estudiantes puedan realizar un traslado articulado al Recinto de Bayamón.
Los estudiantes que completen su grado de bachillerato, pueden optar por solicitar admisión a uno de los programas de Maestría en Ingeniería Mecánica o Maestría en Ciencias en Ingeniería Mecánica con énfasis en energía o aeroespacial.
6
ingeweb.bayamon.inter.edu








CONTACTO: T. 787.279.1912 ext. 2249 7
Escuela de AERONÁUTICA
CONOCE NUESTRA ESCUELA
Localizada en el Aeropuerto Fernando Ribas Dominicci de Isla Grande en San Juan, Puerto Rico.
Primera y única Escuela de Aeronaútica en Puerto Rico y el Caribe con sus dos programas de bachilleratos acreditados por la Aviation Accreditation Board International (AABI).

Cuenta con un simulador de vuelo ALSIM con la capacidad de representar aviones comerciales por medio de gráficas avanzadas y escenarios reales de vuelo.

Posee un hangar y una flota de once (11) aviones.
Ofrece a sus estudiantes del programa de Piloto Profesional la oportunidad de participar en acuerdos con Delta Air Lines y JetBlue.
AEROPUERTO DE ISLA GRANDE
aeroweb.bayamon.inter.edu 8








9 Bachillerato en Ciencias de AviaciónAdministración de Sistemas de Aviones (Piloto Profesional) Bachillerato en Ciencias de AviaciónGerencia de Aviación Grado Asociado en CienciasPiloto Comercial CONTACTO: T. 787.279.1912 ext. 2400
CERTIFICADOS
GRADOS
CONOCE NUESTRO RECINTO
El Recinto de Aguadilla contribuye al crecimiento social, económico y cultural del área noroeste. Posee una excelente y comprometida facultad, una variada oferta académica, ayudas económicas y una infraestructura a la vanguardia de la tecnología, los cuales convierten al recinto en la mejor alternativa académica privada del área noroeste.

El Recinto de Aguadilla promueve la vida estudiantil y la integración con la comunidad a la que sirve, por medio de los programas académicos que ofrece en diferentes disciplinas: administración de empresas, ciencias y tecnología, ciencias sociales y de la conducta, educación y ciencias de la
salud. Ofrece carreras técnicas donde se destaca su Instituto de Artes Culinarias, con modernas instalaciones físicas, además de grados asociados, bachilleratos, y maestrías en programas como justicia criminal y consejería psicológica, entre muchas otras. Aquí encontrarás el lugar perfecto que estás buscando para desarrollar tu futuro académico.
aguadilla.inter.edu
10
TÉCNICOS
→ El recinto cuenta con laboratorios de biotecnología, toxicología, microbiología y ciencias ambientales. Todos contienen equipo científico de última generación para la realización de experimentos. ASOCIADOS BACHILLERATOS MAESTRÍAS
→ El Centro Universitario de Aprendizaje ofrece tutorías virtuales a los estudiantes del Recinto de Aguadilla mediante la herramienta de Blackboard Collaborate Ultra con el fin de ofrecer apoyo en desarrollo de destrezas en las diversas materias.




→ La Oficina de Educación a Distancia e Internacionalización trabaja para desarrollar técnicas en el aprendizaje a distancia mediante una infraestructura tecnológica de vanguardia que facilita y ofrece apoyo constante a la facultad y al estudiantado.


UIPR - RECINTO DE AGUADILLA PO BOX 20000 Aguadilla, PR 00605 T. 787.891.0925 787.931.0931
11
CERTIFICADOS
CONOCE NUESTRO RECINTO
El Recinto de Arecibo fue fundado en 1957. Localizado en la parte norte-central de la Isla, está situado en el tope de una colina con una hermosa vista al Océano Atlántico. Su compromiso es mantener la excelencia de los servicios y los productos que provee a quienes nos honran con seleccionarnos como su opción universitaria.
El Recinto de Arecibo cuenta con una vigorosa oferta académica que contribuye a la formación y participación de profesionales en el campo laboral, de las siguientes disciplinas: ciencias económicas y administrativas, ciencias sociales, ciencias y tecnología, educación, ciencias de la salud y estudios humanísticos. Ofrece carreras cortas, grados asociados, bachilleratos, maestrías y doctorado. La Inter Arecibo se reafirma en continuar estrechando sus lazos y colaborando con la comunidad de la zona norte, que la ha honrado con su apoyo por más de 60
años, reconociendo y confiando su educación en nuestra unidad académica.

→ El Recinto de Arecibo brinda las herramientas necesarias para guiar los pasos del estudiante hacia el logro de su meta que es graduarse.
arecibo.inter.edu
12
→ El recinto cuenta con una excelente infraestructura de redes y sistemas para la comunicación digital y visual. TÉCNICOS GRADOS ASOCIADOS BACHILLERATOS MAESTRÍAS DOCTORADO






13 UIPR - RECINTO DE ARECIBO PO BOX 4050 Arecibo, PR 00614-4050 T. 787.878.5475
CONOCE NUESTRO RECINTO

El Recinto de Barranquitas, única institución de educación superior en la zona central de la Isla, ha brindado sus servicios por sesenta y seis años consecutivos. Su evolución, de centro de extensión educativa a una sólida institución universitaria, se percibe en la variada oferta académica que incluye certificados técnicos, grados asociados, bachilleratos, maestrías y el único doctorado que se ofrece en Puerto Rico en la especialidad de Biotecnología Internacional.
En el recinto, la disponibilidad de una tecnología avanzada con acogedoras facilidades físicas, además de la calidad de la enseñanza y de los recursos educativos, favorecen la retención estudiantil y propician los proyectos de investigación y la relación entre universidadempresa y universidad-medio ambiente. El Instituto de Biotecnología Sustentable cuenta con la instrumentación científica y las tecnologías requeridas para realizar investigación de alto nivel en áreas como la biomédica, la agricultura y la protección del medio ambiente. Otros
proyectos se desarrollan en el Centro de Cultivo de Algas, en el Laboratorio de Micropropagación Animal y Vegetal y en el Centro de Nanobiotecnología.
Programas académicos como enfermería, radiología, justicia criminal, desarrollo empresarial y ciencias gastronómicas, entre otros, también han posicionado al recinto como una institución que se distingue por su calidad académica tanto en cursos presenciales como en línea. Esta calidad también se percibe en los servicios que ofrece el personal administrativo en sus respectivas áreas.
Como producto del trabajo en equipo, el Recinto de Barranquitas establece colaboraciones que le permiten a los estudiantes presentar sus proyectos de investigación o brindar sus servicios como futuros profesionales en diversos escenarios a nivel nacional e internacional. Otros acuerdos de colaboración, a nivel internacional, le permiten participar en internados e intercambios estudiantiles en y fuera de Puerto Rico.
14
br.inter.edu
CERTIFICADOS TÉCNICOS GRADOS ASOCIADOS BACHILLERATOS MAESTRÍAS DOCTORADO
Modernas instalaciones
- Centro Multiusos: gimnasio, cancha bajo techo, cafetería y salón de juegos


- Salones tecnológicos para el ofrecimiento de clases presenciales e híbridas
- Instituto de Biotecnología Sustentable


- Bachillerato en Artes Culinarias y Ciencias Gastronómicas

- Maestrías en Enfermería (presencial y en línea)

UIPR - RECINTO DE BARRANQUITAS Apartado 517 Barranquitas, PR 00794 T. 787.857.3600
- Doctorado en Biotecnología Internacional (único en Puerto Rico) Oferta académica variada que incluye 15
CONOCE NUESTRO RECINTO

El Recinto de Bayamón es un hermoso campus enmarcado por la naturaleza tropical y cuenta con nueve edificios diseñados para albergar cursos y programas de educación superior con alta tecnología. Es un recinto enfocado en la ingeniería, la aviación, el empresarismo, la informática, las comunicaciones y las ciencias.
El recinto tiene una Escuela de Aeronáutica, una Escuela de Ingeniería y la sede del Centro de Conservación de Manatíes de Puerto Rico; ambos únicos de su clase en el Caribe. Sus proyectos de investigación en las ciencias fomentan el descubrimiento y la búsqueda de soluciones. Sus estudiantes de ingeniería y ciencias de
computadoras desarrollan importantes proyectos, desde robots con inteligencia artificial hasta microsatélites que llegarán al espacio. El recinto administra una estación de campo y reserva natural en Arecibo cuya misión es fomentar la investigación y adelantar la protección de ecosistemas de la zona cársica.
En la Inter Bayamón se puede disfrutar de una vida estudiantil inolvidable, y pertenecer al coro, taller de teatro, grupo de baile, banda o a diversas organizaciones estudiantiles que aportan a su desarrollo humano y profesional. El recinto le ofrece al estudiante la oportunidad de viajar a través de programas de intercambios.
16
bayamon.inter.edu
TÉCNICOS GRADOS ASOCIADOS BACHILLERATOS MAESTRÍAS
CERTIFICADOS





17 UIPR - RECINTO DE BAYAMÓN 500 Dr. John Will Harris Bayamón, PR 00957 T. 787.279.1912
CONOCE NUESTRO RECINTO
El Recinto de Fajardo es la principal institución universitaria en el noreste del País. El recinto es reconocido por la diversidad en la oferta académica. Brinda un acceso rápido, sin congestiones de tránsito, en un área turística de gran crecimiento en Puerto Rico. Tiene a la disposición del estudiante, programas de certificados técnicos, tales como: facturación en servicios de salud, técnico de farmacia, entrenador personal, terapeuta de masaje, barbería, cosmetología, repostería y panadería comercial y artes culinarias; grados asociados en administración de empresas, capellanía institucional, ciencias en computadoras, ciencias

policiales, contabilidad, guía turístico, justicia criminal, ciencias aplicadas en tecnología de computadoras y redes; bachilleratos en administración de empresas, educación y ciencias sociales, ciencia y tecnología y humanidades; y maestrías en educación, ciencias de computadoras y administración de empresas. También, el estudiante tiene la opción de realizar concentraciones menores dentro de su principal programa de estudio. Esto es posible gracias a una facultad altamente calificada y a un personal administrativo comprometido en ayudar al logro de las metas del estudiante.
fajardo.inter.edu
TÉCNICOS GRADOS ASOCIADOS BACHILLERATOS MAESTRÍAS 18
CERTIFICADOS






UIPR - RECINTO DE FAJARDO Call Box 70003 Fajardo, PR 00738 T. 787.863.2390 ext. 2210 Admisiones: T. 787.860.3100 BACHILLERATOS: - Delitos Cibernéticos - Mercadeo para Medios Digitales MAESTRÍA: - Ciencias de Bases de Datos - Radiología - Biología - Microbiología - Terapia del Habla y Lenguaje ¡Nuevos programas! Programas de Ciencia y Tecnología: 19
CONOCE NUESTRO RECINTO

El Recinto de Guayama es la primera institución universitaria de la región sureste de Puerto Rico. Posee un hermoso campus universitario que cumple con las expectativas de vida universitaria, las cuales son parte de las vivencias socioculturales que forman al estudiante universitario.
Como parte de la misión y metas del recinto, se aspira a formar profesionales que buscan una preparación en áreas técnicas, grados asociados, bachilleratos y maestrías. Los énfasis de la oferta académica son los siguientes: ciencias de la salud, educación, administración de empresas, ciencias naturales y tecnología, informática forense, videojuegos y aplicaciones móviles veterinaria, agronomía, humanidades, ciencias sociales y tecnología deportiva.
El recinto cuenta con un centro universitario en Humacao, que ofrece un grado asociado y un bachillerato en Ciencias Aplicadas en Enfermería, un Grado Asociado en Tecnología Radiológica, un Certificado Técnico en Facturación en Servicios de Salud y una Maestría en Enfermería con Especialidad en Médico Quirúrgico.
El Recinto de Guayama cuenta, además con el Centro Cibernético en Orlando, Florida, en donde se ofrecen programas de gran demanda para la población hispana e internacional. Inter Guayama ofrece también cursos en la modalidad presencial y a distancia.
guayama.inter.edu
GRADOS ASOCIADOS BACHILLERATOS MAESTRÍAS
CERTIFICADOS TÉCNICOS
20







UIPR - RECINTO DE GUAYAMA Call Box 10004 Guayama, PR 00785 T. 787.864.2222 787.864.8462 promocion@guayama.inter.edu
Grado Asociado en Ciencias Aplicadas en Técnico Veterinario
Bachillerato en Ciencias en Tecnología Veterinaria
-
-
Ciencia
- Bachillerato en
Animal con Pre-Veterinaria
- Bachillerato en Ciencias Agrícolas en Agronomía
únicos 21
- Maestría en Administración de Empresas con especialidad en Mercadeo Digital y Comercio Electrónico Programas
CONOCE NUESTRO RECINTO
El Recinto Metro, localizado en San Juan, desarrolla líderes y emprendedores con una formación en valores. Ofrece diversas modalidades de estudio en español e inglés en las ciencias, las artes y los estudios profesionales desde grados asociados hasta doctorales. En sus modernas instalaciones de InterTec en Hato Rey ofrece certificados técnicos y educación continuada. Los estudiantes de Inter Metro provienen de diversos transfondos culturales y nacionales con representación de mas de 40 países. Las nuevas y atractivas residencias estudiantiles proveen el mejor escenario para el disfrute de la vida en el campus.


22
metro.inter.edu
GRADOS
BACHILLERATOS
CERTIFICADOS TÉCNICOS
ASOCIADOS
MAESTRÍAS DOCTORADOS







UIPR - RECINTO METRO Apartado 191293 San Juan, PR 00919-1293 T. 787.250.1912 Admisiones: T. 787.767.1147 23
CONOCE NUESTRO RECINTO
El Recinto de Ponce cuenta con una amplia oferta académica, la cual te permite estudiar en el recinto o desde cualquier parte del mundo, dado a que ofrece la modalidad presencial o la modalidad totalmente en línea. La oferta académica incluye certificados técnicos, asociados, bachilleratos, maestrías y doctorados. Además, posee programas únicos y certificados profesionales en administración de empresas y ciencias de la salud. Los programas académicos de Tecnología Radiológica y Enfermería ostentan la acreditación profesional nacional que le permite al egresado tomar la reválida y ejercer en los Estados Unidos.

Cuenta también, con tres doctorados completamente en línea, lo que le posiciona competitivamente en un mercado nacional e internacional. Como
iniciativa estratégica, el recinto inició en octubre de 2016, en Coamo, el Instituto Coameño de Turismo y Artes Culinarias. Este es el primer centro de extensión educativa para ofrecer programas de certificados técnicos en Artes Culinarias, así como Repostería y Panadería Comercial, aprobado por la MSCHE.
La comunidad estudiantil participa activamente en diferentes competencias internacionales para exponer sus investigaciones. De igual modo, se destaca la participación en el área de empresarismo y el auspicio a estudiantes becados a participar en congresos internacionales. Fue fundado en 1962 y está localizado en un área de rápido crecimiento industrial y comercial al costado de la Autopista Luis A. Ferré. Cuenta con una estructura moderna y tecnológica que se adapta a la necesidad del estudiantado.
ponce.inter.edu
CERTIFICADOS TÉCNICOS GRADOS ASOCIADOS BACHILLERATOS MAESTRÍAS DOCTORADOS 24
Programas únicos
- Asistente del Terapista Físico
- Tecnología en Ciencias Ópticas

- Terapia Ocupacional
- Gerencia de Seguridad
- Química Aplicada: Bioquímica
Nanotecnología Química Forense

- Comunicaciones en Relaciones Públicas y Publicidad
- Gerencia e Innovación Organizacional
- Educación Especial en Autismo
- Educación Especial en Sordo y Sordo Parcial

- Asistente de Servicios
Educativos Especiales
Grado Asociado en Tecnología Radiológica

Acreditado por “Joint Review Committee on Education in Radiologic Technology” (JCERT)
Bachillerato en Enfermería
Acreditado por “Commission on Collegiate Nursing Education” (CCNE)
El programa de Educación de Maestros está acreditado por el “Council for the Accreditation of Education Preparation (CAEP)

UIPR - RECINTO DE PONCE 104 Turpeaux Ind. Park, Mercedita, PR 00715-1602
787.284.1912
T.
Acreditaciones
25
CONOCE NUESTRO RECINTO

El Recinto de San Germán provee una experiencia maravillosa dentro de un ambiente tropical inolvidable. Este “Paraíso universitario de Puerto Rico”, situado en la ciudad más antigua al suroeste de la Isla, (donde todo comenzó para la Universidad Interamericana de Puerto Rico en 1912) provee una experiencia única, en un campus histórico con más de 100 años de fundación, brindando servicios de excelencia y afirmando su compromiso con una educación de alta calidad.
Su extensión geográfica consta de 272.9 cuerdas de terreno, con 65 estructuras físicas, dentro de una localización privilegiada para visitar muchas áreas de interés cultural y turístico en el oeste.
Inter San Germán es una comunidad universitaria única, compuesta de estudiantes y facultad puertorriqueña e internacional. La vida estudiantil

es bien activa a través de las organizaciones estudiantiles acreditadas que propician un ambiente académico diferente y divertido. Dentro de sus predios están ubicadas las residencias estudiantiles, apartamentos para estudiantes internacionales y facultad visitante, así como un pequeño hotel, que apoyan la vida académica, en una belleza natural, relajante y placentera.
Ofrece grados asociados, bachilleratos, maestrías, doctorados y certificados profesionales. Ocupa actualmente el lugar 19 en el Ranking del Hamilton Global Intelligence con el programa MBA en la especialidad de Contabilidad en línea. Tiene sobre 42 programas académicos acreditados a nivel nacional y posee una diversidad de programas actualizados y a la vanguardia en la educación superior.
26 sg.inter.edu
TÉCNICOS GRADOS ASOCIADOS BACHILLERATOS MAESTRÍAS DOCTORADOS
CERTIFICADOS






27 UIPR - RECINTO DE SAN GERMÁN PO Box 5100 San Germán, P.R. 00683 T. (787) 264-1912, ext. 7730 gmatricula@sangerman.inter.edu Programas únicos Nuevos programas - Maestría en Artes Plásticas M.F.A - Doctorado en Artes Musicales en Educación Musical D.M.A. - Intervención en Pérdidas y Duelo Post Maestría - Emergencias Médicas Grado Asociado - Interpretación de Lenguage de Señas Post bachillerato - Intervención de Crisis Post bachillerato - Educación-Trastorno del Espectro Autista Post bachillerato
CONOCE NUESTRA FACULTAD
→ Nuestra Facultad
Fundada en 1961, la Facultad de Derecho es una institución educativa de excelencia en la que se imparte educación jurídica y se distingue por ofrecer un ambiente de colaboración y respeto, especialmente propicio para el aprendizaje. Destaca por cultivar un ambiente de inclusión, tanto en la educación como en la profesión jurídica, por su cuerpo estudiantil diverso y de impresionantes credenciales, un magnífico personal de apoyo comprometido con nuestra misión educativa, así como un profesorado compuesto por juristas de gran prestigio y distinción.
La comunidad académica de la Facultad de Derecho marca la pauta con su compromiso social y preparación académica rigurosa, forjando profesionales con una sólida formación y conciencia jurídica. Además de sus instalaciones de primer orden, objeto de reconocimientos y premios, cuenta con un Centro de Acceso a la Información, atendido por personal de alto calibre, con colecciones jurídicas impresas, así como bases de datos en línea, accesible a distancia. Aquí, la educación trasciende el aula, con foros y discusiones abiertas al público sobre temas a la vanguardia.
Es una comunidad que promueve el desarrollo profesional a través de experiencias formativas que impactan y cambian vidas.
→ Our School of Law
Founded in 1961, the School of Law is an educational institution of excellence that provides legal education, and it is distinguished by offering an environment of collaboration and respect, especially favorable for learning.

With an environment that fosters inclusion in legal education and the legal profession, a diverse student body with impressive credentials, a magnificent support staff committed to our educational mission, as well its faculty of highly prestigious and distinguished jurists are notable. The academic community of the School of Law sets the standard with its social commitment and rigorous academic preparation, forging professionals with a solid background and legal awareness.
In addition to its first-rate facilities, object of recognition and awards, it has an Access to Information Center staffed by high-caliber personnel, with printed legal collections, as well as online databases, accessible from a distance. Here, education transcends the classroom, with forums and discussions open to the public on cutting-edge topics. It is a community that promotes professional development through formative experiences that impact and change lives.
derecho.inter.edu
28





29 UIPR - FACULTAD DE DERECHO PO BOX 70351 San Juan, PR 00936-8351 T. 787.751.1912 ANTES DE SOLICITAR ADMISIÓN A LA FACULTAD DE DERECHO, todo candidato debe haber obtenido el grado de bachillerato o su equivalente de una institución de educación superior debidamente acreditada. → Juris Doctor → Maestría en Litigación y Métodos Alternos → Notarial y Registral Inmobiliario → Doctorado en Ciencias Jurídicas
CONOCE NUESTRA ESCUELA
→ Nuestra Escuela
La Escuela de Optometría se estableció en el 1981 para ser la institución líder en la formación de doctores en optometría bilingües (inglés/español), proveedores de cuidado primario de los ojos, reconocidos por la excelencia y el servicio comunitario para servir a Puerto Rico, los Estados Unidos y al mundo. El programa de doctorado en optometría es el único en Puerto Rico y el Caribe, y uno de los 23 programas existentes en todos los Estados Unidos.
→ Alta empleabilidad
→ Acreditaciones
Middle States Commission on Higher Education (MSCHE)
Accreditation Council on Optometric Education (ACOE)
→ Requisitos
90 créditos o más de una institución acreditada (incluye 54 créditos en cursos específicos)
2.50+ GPA
Examen de admisión (OAT/GRE)
→ Datos relevantes sobre la Escuela de Optometría:

Acreditaciones: Accreditation Council on Optometric Education (ACOE) y Middle States Commission on Higher Education (MSCHE).
Experiencia internacional: los estudiantes pueden escoger entre más de 50 localidades fuera de Puerto Rico para realizar sus rotaciones clínicas durante el cuarto año del programa de estudios.
Diversidad: sobre el 85% de los estudiantes provienen del exterior de Puerto Rico, principalmente de los Estados Unidos y Canadá.
Exclusividad: sólo 60 estudiantes son admitidos anualmente al programa.
Éxito en la reválida: sobre el 80% de la clase graduanda aprueba las tres partes del National Board Examiner in Optometry (NBEO).
Amplia oportunidad de empleo: una vez el graduado aprueba el NBEO, podrá trabajar en Puerto Rico y en cualquiera de los 50 estados de EEUU.
Practica en la clínica de cuidado primario y clínicas especializadas: pediatría, baja visión, terapia visual, prótesis y electrodiagnóstico, entre otras.
optonet.inter.edu
30





31 ESCUELA DE OPTOMETRÍA 500 Dr. John Will Harris Bayamón, PR 00957 T. 787.765.1915 ext. 1020 admissions@opto.inter.edu
EN OPTOMETRÍA: proveedores de cuidado de salud primarios, quienes diagnostican, tratan y manejan enfermedades y condiciones del sistema visual, el ojo y estructuras asociadas. → Cursos requeridos Biología Microbiología Química General Química Orgánica Bioquímica Cálculo Física Estadística Básica Psicología Inglés Humanidades Ciencias Sociales
DOCTORES
PROGRAMAS TOTALMENTE EN LÍNEA
La modalidad de estudios en línea de la UNIVERSIDAD INTERAMERICANA DE PUERTO RICO ofrece una enseñanza de la más alta calidad, así como una formación personal, profesional y académica responsable y competitiva. El modelo didáctico se basa en la interacción, la elaboración social del conocimiento y una rigurosa verificación del aprendizaje con seguimiento personalizado al estudiante.

32

33
PROGRAMAS TOTALMENTE EN LÍNEA
Programación de Computadoras
El Certificado Técnico en Programación de Computadoras ofrece al estudiante una preparación básica en la programación de las computadoras en áreas técnicas y profesionales. Incluye conocimientos generales de la organización, operación y programación de sistemas computadorizados. Este certificado provee al estudiante los conocimientos para el manejo y operación en la aplicación de sistemas para programación computadorizados de mayor demanda en la industria, el comercio y la educación, entre otros. Tiene un contenido práctico-teórico que permite al estudiante continuar estudios y desarrollarse en el campo de la programación en computadoras.

El Recinto de San Germán está autorizado para ofrecerlo mediante la modalidad de educación a distancia.
Técnico de Computadoras
El Certificado Técnico en Computadoras ofrece al estudiante una preparación básica para el uso de las computadoras en áreas técnicas y profesionales. Incluye conocimientos generales de la organización, arquitectura, operación y programación de sistemas computadorizados. Este certificado provee al estudiante los conocimientos para el manejo y operación de la computadora y el desarrollo de las destrezas para la aplicación de programas computadorizados de mayor demanda en la industria, el comercio y la educación, entre otros. El programa tiene un contenido prácticoteórico que permite al estudiante continuar estudios y desarrollarse en el campo de los sistemas de información.

El Recinto de San Germán está autorizado para ofrecerlo mediante la modalidad de educación a distancia.
Especialista en Facturación de Servicios de Salud
Este programa capacita al estudiante para realizar tareas relacionadas con la administración de la oficina médica, la codificación de diagnósticos y procedimientos, la facturación y la auditoría. El estudiante tendrá la oportunidad de utilizar la tecnología adecuada, programas y programas especializados para procesamiento de información, récord médico, facturación y contabilidad. El programa incluye un internado de práctica para reforzar los conocimientos y adquirir experiencias.
El Recinto Metropolitano está autorizado para ofrecerlo mediante la modalidad de educación a distancia.

34
Evaluación y Terapia Educativa
Técnico de Evaluación y Terapia Educativa: Los estudiantes adquirirán conocimientos en las áreas de formación del terapeuta educativo y ética en su práctica, función cerebral en relación con el aprendizaje según las neurociencias, integración sensorial y sus implicaciones educativas, elaboración del perfil psicopedagógico, técnicas informales para detectar dificultades de aprendizaje, intervención con tecnología en terapia educativa, tecnología asistida en terapia educativa, terapia educativa y estrategias de intervención, estrategias para el desarrollo de habilidades en la administración de evaluaciones formales en el proceso psicoeducativo y elaboración de un plan de intervención.
El Recinto Metropolitano está autorizado para ofrecerlo mediante la modalidad de educación a distancia.
Redes y Forense
Este programa prepara al estudiante para el manejo correcto de sistemas de computadoras, lógica y administración básica de redes. Se capacitarán para manejar, de forma básica, incidentes de seguridad e investigación forense de sistemas de redes de computadoras. Esto le permitirá laborar como asistente o entry level security and incident management para cualquier industria. El curso explora los conceptos de auditoria y base de datos lo que les permitirá generar reportes acerca de señalamientos y planes de acción correctiva en cuanto a manejo de redes de computadoras.
El Recinto Metropolitano está autorizado para ofrecerlo mediante la modalidad de educación a distancia.
Reparación y Redes
Este programa capacita al estudiante con las destrezas esenciales para desenvolverse como especialista de reparación de computadoras. Estará capacitado en las mejores prácticas sobre el uso de equipos de computadoras y redes, para reducir y resolver problemas de funcionamiento. Además, tendrá destrezas básicas de lógica de programación, instalación y mantenimiento de sistemas operativos. Finalmente, el estudiante desarrollará las destrezas básicas de reparación administración y seguridad de redes.


El Recinto Metropolitano está autorizado para ofrecerlo mediante la modalidad de educación a distancia.
Técnico en Seguridad de Redes

Este programa capacita al estudiante en destrezas esenciales para el manejo de situaciones de seguridad en las redes informáticas. Incluye conocimientos generales de los sistemas operativos utilizados en redes, la discusión sobre fallas de seguridad, ataques cibernéticos e informática forense. El estudiante podrá atender problemas relacionados con la seguridad de las redes mediante el uso de programas especializados y el desarrollo de estructuras de defensa a posibles amenazas cibernéticas.

El Recinto Metropolitano está autorizado para ofrecerlo mediante la modalidad de educación a distancia.

admisiones.inter.edu
AGU = Aguadilla ARE = Arecibo BAR = Barranquitas BAY = Bayamón INTER-CAG = Centro Universitario de Caguas-Metro
Solicita admisión aquí 35
FAJ = Fajardo GUA = Guayama HUM = Inter Humacao MET = Metro PON = Ponce SG = San Germán
Administración de Empresas (AAS)

El Grado Asociado en Administración de Empresas le ofrece al estudiante la oportunidad de desarrollar las destrezas y conocimientos básicos en el área de administración de empresas y desarrollo empresarial. El programa le brinda la oportunidad al estudiante de continuar estudios conducentes al Bachillerato en Administración de Empresas.
Cursos de interés contenidos en el currículo de estudios: Introducción a la Contabilidad Financiera, Introducción a la Contabilidad Gerencial, Fundamentos de Gerencia, Sistemas de Información en los Negocios, Fundamento Empresarial, Finanzas Corporativas, Principios de Economía (Micro), Estadística Básica, Introducción al Mercadeo, Comunicación Empresarial en Español y Comunicación Empresarial en Inglés.

Los Recintos de Aguadilla, Barranquitas, Bayamón y Ponce están autorizados para ofrecerlo mediante la modalidad de educación a distancia.
Administración de Sistemas de Oficina (AA)
El Grado Asociado en Administración de Sistemas de Oficina está diseñado para proveer al estudiante la oportunidad de desarrollar las destrezas y conocimientos fundamentales, propios de este nivel, que le capaciten para desempeñarse efectivamente como un profesional de apoyo administrativo en la administración de sistemas de oficina.
Cursos de interés contenidos en el currículo de estudios: Procesamiento de Información I, II, Producción de Documentos Empresariales, Hoja de Cálculo Electrónica, Administración de Documentos y Bases de Datos, Procesamiento de Información en Oficinas de Asuntos Legales, Procesamiento de Información en Oficinas de Servicios de Salud, el Recurso Humano en el Ambiente Organizacional, Comunicación Empresarial en Español, Comunicación Empresarial en Inglés y Administración de Oficina.

Los Recintos de Barranquitas, Metropolitano y Ponce están autorizados para ofrecerlo mediante la modalidad de educación a distancia.
Capellanía Institucional (AA)
El Grado Asociado en Artes en Capellanía Institucional aspira a desarrollar profesionales religiosos comprometidos que posean las competencias, los conocimientos, destrezas y actitudes éticas ministeriales que le capaciten para llevar a cabo intervenciones efectivas en el entorno del ambiente clínico, carcelario, educativo, laboral y eclesiástico, entre otros. Aprenderás sobre la Teoría de la Capellanía Institucional, sobre Espiritualidad, Religión y Salud Mental, Intervención y Manejo de Crisis, Intervención en Cuidado Pastoral, Psicología General, entre otros temas.
El Recinto de Fajardo está autorizado para ofrecer este programa mediante la modalidad de educación a distancia.
admisiones.inter.edu AGU = Aguadilla ARE = Arecibo BAR = Barranquitas BAY =
INTER-CAG = Centro Universitario de Caguas-Metro FAJ =
MET = Metro PON =
SG =
Bayamón
Fajardo GUA
=
Guayama HUM = Inter Humacao
Ponce
San Germán
Solicita admisión aquí
36
PROGRAMAS TOTALMENTE EN LÍNEA
Contabilidad (AAS)
Ciencias Policiales (AA)

El Grado Asociado en Artes Ciencias Policiales está diseñado para desarrollar en los estudiantes las competencias conceptuales, técnicas y afectivas necesarias para desempeñarse efectivamente como un oficial del orden público en las esferas estatal y municipal. Estudiaras cursos como Procedimiento Criminal en Sistemas de Justicia, Víctimas del Crimen, Derechos Humanos y Civiles, Desviación Social, Ética en Procesos de Prevención E Intervención Policiaca, Derecho Penal, Entrevistas e Interrogatorios, Leyes Penales Especiales, Investigación Criminal, Manejo y Tramitación de la Prueba, Psicología General I y Sistema de Justicia Criminal, entre otros.
El Recinto de Aguadilla está autorizado a ofrecer este programa mediante la modalidad de educación a distancia.
Ciencias de Computadoras (AAS)
El Grado Asociado en Ciencias de Computadoras ofrece una preparación teórica y práctica dirigida a desarrollar profesionales centrados en el dominio del conocimiento relacionado con las áreas técnicas y diversificadas de la disciplina. Propicia, además, el desarrollo de destrezas de razonamiento lógico, análisis para solución de problemas, metodologías de programación y uso de herramientas asociadas al campo de la computación.
Cursos de interés contenidos en el currículo de estudios: Desarrollo de Páginas Web, Lógica de Programación, Programación Estructurada, Programación Orientada a Objetos, Estructuras Computacionales Discretas, Bases de Datos, Computación Móvil, Estructuras de Datos, Seminario y Práctica, Programación Web con Bases de Datos y Precálculo.
El Recinto de Aguadilla y Barranquitas están autorizado para ofrecerlo mediante la modalidad de educación a distancia.
El Grado Asociado en Contabilidad ofrece al estudiante la oportunidad de desarrollar las destrezas y conocimientos fundamentales en el área de la contabilidad. Provee la preparación técnica que le permite al egresado realizar tareas básicas en el campo de la contabilidad. Este programa le brinda al estudiante la oportunidad de continuar estudios conducentes al Bachillerato.
Cursos de interés contenidos en el currículo de estudios: Introducción a la Contabilidad Financiera, Sistema Contributivo de Puerto Rico para Individuos, Introducción a Contribuciones Federales para Individuos, Contabilidad de Costos, Contabilidad Intermedia I y II, Sistemas Computadorizados Aplicados a la Contabilidad, Fundamentos de Gerencia, Finanzas Corporativas, Principios de Economía (Micro) y Estadística Básica.
Los Recintos de Aguadilla, Barranquitas, Bayamón, Guayama y Ponce están autorizados para ofrecer el programa mediante la modalidad de educación a distancia.
Estudios en Religión (AA)
El Grado Asociado en Artes en Estudios en Religión aspira a ofrecer un grado que permita la movilidad del estudiante hacia el Bachillerato en Artes en Estudios en Religión para formar facilitadores capacitados para ofrecer una instrucción ecuménica de acuerdo con las necesidades particulares de la sociedad. El Recinto Metropolitano está autorizado a ofrecer este programa de forma presencial y a distancia. Se ofrecen los cursos como: Religiones Comparadas, Introducción a la Biblia, Geografía y Arqueología Bíblicas, Historia y Teología I, II y III, Antiguo Testamento, Nuevo Testamento, Espiritualidad, Ética Cristiana, Historia y Filosofía de la Educación, Psicología del Desarrollo.
El Recinto Metropolitano está autorizado para ofrecer este programa mediante la modalidad de educación a distancia.
37
PROGRAMAS TOTALMENTE EN LÍNEA
Justicia Criminal (AA)
El Grado Asociado en Artes en Justicia Criminal aspira a preparar a los estudiantes para una carrera en Justicia Criminal dotándoles con la información necesaria para continuar su educación conducente al bachillerato. El currículo incluye investigación criminal, derecho penal, organización y administración del sistema penal, leyes constitucionales, evidencia criminal, conducta delincuente y administración de justicia. Cursos de interés concernidos en el currículo de estudios: Introducción a la Criminología, Víctimas del Crimen, Sistema de Justicia Juvenil, Derecho Penal, Introducción a las Ciencias Políticas, Psicología General I, Introducción a la Sociología, Sistema de Justicia Criminal, Derechos Humanos y Civiles, Entrevistas e Interrogatorios, Leyes Penales Especiales, Investigación Criminal y Manejo y Tramitación de la Prueba.
El Recinto de Barranquitas está autorizado a ofrecer este programa mediante la modalidad de educación a distancia.
Informática Forense (AAS)
El programa del Grado de Asociado en Ciencias Aplicadas en Informática Forense está orientado a la formación de profesionales que posean las competencias necesarias para desempeñarse en el campo de la informática forense. Este Programa está diseñado para estudiantes que interesen los campos de los sistemas informáticos forenses relacionados con el análisis forense digital y a la aplicación de técnicas de investigación sistemática para reconstruir una secuencia de eventos y realizar un análisis forense en una investigación criminal. El currículo abarca software, hardware, protección de las redes de intrusiones, seguridad, hacking, cracking, recuperación de información y decodificación de datos, entre otros. El programa busca formar egresados que puedan ser elegibles para trabajo en consultoría digital, seguridad cibernética, investigación criminal, lucha contra el terrorismo y que puedan aspirar a obtener certificaciones relacionadas con la informática forense. Los cursos de interés contenidos en el currículo del programa de estudios: Introducción Informática Forense, Seguridad de los Sistemas Operativos, Datos Digitales, Crimen Cibernético, Diseño y Arquitectura de Sistemas, Investigación Forense Dispositivos Móviles, Investigación Criminal Informática Forense, Diseño de Programas de Computadoras, Comunicación de Datos, Administración de Redes, Introducción A la Criminología y Derecho Penal.
El Recinto de Guayama está autorizado a ofrecer este programa mediante la modalidad de educación a distancia.
Ventas (AAS)
El Grado Asociado en Ventas tiene el propósito de estudiar los sistemas de ventas y sus funciones básicas dirigidas a lograr sus objetivos, contactar clientes potenciales y desarrollar presentaciones sobre ventas. El programa ayuda al estudiante a desempeñarse con eficiencia y efectividad en el mundo del trabajo.

Cursos de interés contenidos en el currículo de estudios: Introducción al Mercadeo, Conducta del Consumidor, Práctica, Seminario en Ventas, Comunicación Integrada de Mercadeo, Venta Personal, Gerencia de Ventas y Venta al Detal.
El Recinto de Ponce está autorizado para ofrecerlo mediante la modalidad de educación a distancia.
38
Administración de Empresas en Mercadeo para Medios Digitales (BBA)
Mercadeo para Medios Digitales provee una preparación práctica que propicie el desarrollo de las destrezas técnicas y las competencias que ayudan al entendimiento del papel del mercadeo en el comercio electrónico y al conocimiento de los medios digitales en este campo. Desarrolla las destrezas analíticas y las técnicas para identificar, estudiar y resolver problemas que permitan el logro de las estrategias de medios digitales.
Los cursos de interés contenidos en el currículo del programa de estudios: Fundamentos de Mercadeo para Medios Digitales, Análisis de los Medios Gráficos, Desarrollo de Herramientas Web, Estrategias de Posicionamiento en Buscadores, Mercadeo para Medios Sociales, Mercadeo para Correo Electrónico, Estrategia para Diseño de Contenido, Analítica Web, Mercadeo Inbound, Práctica en Mercadeo para Medios Digitales y Seminario en Mercadeo para Medios Digitales.

El Recinto de Fajardo está autorizado para ofrecer el programa presencial y mediante la modalidad a distancia.
Administración de Sistemas de Oficina (BA)
El Bachillerato en Administración de Sistemas de Oficina responde a la necesidad de satisfacer la demanda del mercado por profesiones de apoyo administrativo con dominio en el manejo de sistemas electrónicos, con los conocimientos, técnicas, procedimientos y destrezas requeridos para desempeñarse exitosamente en la oficina. Este programa ofrece el trasfondo cultural y los conocimientos fundamentales de la administración de oficinas que permiten al profesional de apoyo administrativo participar efectivamente en la toma de decisiones, análisis de datos, manejo y procesamiento de la información, comunicación verbal y escrita y el establecimiento de relaciones interpersonales efectivas.
Los cursos de interés contenidos en el currículo del programa de estudios: Escritura Abreviada en Español, Procesamiento de Información, Producción de Documentos Comerciales, Hoja de Cálculo Electrónica, Administración de Documentos y Bases de Datos, Procesamiento de Información en Oficinas de Asuntos Legales, Procesamiento de Información en Oficinas de Servicios de Salud, El Recurso Humano en el Ambiente Organizacional, Facturación de Servicios de Salud, Comunicación Empresarial en Español, Comunicación Empresarial en Inglés, Diseño de Arte en la Oficina, Administración de Oficina, Comunicación Empresarial Interactiva en Inglés, Integración de Programas de Aplicaciones en la Administración de Oficinas, Telecomunicaciones en la Oficina, Práctica Profesional, Diseño y Administración de Adiestramientos y Seminario Integrador.

Los Recintos de Aguadilla, Barranquitas, Metropolitano y Ponce están autorizados para ofrecerlo mediante la modalidad de educación a distancia.
Biología (BS)
El Bachillerato en Ciencias en Biología aspira a preparar profesionales capaces de comprender los procesos biológicos, con un enfoque multidisciplinario. Provee las experiencias que los ayudarán a identificar, analizar y resolver problemas de orden biológico utilizando el método científico. Propicia el desarrollo de conocimientos, destrezas de laboratorio y actitudes para ejercer la profesión con responsabilidad ética, crítica y creativa. Cursos de interés contenidos en el currículo de estudios: Biología General, Laboratorio de Destrezas de Biología, Zoología, Botánica, Bioestadísticas, Genética, Microbiología General, Anatomía y Fisiología Humana, Ecología, Biología Celular y Molecular y Laboratorio de Destrezas de Biología Celular y Molecular.
Los Recintos de Barranquitas y Fajardo están autorizados para ofrecer este programa mediante la modalidad de educación a distancia.
admisiones.inter.edu AGU = Aguadilla ARE = Arecibo BAR = Barranquitas BAY = Bayamón INTER-CAG = Centro Universitario de Caguas-Metro FAJ = Fajardo GUA = Guayama HUM = Inter Humacao MET = Metro PON = Ponce SG = San Germán Solicita admisión aquí
39
Biotecnología (BS)
El Bachillerato en Ciencias en Biotecnología aspira a desarrollar profesionales con competencias para buscar soluciones a problemas de la sociedad, aplicando los conocimientos y destrezas de la Biotecnología. El currículo incluye el desarrollo de destrezas para el manejo apropiado de las tecnologías modernas aplicadas a la vida para la producción de bienes de consumo. El egresado de este programa podrá desempeñarse en el campo de la biotecnología o el campo de la investigación. También podría aspirar a realizar estudios graduados o profesionales. Cursos de interés contenidos en el currículo de estudios: Biotecnología Molecular, Tecnología de ADN Recombinante, Cultivo de Tejido y Aplicaciones Técnicas, Biotecnología Agrícola y Ambiental, Purificación y Análisis de Proteínas, Métodos de Investigación en Biotecnología, Biología General, Laboratorio de Destrezas de Biología, Bioestadísticas, Genética, Microbiología General, Inmunología, Microbiología Industrial, Biología Celular y Molecular.
El Recinto de Barranquitas está autorizado para ofrecer el programa mediante la modalidad de educación a distancia.
Comportamiento Organizacional (BBA)
El Bachillerato en Administración de Empresas con concentración en Comportamiento Organizacional es un programa multidisciplinario que combina el conocimiento de las ciencias administrativas con el estudio del efecto del comportamiento individual y grupal en el desempeño de la organización. El propósito principal del programa es preparar profesionales capaces de administrar la organización, promover el desarrollo organizacional, comprender las dinámicas de grupo, adiestrar y preparar el recurso humano para generar cambios que ayuden a mejorar el desempeño individual y organizacional.
Los cursos de interés contenidos en el currículo del programa de estudios: Dinámicas de grupo, Métodos de investigación y sus aplicaciones en el comportamiento organizacional, Ética y la Gestión Organizacional, Desarrollo Organizacional, Seminario Integrador en Comportamiento Organizacional, Introducción A la Contabilidad Financiera, Introducción A la Contabilidad Gerencial, Fundamentos de Gerencia Empresarial, El Derecho y las Empresas, Sistemas de Información en las Organizaciones, Finanzas Corporativas, Introducción A los Negocios Internacionales, Fundamentos de Métodos Cuantitativos, Principios de Microeconomía, Principios de Macroeconomía, Estadística Básica, Estadística Gerencial, Introducción al Mercadeo, Comunicación Empresarial en Español, Comunicación Empresarial en Inglés y Gerencia de Operaciones de Manufactura y Servicio,

El Recinto de Aguadilla está autorizado para ofrecer este programa mediante la modalidad de educación a distancia.

admisiones.inter.edu AGU = Aguadilla ARE = Arecibo BAR = Barranquitas BAY = Bayamón INTER-CAG = Centro Universitario de Caguas-Metro FAJ = Fajardo GUA = Guayama HUM = Inter Humacao MET = Metro PON = Ponce SG =
Solicita
San Germán
admisión aquí
40
PROGRAMAS TOTALMENTE EN LÍNEA
Ciencias Agrícolas en Agronomía (BS)
El programa de Bachillerato en Ciencias Agrícolas en Agronomía aspira a formar profesionales en el sector agrícola particularmente en las áreas de cultivos, producción animal y empresarismo. El diseño curricular de este programa incluye cursos teóricos y prácticos. Además, en el marco conceptual del currículo se integran elementos tales como empresarismo, investigación y tecnología. Se espera que el egresado de este programa pueda adquirir conocimientos teóricos y prácticos que le permitan trabajar en las áreas de calidad, la producción e innovación agropecuaria y en la conservación del medio ambiente.
El enfoque de la misión y filosofía del currículo propuesto enmarcan una visión del egresado con una educación teórica y práctica que lo capacite para desempeñarse exitosamente tanto a nivel profesional como personal. El programa de Bachillerato en Ciencias Agrícolas en Agronomía tiene como meta educativa preparar un egresado con los conocimientos, las destrezas y las actitudes que lo capaciten para emplearse, generar agronegocios y al mismo tiempo ofrecer un buen servicio a la sociedad. Se pretende formar un profesional educado y competente, responsable y respetuoso para consigo mismo, su profesión y la sociedad. Cursos de interés contenidos en el currículo de estudios: Botánica y Fisiología Vegetal, Edafología, Fitopatología, Bienestar Animal, Salud y Seguridad Agrícola, Producción de Cultivo I, II, Nuevas Tendencias Agrícolas, Alimentación y Nutrición Animal, Producción Animal I, II, Residuos Agropecuarios, Empresarismo Agrícola, Práctica en Agropecuaria, Biotecnología Agropecuaria, Maquinaria y Mecanización Agrícola, Química Aplicada a la Ciencias Agrícolas, Gerencia de Agronegocios, Retos ante el Cambio Climático, de Suelo y Agua, Manejo de Pastos y Forrajes, Diseño y Evaluación de Proyectos, Mercadeo Agrícola, Investigación en Ciencias Agrícolas, Práctica en Ciencias Agrícolas y Física General y sus Aplicaciones.
El Recinto de Guayama está autorizado a ofrecer este programa mediante la modalidad de educación a distancia.
Ciencias de Computadoras (BS)
El programa ofrece una preparación teórica y práctica dirigida a desarrollar profesionales centrados en el dominio del conocimiento relacionado con las áreas técnicas y diversificadas de la disciplina. Propicia, además, el desarrollo de destrezas de razonamiento lógico, análisis para solución de problemas, metodologías de programación y uso de herramientas asociadas al campo de la computación.
Los cursos de interés contenidos en el currículo del programa de estudios: Desarrollo de Páginas Web, Lógica de Programación, Programación Estructurada, Programación Orientada a Objetos, Estructuras Computacionales Discretas, Bases de Datos, Estructuras de Datos, Programación Web con Bases de Datos, Organización y Arquitectura de Computadoras, Ingeniería de “Software”, Sistemas Operativos, Computación Visual, Teleprocesamiento y Redes, Desarrollo e Implementación de Sistemas, Seguridad Computacional, Práctica y Ética Profesional, Precálculo, Cálculo y Física General.
El Recinto de Aguadilla está autorizado para ofrecer este programa mediante la modalidad de educación a distancia.

41
PROGRAMAS TOTALMENTE EN LÍNEA
Ciencias de la Salud en Administración (BS)
El programa está diseñado para promover el desarrollo de un profesional de la salud sensible y que demuestra el conocimiento y destrezas para ofrecer servicios de salud de calidad. Estos conocimientos están fundamentados en conceptos y principios de las ciencias naturales, las ciencias sociales y las ciencias de la salud. El estudiante puede optar por una subespecialidad en administración o en educación, lo que le permitirá ocupar puestos de mayor rango y de liderato en su trabajo.
Cursos de interés contenidos en el currículo de estudios: Desarrollo Humano, Conceptos Esenciales en Ciencias de la Salud, Salud y Enfermedad a través del Ciclo de Vida, Métodos de Investigación en Ciencias de la Salud, Garantía y Mejoramiento de Calidad, Promoción de la Salud Colectiva, Psicología General y Métodos Estadísticos.

Administración: Cursos de interés contenidos en el currículo de estudios: Planificación y Mercadeo de Servicios de Salud, Principios de Auditoría aplicados a los Servicios de Salud, Internado, Fundamentos de Gerencia y Supervisión.

El Recinto de Ponce está autorizado a ofrecer este programa mediante la modalidad de educación a distancia.
Contabilidad (BBA)
El Bachillerato en Administración de Empresas en Contabilidad aspira a desarrollar un profesional en el campo de la Contabilidad que sea exitoso en el desempeño de sus funciones en el sector privado y público.
Los cursos de interés contenidos en el currículo del programa de estudios: Sistema Contributivo de Puerto Rico para Individuos, Contabilidad de Costos, Contabilidad Intermedia, Introducción a Contribuciones Federales para Individuos, Computadorizados Aplicados a la Contabilidad, Contabilidad para Organizaciones sin Fines de Lucro y Auditoría y Ética del Contador.
Los Recintos de Barranquitas, Guayama y Ponce están autorizado para ofrecer el programa mediante modalidad de educación a distancia.
42
Desarrollo Empresarial y Gerencial (BBA)

El programa de Desarrollo Empresarial y Gerencial está diseñado para proveer al estudiante conocimientos de los principios que rigen el desarrollo de empresa y las actividades comerciales de esta. El programa del Bachillerato en Administración de Empresas con concentración en Desarrollo Empresarial y Gerencial pretende preparar a un profesional con las destrezas y conocimientos necesarios para explorar el auto-empleo como alternativa viable en su carrera profesional o desempeñarse en una empresa como gerente. Se expone al estudiante a los conceptos, principios y prácticas fundamentales de las distintas disciplinas que abarcan el desarrollo y la administración de empresa y empresarismo, tales como: gerencia, empresarismo, contabilidad, mercadeo, economía, finanzas, métodos cuantitativos y de recursos humanos.
Los cursos de interés contenidos en el currículo del programa de estudios: Comportamiento Humano en las Organizaciones, Derecho Mercantil, Administración de Recursos Humanos, Legislación Protectora del Trabajo, Gerencia de Operaciones, Fundamento Empresarial, Estrategias Empresariales y Gerenciales, Empresas de Familia, Diseño y Desarrollo de un Plan de Negocios, Práctica Empresarial y Gerencial o Proyecto Empresarial o Gerencial.

Los Recintos de Barranquitas, Bayamón y el Centro Universitario en Caguas están autorizados para ofrecer el programa mediante la modalidad de educación a distancia.
EDUCACIÓN
El programa está dirigido a la formación de maestros dentro de un plan de estudio que provea un cúmulo de experiencias articuladas y que, a su vez, promueva espacios para la construcción de los conocimientos pedagógicos y de contenido que desarrollará el futuro docente. Estas experiencias se caracterizarán por la reflexión continua, la práctica en escenarios reales, la investigación, la colaboración, la pertinencia de los contenidos, el modelaje pedagógico y la búsqueda y uso de medios que permitan dar soluciones a problemas propios de los procesos de enseñanza y de aprendizaje en diferentes contextos. En este plan de estudio estarán integrados los componentes de educación general, medular y concentración.

Educación Especial (BA)
Los cursos de interés contenidos en el currículo de estudios: Naturaleza y Necesidades de los Estudiantes con Discapacidad Intelectual y Trastornos Mentales, Naturaleza y Necesidades de los Estudiantes con Problemas Específicos de Aprendizaje, Trastorno de Déficit de Atención y Trastorno de Déficit de Atención e Hiperactividad, Lenguaje y Lectura, Diagnóstico Educativo, Evaluación, y “Assessment” para Estudiantes con Limitaciones, Manejo de la Conducta en la Sala de Clases, Contenido Curricular, Diagnóstico y Tratamiento de Problemas de Aprendizaje en las Matemáticas, Contenido Curricular, Diagnóstico y Tratamiento de Problemas de Lectoescritura, Asistencia Tecnológica, Currículo y Materiales para la Enseñanza del Estudiante con Limitaciones Leves y Estrategias, Métodos y Técnicas de Enseñanza para Estudiantes con Limitaciones El Recinto de Arecibo y el Centro Universitario en Caguas del Recinto Metropolitano están autorizados para ofrecer este programa mediante la modalidad de educación a distancia.
admisiones.inter.edu AGU = Aguadilla ARE = Arecibo BAR = Barranquitas BAY = Bayamón INTER-CAG = Centro Universitario de Caguas-Metro FAJ = Fajardo GUA = Guayama HUM = Inter Humacao MET = Metro PON = Ponce SG = San Germán Solicita admisión aquí
43
Educación en Niñez Temprana: Nivel Elemental (4-6) (BA)
Los cursos de interés contenidos en el currículo de estudios: Salud, Nutrición y Primeros Auxilios, Currículo, Enseñanza y “Assessment” de las Matemáticas en el Nivel Elemental (4-6), Currículo, Enseñanza y “Assessment” de los Estudios Sociales en el Nivel Elemental (4-6), Literatura Infantil, Las Bellas Artes en el Proceso Educativo, Los Padres y las Madres como Educadores, Currículo, Enseñanza y “Assessment” del Inglés en el Nivel Elemental (4-6), Currículo, Enseñanza y “Assessment” de las Artes del Lenguaje en el Nivel Elemental (4-6), Currículo, Enseñanza y “Assessment” de las Ciencias Naturales en el Nivel Elemental (4-6) y El Juego del Niño como Proceso Educativo.
El Recinto de Arecibo está autorizado para ofrecer este programa mediante la modalidad de educación a distancia.
Educación en Niñez Temprana: Nivel Elemental Primario (K-3) (BA)
Los cursos de interés contenidos en el currículo de estudios: Salud, Nutrición y Primeros Auxilios, Currículo, Enseñanza y “Assessment” de las Matemáticas en los Grados Primarios (K-3), Currículo, Enseñanza y “Assessment” de los Estudios Sociales en los Grados Primarios (K-3), Literatura Infantil 3, Las Bellas Artes en el Proceso Educativo, El Kindergarten en el Programa Escolar, Los Padres y las Madres como Educadores, Currículo, Enseñanza y “Assessment” del Inglés en los Grados Primarios (K-3), Lecto-escritura en los Grados Primarios, Currículo, Enseñanza y “Assessment” de las Ciencias Naturales en los Grados Primarios (K-3) y El Juego del Niño como Proceso de Aprendizaje.
El Recinto de Arecibo está autorizado para ofrecer este programa mediante la modalidad de educación a distancia.
Educación en la Niñez Temprana: Nivel Preescolar (BA)
Los cursos de interés contenidos en el currículo de estudios: Salud, Nutrición y Primeros Auxilios, Estimulación del Lenguaje, Naturaleza y Necesidades de los Infantes y Niños de Edad Preescolar con Deficiencias en el Desarrollo, Literatura Infantil, Influencias Psicofilosóficas en los Modelos Curriculares para la Educación Temprana, Las Bellas Artes en el Proceso Educativo, Los Padres y las Madres como Educadores, Organización y Administración de Servicios a la Niñez y El Juego del Niño como Proceso de Aprendizaje.
El Recinto de Arecibo y el Centro Universitario en Caguas del Recinto Metropolitano están autorizados para ofrecer el programa mediante la modalidad de educación a distancia.
Enseñanza de Inglés como Segundo Idioma en el Nivel Secundario (BA)
El programa está diseñado con el objetivo de proveer la base teórica y el adiestramiento práctico a los futuros maestros de inglés de la escuela secundaria. Esto implica conocimiento de la teoría, metodología y aplicación de diseño curricular, el diseño de materiales del inglés como segundo idioma, la teoría y aplicación de la lingüística, la adquisición del inglés como segundo idioma, la fonética estadounidense y las cuatro artes del lenguaje, el análisis comparativo del inglés y el español, la evaluación y el “Assessment” en el salón de clases, el conocimiento de la literatura para adolescentes en inglés, el conocimiento de la literatura infantil en inglés y la base sólida en la redacción, comunicación oral, gramática y los géneros literarios en inglés.
Los cursos de interés contenidos en el currículo de estudios: Redacción Avanzada, Introducción a la Lingüística, Discurso Público, Estructuras Fundamentales de la Gramática, Fundamentos de la Fonética, Análisis Comparativo del Inglés y el Español, Análisis de los Géneros Literarios, Literatura para Jóvenes Adultos, Adquisición del Inglés como Segundo Idioma y Currículo, Enseñanza y “Assessment” del Inglés en el Nivel Secundario (7-12).
El Recinto de Arecibo está autorizado para ofrecer el programa mediante la modalidad de educación a distancia.

admisiones.inter.edu AGU = Aguadilla ARE = Arecibo BAR = Barranquitas BAY = Bayamón INTER-CAG = Centro Universitario de Caguas-Metro FAJ = Fajardo GUA = Guayama HUM = Inter Humacao MET = Metro PON = Ponce SG = San Germán
Solicita admisión
aquí
44
PROGRAMAS TOTALMENTE EN LÍNEA
Educación Secundaria en Español (BA)
Educación en Salud Escolar (BA)
El Bachillerato está diseñado para ofrecer a los alumnos conocimientos en la enseñanza de la salud, proporcionándoles un trasfondo de las teorías y los métodos educativos en los respectivos niveles, conceptos y principios de las ciencias naturales, sociales y de las humanidades. Dirige al futuro maestro al desarrollo de una mejor calidad de vida, concienciándolos sobre la importancia de la salud y del equilibrio físico, mental y social del ser humano en su interacción constante con su entorno. Provee inmersión temprana a la sala de clases.
Los cursos de interés contenidos en el currículo de estudios: Experiencias de Movimiento I, II y III, Fundamentos de la Educación Física y la Tecnología Deportiva, Prevención y Seguridad Personal para Niños, Jóvenes y Adultos, Kinesiología y Anatomía Funcional, Destrezas Fundamentales y Entrenamiento en los Deportes de Conjunto, Aprendizaje Motor y Análisis del Movimiento, Destrezas Fundamentales y Entrenamiento en los Deportes Individuales, Salud Personal, Colectiva y Seguridad, Gerencia de Programas de Educación Física, Bienestar, Salud y Deportes, Fisiología del Movimiento Humano y la Enseñanza de la Educación Física para Poblaciones Especiales.

El Recinto de Arecibo está autorizado para ofrecer este programa mediante la modalidad de educación a distancia.
El Bachillerato en Educación Secundaria en Español contiene como cursos de interés en currículo de estudios: Experiencias de Campo en el Escenario Educativo I y II, Historia y Filosofía de la Educación, Sociedad y Educación, Psicología del Desarrollo, Psicología del Aprendizaje, Uso de la Tecnología en la Educación, Población Estudiantil Excepcional, Estrategias de Enseñanza, Experiencias Clínicas en el Escenario Educativo, Evaluación y “Assessment”, Investigación en el Salón de Clases, Diseño de Currículo, Integración de Conocimientos Fundamentales y Competencias de la Comunicación, Integración de Competencias Profesionales, Proceso Histórico de los Estados Unidos de América, Gramática Superior, Lingüística, Taller de Redacción, Literatura Española, Literatura Hispanoamericana, Literatura Puertorriqueña, Taller de Lectura y Metodología y Técnicas de Enseñanza de la Lengua Materna. El Recinto de Arecibo está autorizado para ofrecer el programa mediante la modalidad de educación a distancia.
45
PROGRAMAS TOTALMENTE EN LÍNEA
Diseño Gráfico Digital y Multimedios (BS)
El Bachillerato en Ciencias en Diseño Gráfico Digital y Multimedios provee al estudiante los principios, conceptos y prácticas de la industria de la publicidad y de las comunicaciones. Se fundamenta en el desarrollo de profesionales de la comunicación visual dirigida a manejar nuevas formas de ofrecer servicios, planificar, diseñar y comunicar ideas y mensajes gráficos claros y efectivos.
Cursos de interés contenidos en el currículo de estudios: Historia del Diseño Gráfico, Fundamentos del Diseño Gráfico, Análisis de los Medios Gráficos, Fotografía Digital Aplicada al Diseño Gráfico, Diseño Gráfico Digital, Diseño y Composición Tipográfica Gráfica y Digital, Introducción al Diseño de Multimedios, Semiótica y la Comunicación Gráfica, Redacción para el Formato Digital y Producción de Vídeos, Diseño de Identidad Corporativa e Identidad Visual, Diseño de Empaques y Exhibidores, Principios de Animación, Diseño y Producción de Multimedios, Diseño y Producción Multimedios, Principios Éticos y Legales de la Comunicación Gráfica, Administración y Mercadeo de Medios Gráficos, Seminario Profesional, Diseño y Producción de Portafolio Profesional Digital, Seminario Campaña Publicitaria, Diseño Editorial, Animación y Gráfica Tridimensional (3D) y Práctica.
El Recinto de Aguadilla está autorizado a ofrecer este programa mediante la modalidad de educación a distancia.
Enfermería (BSN)
El programa de Enfermería tiene como misión formar enfermeras y enfermeros capaces de ofrecer cuidado competente, sensible, efectivo, seguro y de calidad al cliente persona, familia y comunidad. El estudiante aprenderá fundamentos de enfermería, del cuidado del adulto, del cuidado materno-neonatal, del cuidado pediátrico, entre otros. Cursos de interés contenidos en el currículo de estudios: Fundamentos de Enfermería, Práctica de Fundamentos de Enfermería, Aspectos Farmacológicos, Fundamentos en el Cuidado del Adulto, Práctica Adulto, Fundamentos en el Cuidado MaternoNeonatal, Práctica en el Cuidado Materno-Neonatal, Fundamentos de Cuidado Pediátrico, Práctica en el Cuidado Pediátrico, Fundamentos en el Cuidado Sicosocial, Práctica Sicosocial y Seminario de Transición, Dimensiones de la Práctica Profesional, Introducción al Proceso de Investigación en Enfermería, Estimado de Salud, Intervención en Transiciones Sicosociales, Intervenciones Profesionales en el Ciclo de Vida, Cuidado de Enfermería a la Familia y Comunidad, Práctica en Intervenciones Profesionales en el Ciclo de Vida, Práctica en Cuidado de Enfermería a la Familia y la Comunidad y Taller Integrador.
46
El Recinto de Barranquitas está autorizado para ofrecer el programa mediante la modalidad de educación a distancia.
Estudios en Religión (BA)
El programa está diseñado para demostrar conocimiento y comprensión del trasfondo cultural, político, económico y social del mundo bíblico, los aspectos básicos de la arqueología bíblica y su relación con la formación de los escritos bíblicos, el trasfondo histórico del desarrollo del misticismo cristiano y sus diversas manifestaciones, los conceptos básicos de la teología y las ideas que sustentan el pensar religioso.
Los cursos de interés contenidos en el currículo del programa de estudios: Religiones Comparadas, Introducción a la Biblia, Geografía y Arqueología Bíblicas, Historia y Teología, Antiguo Testamento, Nuevo Testamento, Espiritualidad, Ética Cristiana, Organizaciones Religiosas, la Religión en Latinoamérica, Educación Cristiana, Análisis del Discurso Religioso, Currículo de Educación Cristiana, Filosofía de la Religión, Historia y Filosofía de la Educación y Psicología del Desarrollo.
El Recinto Metropolitano está autorizado para ofrecer este programa mediante la modalidad de educación a distancia.
Finanzas (BBA)





















El programa de estudios en esta concentración adiestra al estudiante a usar los instrumentos de análisis en la solución de problemas y en la formulación de decisiones en el campo de las finanzas, tales como finanzas corporativas, banca e inversiones. Además, el programa ofrece la oportunidad de explorar las áreas de hacienda pública, seguros y bienes raíces. Cursos de interés contenidos en el currículo de estudios: Finanza Gerencial Avanzada, Principios de Inversiones, Mercado de Valores, Introducción al Riesgo y al Seguro, Finanza Internacional, Seminario en Finanzas, Moneda y Banca y Finanza Pública y Política Fiscal.

El Recinto de Ponce está autorizado a ofrecer este programa mediante la modalidad de educación a distancia.
Gerencia de Hoteles y Restaurantes (BBA)
El programa aspira a desarrollar en el estudiante las competencias en el manejo de empresas gastronómicas y hoteleras que promuevan una operación eficiente, productiva y ética en las siguientes áreas: administración de recursos humanos, servicios a los clientes, tarifas, publicidad, servicios de alimentos y bebidas, manejo de presupuesto y mantenimiento de instalaciones físicas.
Cursos de interés contenidos en el currículo de estudios: Las Leyes y el Turismo, Introducción a la Industria del Turismo y la Hospitalidad, Introducción a la Gerencia de Alimentos y Bebidas, Laboratorio de Producción y Servicio de Alimentos Básicos, Destrezas de Comunicación Profesional en Inglés para Hospitalidad y Turismo, Introducción al Mercadeo en la Industria de la Hospitalidad, Laboratorio de Producción y Servicio de Alimentos Avanzado, Gerencia de Recursos Humanos en la Industria de la Hospitalidad, Gerencia y Servicio de Bebidas, Desarrollo y Gerencia de Restaurantes, Departamento de Recepción, Administración de Instalaciones Físicas, Gerencia Financiera para Empresas Hoteleras, Gerencia de Casinos, Tecnología y Sistemas de Información en la Industria de la Hospitalidad, Administración de Reuniones y Convenciones e Internado en Gerencia de Hoteles.
El Recinto de Aguadilla está autorizado a ofrecer este programa mediante la modalidad de educación a distancia
admisiones.inter.edu AGU = Aguadilla ARE = Arecibo BAR = Barranquitas BAY = Bayamón INTER-CAG = Centro Universitario de Caguas-Metro FAJ = Fajardo GUA = Guayama HUM = Inter Humacao MET = Metro PON = Ponce SG = San Germán Solicita admisión aquí
47
Gerencia e Innovación Oganizacional (BBA)
El programa de estudios para la concentración en Gerencia e Innovación Organizacional está diseñado para proveer al estudiante los principios, conceptos y aplicaciones de esta disciplina. El objetivo del programa es el desarrollo de competencias gerenciales, dirigidas a la transformación organizacional.
Los cursos de interés contenidos en el currículo del programa de estudios: Comportamiento Humano en las Organizaciones, Derecho Mercantil, Administración de Recursos Humanos, Ciencias Gerenciales, Fundamento Empresarial, Estrategias Empresariales y Gerenciales, Diseño Organizacional, Comunicación Organizacional, Ética y Responsabilidad Social, Liderazgo y Cambio, Innovación y Creatividad y Simulación Gerencial.
El Recinto de Ponce está autorizado a ofrecer este programa mediante la modalidad de educación a distancia.
Gerencia de Operaciones de Manufactura y Servicio (BBA)
La Gerencia de Operaciones es un área de impacto significativo en la operación de las organizaciones. El objetivo de este programa es proveer al estudiante los conocimientos relacionados con la utilización efectiva de los factores de producción en actividades manufactureras y de servicios.
Los cursos de interés contenidos en el currículo del programa de estudios: Gerencia de Transportación, Política y Estrategia Gerenciales, Ciencias Gerenciales, Gerencia de Operaciones, Gerencia de Compra y de Materiales, Fundamento Empresarial y Seguridad Industrial y Salud (Bienestar) Ocupacional.
El Recinto de Ponce está autorizado para ofrecer el programa mediante la modalidad de educación a distancia.
Gerencia de Recursos Humanos (BBA)
La Gerencia de Recursos Humanos es una disciplina de gran importancia en la planificación estratégica de las organizaciones. El propósito fundamental del programa es proveer a los estudiantes los conocimientos, las destrezas, las habilidades sobre los principios, las prácticas y los procesos de la administración estratégica de los recursos humanos. El programa destaca la importancia de la integración de los objetivos de la gerencia de los recursos humanos con los objetivos de la organización y fomenta las actitudes que debe poseer el profesional en este campo.
Los cursos de interés contenidos en el currículo del programa de estudios: Comportamiento Humano en las Organizaciones, Administración de Recursos Humanos, Supervisión, Seguridad e Higiene en el Ambiente de Trabajo, Capacitación y Desarrollo de los Recursos Humanos, Legislación Protectora del Trabajo, Sindicación y Negociación Colectiva, Administración de Compensaciones y Seminario Integrador en Recursos Humanos.
Los Recintos de Aguadilla, Barranquitas y Ponce están autorizados para ofrecer el programa mediante la modalidad de educación a distancia.

admisiones.inter.edu AGU = Aguadilla ARE = Arecibo BAR = Barranquitas BAY = Bayamón INTER-CAG = Centro Universitario de Caguas-Metro FAJ = Fajardo GUA = Guayama HUM = Inter Humacao MET = Metro PON = Ponce SG = San Germán Solicita
admisión aquí
48
PROGRAMAS TOTALMENTE EN LÍNEA
Justicia Criminal con concentración en Investigación Criminal (BA)
El Bachillerato en Justicia Criminal con concentración en Investigación Criminal contiene un currículo moderno que atempera los conocimientos, teorías y técnicas en el campo de la justicia criminal con las exigencias de una sociedad cambiante. El currículo es de naturaleza interdisciplinaria en ramas de conocimiento relacionadas con la conducta humana. Este programa permite al estudiante adquirir una capacidad personal y profesional conforme con sus intereses y aptitudes. Se da importancia al desarrollo adecuado de actitudes y características de la personalidad del estudiante, además de subrayar el conocimiento de las causas del crimen, la proyección del crimen, los métodos y técnicas modernas de justicia criminal.
Los cursos de interés contenidos en el currículo del programa de estudios: Derechos Humanos y Civiles, Entrevistas e Interrogatorios, Leyes Penales Especiales, Investigación Criminal, Tecnología Moderna en la Investigación Criminal, Manejo y Tramitación de la Prueba y Detección y Manejo de Fraude.
Los Recintos de Aguadilla, Barranquitas y Ponce están autorizados para ofrecer este programa mediante la modalidad de educación a distancia.
Gerencia de Seguridad (BS)
El Bachillerato en Ciencias en Gerencia de Seguridad es un programa interdisciplinario que aspira a desarrollar profesionales, administradores, gerentes, dueños de empresas y futuros empresarios en este campo. Enfatiza el desarrollo y la implantación de herramientas, estrategias y programas de seguridad que respondan a los cambios en contextos físicos y virtuales. El programa resalta aspectos contemporáneos relacionados con la seguridad ocupacional, escalamientos, robo de identidad e información y ataques cibernéticos.
Los cursos de interés contenidos en el currículo del programa de estudios: Fundamentos de Seguridad, Crímenes Cibernéticos, Seguridad en la Web y Redes Inalámbricas, Tecnología de Sistemas de Seguridad, Política y Administración de Tecnología de Seguridad, Auditoria y Seguridad, Recuperación y Continuidad de Desastres, Aspectos Legales de la Seguridad, Ingeniería Social y Hacker Ético y Seminario Integrador.

El Recinto de Ponce está autorizado para ofrecer el programa mediante la modalidad de educación a distancia.
Justicia Criminal con concentración en Investigación Forense (BA)
Cursos de interés contenidos en el currículo de estudios: Derechos Humanos y Civiles, Comunicación Oral y Escrita para la Investigación Forense, Leyes Penales Especiales, Investigación Forense, Temas Especiales y Análisis de Datos para Investigación Forense.
Los Recintos de Aguadilla y Barranquitas están autorizado para ofrecer el programa mediante la modalidad de educación a distancia.
49
PROGRAMAS TOTALMENTE EN LÍNEA
Matemáticas (BA)
El programa de estudios del Bachillerato en Matemáticas provee al estudiante las oportunidades necesarias para adquirir las destrezas, el conocimiento de los conceptos fundamentales, el dominio de los procesos matemáticos y el fortalecimiento de los valores éticos que lo preparen para seguir una carrera en matemáticas relacionada con la enseñanza a nivel de escuela secundaria o en cualquier otra en la que se requieran destrezas analíticas. De igual forma, los prepara para seguir estudios graduados. Este programa permite a los estudiantes adquirir dominio de las competencias en álgebra, análisis y matemática aplicada y aspira a incorporar diversos métodos innovadores en el currículo que respondan a las necesidades y a los intereses del estudiante de manera individual.
Los cursos de interés contenidos en el currículo del programa de estudios: Precálculo, Métodos Discretos, Calculo, El Lenguaje de las Matemáticas, Temas de Geometría, Teoría de Números, Álgebra Lineal, Álgebra Aplicada, Algebra Abstracta, Física General, Estadística, Lógica de Programación, Técnicas de Muestreo, Estadísticas No Paramétricas, Estadística Matemática, Ecuaciones Diferenciales, Análisis Numérico, Investigación Operativa, Seminario para Maestros de Escuela Secundaria y Cálculo Avanzado.
El Recinto Metropolitano está autorizado para ofrecer el programa mediante la modalidad de educación a distancia.
Mercadeo (BBA)
Mercadeo es una de las áreas funcionales de mayor importancia en la administración de una empresa. Consiste en una variedad de actividades encaminadas a suplir bienes y servicios a consumidores, ya sean estos personas o empresas. También, es el eslabón que conecta la acción de producir con la de consumir por lo que tiene efectos significativos sobre la naturaleza y niveles de empleo; canales y medios de comunicación; distribución y grados de satisfacción social e individual.
Los cursos de interés contenidos en el currículo del programa de estudios: Gerencia de Mercadeo, Conducta del Consumidor, Comunicación Integrada de Mercadeo, Mercadeo Estratégico Contemporáneo, Investigación de Mercadeo, Mercadeo Global y Mercadeo Electrónico.
Los Recintos de Aguadilla y Ponce están autorizados para ofrecer el programa mediante la modalidad de educación a distancia.

50
Psicología (BA)
El Bachillerato en Psicología está diseñado para proveer al estudiante los conocimientos y destrezas básicas que necesita para iniciarse en el estudio de la psicología. El currículo tiene un énfasis particular en desarrollar en el estudiante la capacidad de juicio crítico y valores éticos profesionales. Además, la adquisición de destrezas de investigación científica, de diversidad cultural y de manejo a nivel intrapersonal e interpersonal.

Los cursos de interés contenidos en el currículo del programa de estudios: Psicología General, Redacción en la Psicología, Psicología del Desarrollo, Métodos Estadísticos, Aprendizaje, Psicología Fisiológica, Psicología Social, Fundamentos de Entrevistas Psicológicas, Psicología Comunitaria, Principios de la Medición Psicológica, Psicopatología, Psicología de la Personalidad, Psicología Experimental, Antropología Social, Fundamentos de la Biología y Seminario Integrador.






Los Recintos de Aguadilla, Ponce y el Centro Universitario de Caguas están autorizados para ofrecer el programa mediante la modalidad de educación a distancia.
Negocios Internacionales (BBA)
El programa de Negocios Internacionales está diseñado para ofrecer a los estudiantes conocimientos necesarios para ejecutar las funciones básicas gerenciales dentro de un marco conceptual de dimensiones internacionales. Las actividades académicas teóricas y prácticas preparan a los estudiantes en la búsqueda de alternativas para promover el comercio internacional dentro de una perspectiva global.
Los cursos de interés contenidos en el currículo del programa de estudios: Introducción a los Negocios Internacionales, Conciencia Cultural en los Negocios Internacionales, Conceptos Básicos de Importación y Exportación de Productos, Licencias y Regulaciones para Importación y Exportación de Productos, Gerencia de Recursos Humanos Internacional, Ambiente de los Negocios Internacionales en las Américas, Europa y el Pacífico, Contrato de Venta Internacional y los Términos de Comercio Internacional, Instituciones Financieras e Inversiones Internacionales, la Administración del Transporte Internacional: Marítimo, Aéreo y Terrestre, Sistemas de Información, Gerencia Internacional, Estrategia de Negocios Internacionales, Práctica en los Negocios Internacionales y Economía Internacional.


El Recinto Metropolitano está autorizado para ofrecer el programa mediante la modalidad de educación a distancia.

admisiones.inter.edu AGU = Aguadilla ARE = Arecibo BAR = Barranquitas BAY = Bayamón INTER-CAG = Centro Universitario de Caguas-Metro FAJ = Fajardo GUA = Guayama HUM = Inter Humacao MET = Metro PON = Ponce SG = San Germán Solicita admisión aquí
51
Redes y Telecomunicaciones (BS)

El programa de Redes y Telecomunicaciones ofrece los más avanzados cursos en el campo de las redes de datos, telecomunicaciones, ambientes de recursos computadorizados compartidos mediante redes corporativas y administración de dichos sistemas basados en las plataformas Windows, Netware, Linux, IBM iSeries y Cisco, entre otros. Cursos de interés contenidos en el currículo de estudios: Introducción a las Redes y Telecomunicaciones, Protocolos de Redes, Diseño de Distribución de Telecomunicaciones, Redes Linux, Instalación y Administración de Sistemas de Redes, Introducción a la Programación en JAVA, Servidor de Correo Electrónico, Operaciones de Minicomputadoras, Administración y Programación de Internet, Servidor de Bases de Datos SQL, Redes Inalámbricas, Temas Especiales en Telecomunicaciones, Seguridad en las Redes, Auditoría y Controles en Sistemas de Redes, Redes de Voz y Vídeo, Redes de Almacenamiento, Administración de Redes, Práctica en Telecomunicaciones, Introducción a la Contabilidad Financiera, Fundamentos de Gerencia, Introducción a la Tecnología de la Información, Algoritmos de Programación, Fundamentos de Métodos Cuantitativos e Introducción al Mercadeo.




El Recinto de Ponce está autorizado a ofrecer este programa mediante la modalidad de educación a distancia.

Tecnología de la Información (BBA)




El Bachillerato en Tecnología de la Información provee una preparación práctica para los profesionales en las áreas tecnológicas de la información.

El programa ha sido diseñado para propiciar un entendimiento cabal de las metas, funciones y operaciones de las organizaciones empresariales y de las necesidades de información y el papel de la tecnología de la información en dichas organizaciones. Además, provee para el desarrollo de las destrezas analíticas y técnicas para identificar, estudiar y resolver problemas de manejo de información y las destrezas de comunicación que permitan una interacción efectiva con otros miembros de una organización empresarial.
Los cursos de interés contenidos en el currículo del programa de estudios: Introducción a la Tecnología de la Información, Algoritmos de Programación, Programación Visual en Sistemas de Información, Desarrollo de Página Web, Programación de Aplicaciones Móviles, Diseño y Manejo de Bases de Datos, Telecomunicaciones y Redes en los Negocios, Análisis y Diseño de Sistemas de Información, Programación de Internet, Auditoría y Seguridad de los Sistemas de Información, Práctica o Proyecto y Seminario en Sistemas de Información.




El Recinto de Aguadilla está autorizado para ofrecer este programa mediante la modalidad de educación a distancia.

admisiones.inter.edu AGU = Aguadilla ARE = Arecibo BAR = Barranquitas BAY = Bayamón INTER-CAG = Centro Universitario de Caguas-Metro FAJ = Fajardo GUA = Guayama HUM = Inter Humacao MET = Metro PON = Ponce SG = San Germán Solicita
admisión aquí
52
Trabajo Social (BA)
Este programa aspira a formar de manera amplia y profunda al profesional del trabajo social generalista en áreas teóricas y metodológicas, en el desarrollo de las competencias necesarias, así como en la clarificación de valores y actitudes para ejercer la profesión de manera efectiva. Además, incluye la oportunidad de obtener experiencias de educación práctica con agencias de bienestar social en Puerto Rico. Cursos de interés contenidos en el currículo de estudios: Introducción al Trabajo Social, Teorías y Debates en el Contexto Social de la Profesión, La Política Social y los Servicios Sociales, El Ser Humano y su Ambiente Social, Introducción a la Administración y Supervisión de Agencias Sociales, Proceso de la Comunicación y la Entrevista, Redacción de Historiales, Metodología de la Investigación Social, Experiencias de Práctica Generalista de Trabajo Social, Trabajo Social Generalista con Individuos y Familias, Trabajo Social Generalista con Grupos, Trabajo Social Generalista con la Comunidad y Seminario de Educación, Práctica.
El Recinto Metropolitano está autorizado para ofrecer este programa mediante la modalidad de educación a distancia.

PROGRAMAS TOTALMENTE EN LÍNEA
53
ACADÉMICA Oferta 270
Programas académicos presenciales
La Inter te ofrece certificados técnicos,grados asociados y bachilleratos.
Además ofrece más de 100 programas entre certificados profesionales, maestrías y doctorados.
80
Programas totalmente en línea
Recintos Escuelas profesionales 2 9


54
50
Programas acreditados por reconocidas entidades en Estados Unidos
100
Organizaciones estudiantiles para el desarrollo humano y profesional del estudiante

20

Programas totalmente en inglés 55
Artes Visuales, Artes Plásticas y Humanidades



56
SOLICITA ADMISIÓN AQUÍ admisiones.inter.edu
ARTES PLÁSTICAS (BA)
El estudio ponderado del desarrollo de las artes, su concepción y realización como objeto para ser apreciado como vehículo de expresión del ser humano, permite que la sociedad se examine, se exprese y se evalúe. Las artes son el espejo de la sociedad. Es la expresión de su cultura e identidad y la vincula con sus raíces éticas e historia.

Cerámica (B.A.)
Cursos de interés contenidos en el currículo de estudios: Escultura en Relieve, Cerámica Funcional, Cerámica Escultórica, Cerámica Figurativa, Barros y Barnices, Teoría del Color, Artes del Libro, Dibujo de la Figura, Aerógrafo “Airbrush”, Ensamblaje, Escultura de Metales, Arte Digital y Diseño Gráfico Computadorizado.
| SG | Fotografía (B.A.)
Cursos de interés contenidos en el currículo de estudios: Historia de la Fotografía, Fotografía en Blanco y Negro, Iluminación, Fotografía a Color, Fotografía Documental o Social, Historia de la Fotografía, Teoría del Color, Artes del Libro, Fotografía de la Figura, Aerógrafo “Airbrush”, Fotoserigrafía y Arte Digital.

| SG |
(B.A.)
Escultura (B.A.)
Cursos de interés contenidos en el currículo de estudios: Escultura en Relieve, Escultura en Talla, Ensamblaje, Escultura en Metales, Escultura de la Figura, Teoría del Color, Cerámica Funcional, Artes del Libro, Dibujo de la Figura, Cerámica Escultórica, Cerámica Figurativa, Aerógrafo “Airbrush”, Barros y Bernices, Arte Digital y Diseño Gráfico Computadorizado.
| SG | Pintura (B.A.)
Cursos de interés contenidos en el currículo de estudios: Investigaciones en Color, Dibujo de la Pintura, Acuarela, Pintura Avanzada, Pintura Experimental, Teoría del Color, Artes de Libro, Pintura de la Figura, Serigrafía, Dibujo Avanzado, Aerógrafo “Airbrush”, Pintura Mural, Arte Digital y Diseño Gráfico Computadorizado.
| SG |
Se ofrece en el Recinto de San Germán
*
** Solamente
57 inter.edu AGU • AGUADILLA ARE • ARECIBO BAR • BARRANQUITAS BAY • BAYAMON INTER-CAG • CENTRO UNIVERSITARIO DE CAGUAS-METRO FAJ • FAJARDO GUA • GUAYAMA HUM • INTER HUMACAO MET • METRO PON • PONCE SG • SAN GERMÁN
Bachillerato Grado Asociado
Se ofrece presencial y a distancia
se ofrece a distancia
Dibujo (B.A.)
Cursos de interés contenidos en el currículo de estudios: Dibujo en Medios Fluidos, Dibujo a Color, Dibujo en Medios Abrasivos, Dibujo de la Figura, Dibujo Avanzado, Teoría del Color, Artes del Libro, Aerógrafo “Airbrush”, Litografía, Arte Digital y Diseño Gráfico Computadorizado.
| SG |
Grabado (B.A.)
Cursos de interés contenidos en el currículo de estudios: Serigrafía, el Grabado y la Imagen, Técnicas de Intaglio, Litografía, Fotoserigrafía, Teoría del Color, Artes del Libro, Dibujo de la Figura, Serigrafía, Técnicas de Linóleo y Xilografía, Dibujo Avanzado, Aerógrafo “Airbrush”, Arte Digital y Diseño Gráfico Computadorizado.
| SG |
Diseño (B.A.)
El Bachillerato en Artes en Diseño prepara diseñadores humanistas con disposición para la reflexión etnográfica, política, económica y tecnológica. Además, capacita para ser investigadores creativos capaces de vincular las dimensiones socio-ecológicas del diseño como expresiones de identidades resilientes contemporáneas. Cursos de interés contenidos en el currículo de estudios: Fundamentos de Diseño, Dibujo como Fundamento del Diseño, Cronología del Diseño, Construcción Efímera, Diseño Bidimensional, Diseño Digital Básico, Diseño Tridimensional, Desarrollo Empresarial en Diseño, Taller Especializado, Desarrollo de Portafolio, Proyecto en Diseño, Proyecto en Diseño y Fundamentos de Empresarismo. | MET |
Estudios Humanísticos (B.A.)
El Bachillerato en Artes en Estudios Humanísticos prepara profesionales en las humanidades con un enfoque multidisciplinario transdisciplinario. Provee una visión programática flexible, innovadora, que promueve el desarrollo integral del estudiante para desarrollar sus capacidades cognoscitivas y creativas, así como el juicio crítico necesario para desempeñarse en el mundo contemporáneo. Cursos de interés contenidos en el currículo de estudios: 39 créditos de concentración seleccionados de entre las siguientes áreas del saber de las Humanidades: filosofía, música, arte, religión, idiomas, literatura, comunicaciones, y diseño. Los requisitos de concentración se establecerán en acuerdo entre el estudiante y el consejero académico con la aprobación del director de departamento.
Estudios Multidisciplinarios (B.A.)
El Bachillerato en Estudios Multidisciplinarios es un programa que se distingue por su enfoque no tradicional. Tiene como propósito capacitar al estudiante para incorporarse al mundo laboral, continuar estudios graduados y formar un profesional de excelencia insertado en la ciudadanía global. Cursos de interés contenidos en el currículo de estudios: Lógica Moderna, Historia de la Filosofía Occidental Antigua y Medieval, Rudimentos de Música, Fundamentos Técnicos y Prácticas del Dibujo, Actuación, Taller de Redacción, Taller de Lectura, Conversación y Repaso de Gramática, Redacción de Documentos Profesionales, Problemas Sociales de Puerto Rico, Introducción a las Ciencias Políticas, Relaciones Interamericanas, Derechos Humanos y Civiles y Psicología General.
| ARE | BAR |
Historia (B.A.)
El Bachillerato en Artes en Historia se instituyó con el fin de proveer a los estudiantes la oportunidad de estudiar y apreciar el desarrollo de la humanidad a través de los siglos. También tiene como finalidad brindar adiestramiento esencial para carreras en la educación, el derecho, la literatura, las comunicaciones, el periodismo, el arte, la bibliotecología, la archivística, la museografía, la religión, la empresa privada y el servicio público y otros. Cursos de interés contenidos en el currículo de estudios: el Mundo Antiguo, el Mundo Medieval, el Mundo Moderno, El Mundo Contemporáneo, América Latina Colonial, Puerto Rico, los Estados Unidos de América, Historiografía e Investigación Histórica.
| MET |
| MET |
58 Bachillerato Grado Asociado * Se ofrece presencial y a distancia ** Solamente se ofrece a distancia
Diseño Gráfico (B.A.)

El Grado en Artes Visuales en Diseño Gráfico prepara al estudiante para desempeñarse en la industria de la comunicación de ideas e información, mediante el uso de estrategias visuales, tales como el medio impreso, imágenes para comunicación comercial y presentaciones digitales. Capacita al estudiante para trabajar en el área del diseño gráfico, ya sea de impresos o electrónico, el diseño publicitario, el arte digital y el diseño para la distribución electrónica o Internet. Cursos de interés contenidos en el currículo de estudios: Teoría del Color, Fundamentos Técnicos y Práctica del Dibujo, Introducción al Diseño Gráfico, Imagen Electrónica, Diseño de Tipografía, Diseño de Publicaciones Impresas, Fotografía

Digital, Evolución del Diseño Gráfico, Diseño Gráfico Aplicado a la Internet, Diseño Gráfico Digital, Diseño de Proyectos Interactivos y Multimedia, Reproducción e Impresión, Diseño
Tridimensional, Vídeo y Sonido Digital, Efectos Especiales para Vídeo Digital y Diseño de Carteles.
| SG |
Inglés (B.A.)
El programa del Bachillerato en Artes en Inglés va dirigido a desarrollar profesionales competentes en las artes liberales, ofreciéndoles una base sólida en el dominio del inglés, tanto en la expresión oral y redacción como en el desarrollo de las destrezas del pensamiento crítico. Este bachillerato ofrece la oportunidad de que el egresado pueda entrar al mundo laboral de sectores como: empresas, gobierno, turismo, leyes, comunicaciones, investigación, literatura y traducción, entre otros, incluyendo la posibilidad de seguir estudios graduados. Cursos de interés contenidos en el currículo de estudios: Redacción Avanzada, Introducción a la Lingüística, Discurso Público, Estructuras Fundamentales de la Gramática, Fundamentos de la Fonética, Análisis Comparativo del Inglés y del Español, Análisis de los Géneros Literarios, Voces Norteamericanas, Voces Puertorriqueñas, Cultura Popular, Estudios Interculturales, El
Cuento, La Poesía, Teatro Moderno, Escritura Creativa, La Novela, Lenguaje y Poder, Introducción a la Sociolingüística e Investigación en Inglés.
| SG |
Español (B.A.)
El programa de Español está diseñado para desarrollar en los estudiantes destrezas en la comunicación oral y escrita así como para proveer el conocimiento general de las literaturas española,
59 inter.edu AGU • AGUADILLA ARE • ARECIBO BAR • BARRANQUITAS BAY • BAYAMON INTER-CAG • CENTRO UNIVERSITARIO DE CAGUAS-METRO FAJ • FAJARDO GUA • GUAYAMA HUM • INTER HUMACAO MET • METRO PON • PONCE SG • SAN GERMÁN
hispanoamericana y puertorriqueña en su contexto histórico y filológico de la lengua española. De igual forma, los prepara para seguir estudios graduados. Cursos de interés contenidos en el currículo de estudios: Introducción al Análisis de Textos, Gramática Superior, Lingüística Hispánica, Taller de Redacción, Literatura Española, Literatura Hispanoamericana, Literatura Puertorriqueña y La Lengua de Puerto Rico.

| MET |
- Concentración Menor en Idiomas Estratégicos
Cursos de interés contenidos en el currículo de estudios: Árabe Básico I, II, Árabe Intermedio I, II, Francés Básico I, II, Francés Intermedio I, II, Italiano Básico I, II, Italiano Intermedio I, II, Mandarín Básico I, II, Mandarín Intermedio I, II, Portugués Básico I, II, Portugués Intermedio I, II, Ruso Básico I, II, Alemán Básico I, II y Alemán Intermedio I, II.
| MET |
Diseño Gráfico (AVA)
El Grado Asociado en Artes Visuales en Diseño Gráfico prepara al estudiante para desempeñarse en la industria de la comunicación de ideas e información, mediante el uso de estrategias visuales, tales como: el medio impreso, imágenes para comunicación comercial y presentaciones digitales. Capacita al egresado para trabajar en el área del diseño gráfico, ya sea de impresos o electrónico, el diseño publicitario, el arte digital y el diseño para la distribución electrónica o Internet. Cursos de interés concernidos en el currículo de estudios: Fundamentos Técnicos y Práctica del Dibujo, Introducción al Diseño Gráfico, Imagen Electrónica, Diseño de Tipografía, Diseño de Publicaciones Impresas, Fotografía Digital, Evolución del Diseño Gráfico, Diseño Gráfico Aplicado a la Internet, Diseño Gráfico Digital y Reproducción e Impresión.
| SG |
Estudios Multidisciplinarios (A.A.)
El Grado Asociado en Estudios Multidisciplinarios provee una formación integral al estudiante mediante el desarrollo de conocimientos, destrezas y actitudes que fortalezcan su formación profesional a través de los estudios multidisciplinarios. Se espera preparar profesionales que atiendan los diferentes problemas y situaciones que afectan la sociedad desde un marco de referencia humanista. Este programa integra las diferentes áreas del conocimiento que incluyen el dominio de las destrezas básicas, y las disciplinas de las humanidades, las artes del lenguaje y las ciencias sociales.
| ARE |
Estudios Generales (A.A.)
El Grado Asociado en Estudios Generales aspira a desarrollar un conjunto de experiencias educativas integradas, encaminadas a la formación de profesionales con un enfoque interdisciplinario. Su currículo contribuirá al desarrollo integral del estudiante en sus distintas dimensiones personales y profesionales. Cursos de interés contenidos en el currículo de estudios: Historia del Arte, Fundamentos de Gerencia, Biología General, Laboratorio de Destrezas de Biología, Desarrollo de Páginas WEB, Emprendedurismo Social, Introducción a las Ciencias Ambientales, Visión del Mundo a través de la Literatura, Desarrollo Humano, Dimensiones Éticas de Asuntos Contemporáneos y Psicología General.
| BAY |
Recreación para Personas de Edad Avanzada (A.A.)
El Grado Asociado en Recreación para Personas de Edad Avanzada tiene el propósito de proveer una formación académica a individuos para desempeñarse como líderes que atiendan las necesidades recreativas de las personas de edad avanzada. Cursos de interés contenidos en el currículo de estudios: Historia y Fundamentos de la Recreación, Temas de Salud, Educación Física y Recreación, Recreación para Personas de Edad Avanzada, Planificación, Organización y Realización de Actividades Recreativas para Personas de Edad Avanzada, Entrenamiento Físico y Deportivo para Personas de Edad Avanzada, Primeros Auxilios y Seguridad, Fundamento Empresarial, Introducción a la Gerontología, Neuropsicología del Adulto de Edad Avanzada, Experiencias de Movimiento, Recreación Social y Seminario.
| ARE |
60


61 inter.edu AGU • AGUADILLA ARE • ARECIBO BAR • BARRANQUITAS BAY • BAYAMON INTER-CAG • CENTRO UNIVERSITARIO DE CAGUAS-METRO FAJ • FAJARDO GUA • GUAYAMA HUM • INTER HUMACAO MET • METRO PON • PONCE SG • SAN GERMÁN



admisiones.inter.edu 62
SOLICITA ADMISIÓN AQUÍ
Biología (B.S.)
El Bachillerato en Ciencias en Biología aspira a preparar profesionales capaces de comprender los procesos biológicos, con un enfoque multidisciplinario. Provee las experiencias que los ayudarán a identificar, analizar y resolver problemas de orden biológico utilizando el método científico. Propicia el desarrollo de conocimientos, destrezas de laboratorio y actitudes para ejercer la profesión con responsabilidad ética, crítica y creativa. Cursos de interés contenidos en el currículo de estudios: Biología General, Laboratorio de Destrezas de Biología, Zoología, Botánica, Bioestadísticas, Genética, Microbiología General, Anatomía y Fisiología Humana, Ecología, Biología Celular y Molecular y Laboratorio de Destrezas de Biología Celular y Molecular.

| TODOS |
Biología Forense (B.S.)
El Bachillerato en Ciencias en Biología Forense presenta un currículo de naturaleza interdisciplinaria aplicando las ciencias naturales y matemáticas al análisis comparativo de material biológico para contribuir a esclarecer las causas, métodos y circunstancias de muerte y otros delitos. El programa aspira a que el egresado sea proficiente en la colección y preservación de material biológico y en el uso de técnicas de análisis hematológicos, serológicos y de ADN. Cursos de interés contenidos en el currículo de estudios: Introducción a las Ciencias Forenses, Temas Especiales, Investigación Forense, Análisis Biológico Forense, Práctica Forense y Seminario Integrador.
Biotecnología (B.S.)
El Bachillerato en Ciencias en Biotecnología aspira a desarrollar profesionales con competencias para buscar soluciones a problemas de la sociedad, aplicando los conocimientos y destrezas de la Biotecnología. El currículo incluye el desarrollo de destrezas para el manejo apropiado de las tecnologías modernas aplicadas a la vida para la producción de bienes de consumo. El egresado de este programa podrá desempeñarse en el campo de la biotecnología o el campo de la investigación. También podría aspirar a realizar estudios graduados o profesionales. Cursos de interés contenidos en el currículo de estudios: Biotecnología Molecular, Tecnología de ADN Recombinante, Cultivo de Tejido y Aplicaciones Técnicas, Biotecnología Agrícola y Ambiental, Purificación y Análisis de Proteínas, Métodos de Investigación en Biotecnología, Biología General, Laboratorio de Destrezas de Biología, Bioestadísticas, Genética, Microbiología General, Inmunología, Microbiología Industrial, Biología Celular y Molecular.

| AGU | ARE | BAR | BAY | GUA | PON |
| BAY |
63 inter.edu AGU • AGUADILLA ARE • ARECIBO BAR • BARRANQUITAS BAY • BAYAMON INTER-CAG • CENTRO UNIVERSITARIO DE CAGUAS-METRO FAJ • FAJARDO GUA • GUAYAMA HUM • INTER HUMACAO MET • METRO PON • PONCE SG • SAN GERMÁN
Bachillerato Grado Asociado * Se ofrece presencial y a distancia ** Solamente se ofrece a distancia
Ciencias Biomédicas (B.S.)
El Bachillerato en Ciencias en Ciencias Biomédicas está diseñado para desarrollar en los estudiantes la comprensión de los conceptos modernos de las Ciencias Biomédicas para familiarizarlos con el desarrollo de las destrezas básicas de laboratorio, enseñarles a resolver problemas científicos que los capacitarán para la solución de problemas en nuestra sociedad y para enfrentarse a la demanda de empleo o estudios post-graduados. El programa está dirigido a personas interesadas en continuar estudios graduados y profesionales en áreas tales como: Ciencias Biomédicas, Medicina, Odontología, Optometría, Salud Pública y Ciencias aliadas a la Salud. Además, pueden desempeñarse en la industria farmacéutica. Cursos de interés contenidos en el currículo de estudios: Genética Humana, Anatomía y Fisiología Humana, Ética Biomédica, Bioquímica de la Fisiología Humana, Biología General, Laboratorio de Destrezas de Biología, Microbiología General, Química General, Química Orgánica, Precálculo y Física General.
| MET | PON |
Microbiología (B.S.)
El Bachillerato en Ciencias en Microbiología es de carácter interdisciplinario. Integra las áreas de las ciencias naturales y las aplica al entendimiento de los microorganismos y sus diversas funciones. Se estudian las características de los diferentes grupos de microorganismos, su crecimiento y desarrollo, las interacciones ambientales y su importancia. El programa está dirigido a formar egresados proficientes en el uso de técnicas microbiológicas y análisis químico. Se hace énfasis
en la aplicación de medidas de asepsia, seguridad en un ambiente controlado, diseño de investigación y análisis de datos. Cursos de interés contenidos en el currículo de estudios: Fisiología Microbiana, Ecología Microbiana, Técnicas de Aplicación Microbiológicas, Seminario Integrador en Microbiología, Biología General, Laboratorio de Destrezas de Biología, Genética, Microbiología General, Inmunología, Micología, Microbiología Médica, Microbiología Industrial, Química General, Química Orgánica, Bioquímica, Biología Celular y Molecular, Precálculo y Física General.



Biotecnología (A.A.S.)
Con este grado asociado conocerás los fundamentos de los procesos biológicos, químicos, físicos, matemáticos y de informática que son la base de la biotecnología. También trabajarás con los procesos biotecnológicos que pueden ser aplicados para generar productos y servicios en las áreas médicas, ambientales, agrícolas, industriales, entre otras. Conocerás los conceptos fundamentales de los organismos vivos y de los microrganismos. Estudiarás los procesos genéticos que se desarrollan en la célula, así como la estructura y función de los ácidos nucleicos y su participación en la información genética. Descubrirás la importancia de las contribuciones de la biotecnología al desarrollo del conocimiento. | BAR |

|
| FAJ | MET | PON | SG |
| AGU
BAY
64 Bachillerato Grado Asociado * Se ofrece presencial y a distancia ** Solamente se ofrece a distancia


65 inter.edu AGU • AGUADILLA ARE • ARECIBO BAR • BARRANQUITAS BAY • BAYAMON INTER-CAG • CENTRO UNIVERSITARIO DE CAGUAS-METRO FAJ • FAJARDO GUA • GUAYAMA HUM • INTER HUMACAO MET • METRO PON • PONCE SG • SAN GERMÁN
Ciencias

Ambientales y Química


SOLICITA ADMISIÓN AQUÍ admisiones.inter.edu
66
Tecnología Ambiental (B.S.)
El Bachillerato en Ciencias en Tecnología Ambiental es interdisciplinario. Provee a los estudiantes los conocimientos y las destrezas fundamentales relacionados con el análisis de contaminantes ambientales, las leyes y reglamentos ambientales y los procesos de evaluación ambiental. El programa está diseñado para que el estudiante se enfoque en áreas tales como: muestreo y análisis ambiental, manejo de recursos naturales, salud ambiental o continuar estudios graduados. Cursos de interés contenidos en el currículo de estudios: Política Pública Ambiental, Evaluación Ambiental, Internado, Seminario Integrador, Biología General, Laboratorio de Destrezas de Biología, Zoología, Botánica, Bioestadística, Microbiología General, Ecología, Química General, Química Orgánica, Química Ambiental, Química Analítica, Seguridad Industrial, Precálculo y Física General.
| SG |
Ciencias Ambientales (B.S.)
El Bachillerato en Ciencias en Ciencias Ambientales está dirigido a personas que estén interesadas en trabajar como profesionales del ambiente en el control de contaminación de aguas, suelo y aire, y en la conservación de los recursos naturales terrestres y marinos. Está diseñado para proveer al estudiante las destrezas para desempeñarse en estas dos ramas del quehacer ambiental tanto en el gobierno como en la empresa privada y/o industria. Se provee al estudiante conocimiento sobre la base legal, y destrezas en metodología y técnica. Se dará énfasis en la percepción de la naturaleza como sistema.
Cursos de interés contenidos en el currículo de estudios: Introducción

Química Industrial (B.S.)
El Bachillerato en Ciencias en Química Industrial presenta un currículo de naturaleza interdisciplinaria, que en términos generales, capacita al estudiante con los conocimientos específicos en temas industriales tales como manufactura química, manufactura farmacéutica, validaciones, aspectos de servicios técnicos, análisis químico de laboratorio e industrial y manejo ambiental. El programa se caracteriza por la combinación de conocimientos en química, biología, matemáticas y cursos sobre los temas industriales mencionados. Cursos de interés contenidos en el currículo de estudios: Química General, Química Orgánica, Química Analítica Ambiental, Química Farmacéutica, Biotecnología para Químicos, Química Industrial, Análisis Químico Industrial, Química de Materiales, Validación de Procesos, Práctica Química Industrial, Seminario Química Industrial, Biología General, Laboratorio de Destrezas de Biología, Microbiología General, Precálculo, Cálculo y Física para Ingenieros.
| BAY |
a las Ciencias Ambientales, Calidad del Aire, Conservación y Manejo de Recursos Naturales, Manejo de Desperdicios, Salud y Seguridad Ocupacional en la Protección Ambiental, Sistemas de Información Geográfica en las Ciencias Ambientales, Uso, Conservación y Calidad de Agua, Internado en Ciencias Ambientales, Seminario Integrador en las Ciencias Ambientales, Biología General, Laboratorio de Destrezas de Biología, Zoología, Botánica, Bioestadística, Microbiología General, Ecología, Salud Ambiental, Leyes, Política y Reglamentación Ambiental, Química General, Química Analítica, Precálculo y Física General.
| AGU | BAR | PON | Bachillerato Grado Asociado * Se ofrece presencial y a distancia ** Solamente se ofrece a distancia 67 inter.edu AGU • AGUADILLA ARE • ARECIBO BAR • BARRANQUITAS BAY • BAYAMON INTER-CAG • CENTRO UNIVERSITARIO DE CAGUAS-METRO FAJ • FAJARDO GUA • GUAYAMA HUM • INTER HUMACAO MET • METRO PON • PONCE SG • SAN GERMÁN
Química (B.S.)
El Bachillerato en Ciencias en Química está diseñado para proveer conocimientos amplios en la química con énfasis en el razonamiento científico, la solución de problemas y el uso de técnicas e instrumentación de laboratorios que propicien el desarrollo de líderes competentes, responsables y éticos. Está diseñado para estudiantes que deseen trabajar como químicos en la industria o gobierno o deseen proseguir estudios graduados en química, o en cualquier rama de las ciencias. Cursos de interés contenidos en el currículo de estudios: Química General, Química Orgánica, Determinación de Estructuras por Métodos Espectroscópicos, Química Analítica, Computación y Aplicación a la Química, Química
Física: Termodinámica, Química
Física: Cuántica y Cinética, Química Inorgánica Avanzada, Química
Analítica Instrumental, Seminario Integrador, Biología General, Laboratorio de Destrezas de Biología, Precálculo, Cálculo y Física General.
| ARE | GUA | MET | SG |
Ciencias Agrícolas en Agronomía (B.S.)
El programa de Bachillerato en Ciencias Agrícolas en Agronomía aspira a formar profesionales en el sector agrícola particularmente en las áreas de cultivos, producción animal y empresarismo. El diseño curricular de este programa incluye cursos teóricos y prácticos. Además, en el marco conceptual del currículo se integran elementos tales como empresarismo, investigación y tecnología. Se espera que el egresado de este programa

pueda adquirir conocimientos teóricos y prácticos que le permitan trabajar en las áreas de calidad, la producción e innovación agropecuaria y en la conservación del medio ambiente. El enfoque de la misión y filosofía del currículo propuesto enmarcan una visión del egresado con una educación teórica y práctica que lo capacite para desempeñarse exitosamente tanto a nivel profesional como personal. El programa de Bachillerato en Ciencias Agrícolas en Agronomía tiene como meta educativa preparar un egresado con los conocimientos, las destrezas y las actitudes que lo capaciten para emplearse, generar agronegocios y al mismo tiempo ofrecer un buen servicio a la sociedad. Se pretende formar un profesional educado y competente, responsable y respetuoso para consigo mismo, su profesión y la sociedad. Cursos de interés contenidos en el currículo de estudios: Botánica y Fisiología Vegetal, Edafología, Fitopatología, Bienestar Animal, Salud y Seguridad Agrícola, Producción de Cultivo I, II, Nuevas Tendencias Agrícolas, Alimentación y Nutrición Animal, Producción Animal I, II, Residuos Agropecuarios, Empresarismo Agrícola, Práctica en Agropecuaria, Biotecnología Agropecuaria, Maquinaria y Mecanización Agrícola, Química Aplicada a la Ciencias Agrícolas, Gerencia de Agronegocios, Retos ante el Cambio Climático, de Suelo y Agua, Manejo de Pastos y Forrajes,
Diseño y Evaluación de Proyectos, Mercadeo Agrícola, Investigación en Ciencias Agrícolas, Práctica en Ciencias Agrícolas y Física General y sus Aplicaciones.
| GUA
| Ciencia Animal con Pre-Veterinaria (B.S.)
El Bachillerato en Ciencias en Tecnología Veterinaria con Preveterinaria comprende el estudio del manejo y cuidado de los animales. Además, cuenta con un componente de cursos de las diferentes áreas de las ciencias naturales. Este permite al estudiante, que desee continuar estudios posgraduados como médico veterinario, completar los requisitos de admisión a la mayoría de las escuelas de veterinaria. El estudiante que no desee completar el bachillerato tendrá la opción de terminar un Grado de Asociado en Técnico Veterinario. Cursos de interés contenidos en currículo de estudios: Introducción a las Ciencias Veterinarias, Biología Animal, Bienestar Animal, Anatofisiología animal, Alimentación y Nutrición, Enfermería Veterinaria, Parasitología y Microbiología, Laboratorio Clínico, Farmacología y Toxicología, Anestesia y Cirugía, Radiología Práctica, Biología General I, II, Laboratorio de Destrezas I, II, Bioestadísticas, Química General I, II, Química Orgánica I, II y Física
68
Tecnología Veterinaria (B.S.)
El Bachillerato en Ciencias en Tecnología Veterinaria aspira a formar profesionales que puedan asistir al médico veterinario en los procedimientos de exploración, tratamiento y farmacología, prevención y diagnóstico de las enfermedades en los animales. El egresado podrá realizar otras tareas de asistencia a los animales domésticos, de investigación y de finca en las áreas de urgencias, sala de operaciones y primeros auxilios; así como las técnicas de toma de imágenes y pruebas de laboratorio. El programa está diseñado para estudiantes que deseen trabajar como tecnólogos veterinarios en clínicas, hospitales, fincas y centros de investigación con animales o en cualquier otro lugar donde el médico veterinario necesite su asistencia. El estudiante que no pueda completar el bachillerato tendrá la opción de terminar un Grado de Asociado en Técnico Veterinario. Cursos de interés contenidos en currículo de estudios: Introducción a las Ciencias Veterinarias, Biología Animal, Bienestar Animal, Anatofisiología Animal, Alimentación y Nutrición, Enfermería Veterinaria, Parasitología y Microbiología Laboratorio Clínico, Farmacología y Toxicología, Anestesia y Cirugía, Radiología, Práctica Técnico Veterinario, Higiene y Seguridad Alimentaria, Enfermedades Comunes en Animales, Epidemiología y Zoonosis, Manejo y Cuidados de Animales de Laboratorio, Técnicas Modernas de Diagnóstico por Imagen, Enfermería y Manejo de Animales de la Finca, Manejo y Cuidados de los Equinos, Administración de Clínicas Veterinarias y Práctica.
| GUA |
Tecnología Agropecuaria (A.A.S.)
El Grado Asociado en Ciencias Aplicadas en Tecnología Agropecuaria aspira a formar profesionales en el sector agrícola. Este programa está diseñado para estudiantes que se interesan en los campos de la producción agropecuaria y en las agroindustrias. El egresado de este programa podrá adquirir conocimientos teóricos y prácticos que le permitan trabajar en las áreas de calidad, la producción e innovación agropecuaria y en la conservación del medio ambiente. Botánica y Fisiología Vegetal, Edafología, Fitopatología, Salud y Seguridad Agrícola, Producción de Cultivos I y II, Nuevas Tendencias Agrícolas, Producción Animal, Residuos Agropecuarios, Comercialización de Productos, entre otros. |

Técnico Veterinario (A.A.S.)
El Grado Asociado en Ciencias Aplicadas en Técnico Veterinario aspira a formar profesionales que puedan asistir al médico veterinario en los procedimientos de exploración, tratamiento y farmacología, prevención y diagnóstico de las enfermedades en los animales. El egresado podrá realizar otras tareas de asistencia a los animales domésticos, en las áreas de urgencias, sala de operaciones y primeros auxilios, así como las técnicas de toma de imágenes y pruebas de laboratorio. El programa está diseñado para estudiantes que deseen trabajar como asistentes en clínicas, hospitales, fincas y centros de investigación con animales o cualquier otro lugar donde el médico veterinario necesite su asistencia.
| GUA |

BAR |
|
GUA
69 inter.edu AGU • AGUADILLA ARE • ARECIBO BAR • BARRANQUITAS BAY • BAYAMON INTER-CAG • CENTRO UNIVERSITARIO DE CAGUAS-METRO FAJ • FAJARDO GUA • GUAYAMA HUM • INTER HUMACAO MET • METRO PON • PONCE SG • SAN GERMÁN
Ciencias de la Salud


70 SOLICITA ADMISIÓN AQUÍ admisiones.inter.edu
Tecnología Médica (B.S.)
El programa de Tecnología Médica responde a la misión de preparar profesionales en el campo de la salud que sirvan a las necesidades del Puerto Rico de hoy. Este programa aspira a proveer una instrucción académica de excelencia al preparar tecnólogos médicos o científicos del laboratorio clínico con los conocimientos, las destrezas, y las actitudes necesarias en un profesional de las ciencias del laboratorio clínico que se inicia en la profesión. Igualmente pretende desarrollar individuos capacitados para comunicarse e interactuar con los pacientes, sus pares y otros profesionales de la salud. Cursos de interés contenidos en el currículo de estudios: Principios Básicos, Estadística y Técnicas Moleculares en el Laboratorio Clínico, Química Clínica, Patología y Diagnóstico Molecular, Fluidos del Cuerpo, Inmunología Clínica, Banco de Sangre, Hematología y Coagulación y Diagnóstico Molecular en Hematopatología, Micología y Virología, Bacteriología Clínica y Diagnóstico Molecular en Enfermedades Infecciosas, Parasitología Clínica, Administración de Laboratorio, Ética y Educación, Seminario Integrador e Investigación Clínica, Práctica Clínica en Urinálisis, Práctica Clínica en un Banco de Sangre, Práctica Clínica en Serología, Inmunología, Práctica Clínica en Parasitología, Práctica en Química Clínica, Práctica Clínica en Hematología y Coagulación y Práctica Clínica en Microbiología.

Ciencias Radiológicas
en Tomografía Computadorizada y Resonancia Magnética (B.S.)
El currículo del Bachillerato en Ciencias en Ciencias Radiológicas ofrece un programa educacional comprensivo para estudiantes que posean un Grado de Asociado en Tecnología Radiológica y tecnólogos radiológicos certificados. El propósito principal del programa es el desarrollo de competencia clínica en modalidades de imágenes diagnósticas avanzadas: Resonancia Magnética y Tomografía Computadorizada. Cursos de interés contenidos en el currículo de estudios: Física de Tomografía Computadorizada, Física de Resonancia Magnética, Introducción a la Tomografía Computadorizada y Resonancia Magnética, Anatomía Seccional y Patofisiología, Procedimientos y Patología en las Imágenes de Tomografía Computadorizada, Procedimientos y Patología de Imágenes en Resonancia Magnética, Práctica Clínica de Tomografía Computadorizada, Práctica Clínica de Resonancia Magnética y Seminario Integrador.
| AGU | BAR | PON |
MET | SG |
|
Bachillerato Grado Asociado
* Se ofrece presencial y a distancia
71 inter.edu AGU • AGUADILLA ARE • ARECIBO BAR • BARRANQUITAS BAY • BAYAMON INTER-CAG • CENTRO UNIVERSITARIO DE CAGUAS-METRO FAJ • FAJARDO GUA • GUAYAMA HUM • INTER HUMACAO MET • METRO PON • PONCE SG • SAN GERMÁN
** Solamente se ofrece a distancia
Tecnología Radiológica en Mamografía y Angiografia (B.S.)

El programa está diseñado para la formación académica en las áreas de ciencias de imágenes radiológicas y permite al estudiante la opción de obtener un diploma de Grado de Asociado en Ciencias Aplicadas en Tecnología Radiológica al completar los 84 créditos requisitos para la concentración. Además, pretende ofrecer al profesional que haya obtenido un Grado de Asociado en Tecnología Radiológica de una universidad acreditada, la oportunidad de proseguir estudios conducentes al Bachillerato en Ciencias en Tecnología Radiológica con concentración en Mamografía y Angiografía. Los cursos prácticos se ofrecerán en diferentes escenarios estructurados en instituciones de salud afiliadas y certificadas donde el estudiante desarrollará los conocimientos, destrezas y competencias requeridas para ofrecer un servicio de calidad. Cursos de interés contenidos en el currículo de estudios: Protección Radiológica, Cuidado del Paciente, Introducción a la Tecnología Radiológica, Principios de Exposición y Procesado Radiográfico, Procedimientos y Evaluación Radiográfica, Medios de Contraste, Crítica y Control de Calidad Radiológica, Procedimientos y Evaluación Radiológica, Física Radiológica, Patología Radiológica y Terminología Médica, Anatomía Seccional, Radiobiología, Modalidades y Equipo de Imagen Diagnóstica, Práctica Clínica, Control de Calidad Mamográfica, Creación de Imágenes Radiográficas en Computadora, Anatomía y Patología del Seno, Procedimiento y Evaluación Radiográfica del Seno, Fundamentos de la Angiografía, Práctica Clínica en Mamografía y Práctica Clínica en Angiografía.

Terapia del Habla y Lenguaje (B.S.)
El Bachillerato en Ciencias en Terapia del Habla y Lenguaje aspira a preparar profesionales competentes que puedan colaborar en atender las necesidades de niños y jóvenes con desórdenes de comunicación en Puerto Rico. El profesional egresado del programa estará capacitado para ofrecer servicios terapéuticos a niños y jóvenes entre las edades de 0-21 años bajo la supervisión de un Patólogo del Habla y Lenguaje licenciado, según establecido en la Ley 77 que reglamenta el ejercicio de los profesionales de Terapia del Habla y Lenguaje, Patología del Habla y Lenguaje y Audiología en Puerto Rico. Cursos de interés contenidos en el currículo de estudios: Anatomía y Fisiología del Habla y Lenguaje, Desarrollo Normal del Lenguaje, Introducción a la Audiología, Asuntos Éticos, Legales y Procedimientos Clínicos, Desórdenes de Fluidez en Niños, Desórdenes de Articulación y Fonología, Desórdenes de Voz en Niños, El Uso de la Tecnología en la Práctica de Terapia del Habla y Lenguaje, Fisura de Paladar y Anomalías Cráneo Faciales, Intervención con Niños con Impedimentos Auditivos, Condiciones Cognitivas y Psicosociales Asociadas con Problemas del Habla y Lenguaje, Identificación y Tratamiento de Niños con Desórdenes del Lenguaje Oral, Identificación y Tratamiento de Niños con Desórdenes del Lenguaje Escrito, Documentación Clínica en la Profesión en Terapia del Habla y Lenguaje, Intervención Temprana, Intervenciones Terapéuticas para Niños con Problemas del Habla y Lenguaje, Lenguaje de Señas, Disfagia en Niño, Ayudas Aumentativas y Alternas para la Comunicación en Niños, Seminario Integrador y Práctica.

| AGU | FAJ | PON |
| AGU |
| FAJ | 72 Bachillerato Grado Asociado * Se ofrece presencial y a distancia ** Solamente se ofrece a distancia
BAR
Tecnología Deportiva (B.A.)
El Bachillerato en Artes en Tecnología Deportiva preparará al estudiante en la evaluación de traumas a nivel del tejido blando y duro, emergencias médicas y accidentes, así como en posibles enfermedades crónicodegenerativas. Tal protocolo se efectúa en las poblaciones atléticas y en individuos que practican ejercicios para el mantenimiento de la salud. También se estudia la prevención de accidentes y el manejo y la rehabilitación del accidentado. Se describen los aspectos fisiológicos, mentales, sociales y dietéticos de las personas que participan en actividades deportivas competitivas o recreativas. El programa enfatiza el diseño y la estructuración de metodologías de entrenamiento físico-deportivo de carácter científico para poblaciones especiales y en general. Cursos de interés contenidos en el currículo de estudios: Fundamentos de la Educación Física y la Tecnología Deportiva, Kinesiología y Anatomía Funcional, Prevención y Seguridad Personal para Niños, Jóvenes y Adultos, Psicología del Deporte, Introducción a la Prevención y al Manejo de Lesiones, Masajes Terapéuticos, Destrezas Fundamentales y Entrenamiento en los Deportes de Conjunto, Destrezas Fundamentales y Entrenamiento en los Deportes Individuales, Evaluación de Lesiones y Diseño de un Programa de Rehabilitación, Física en Deportes Individuales y de Conjunto, Salud Personal, Colectiva y Seguridad, Nutrición en el Deporte, Ejercicio y Actividad Física, Principios de Recreación Terapéutica, Tendencias y Controversias en Tecnología Deportiva, Gerencia de Programas de Educación Física, Bienestar, Salud y
Deportes, Fisiología del Movimiento Humano, Medición, Evaluación e Investigación del Desarrollo de la Aptitud Física y sus Componentes, Técnicas y Destrezas para el Entrenador Personal, Metodología del Entrenamiento Deportivo, Diseño de Programas de Ejercicios, Metodología del Entrenamiento Funcional y Práctica en la Prevención y el Manejo de Lesiones.
| GUA | MET | SG |
Sonografía Médica en Sonografía Cardiovascular (B.S.)
La finalidad principal del programa es desarrollar las competencias clínicas en la modalidad de sonografía médica, así como promover el desarrollo de un profesional sensible, con conocimiento y destrezas para proveer un servicio de alta calidad. El programa ofrece al estudiante la oportunidad de desarrollarse profesionalmente mediante la adquisición de experiencias en el área didáctica y clínica. Al ser la sonografía una ciencia aliada a la salud, utiliza la modalidad del ultrasonido para evaluar el bienestar del paciente a través del diagnóstico, análisis y seguimiento de las enfermedades o procedimientos médicos. Cursos de interés contenidos en el currículo de estudios: Principios Básicos de Ultrasonidos, Física de Ultrasonidos, Sonografía de Abdomen, Sonografía de Pelvis Pediátrica y Adulto, Sonografía Obstétrica, Sonografía Musculo-Esqueletal, Sonografía Cardiovascular, Ecocardiografía, Patofisiología, Cardiovascular y Sonografía Vascular.

Enfermería (B.S.N.)
El programa de Enfermería tiene como misión formar enfermeras y enfermeros capaces de ofrecer cuidado competente, sensible, efectivo, seguro y de calidad al cliente persona, familia y comunidad. El estudiante aprenderá fundamentos de enfermería, del cuidado del adulto, del cuidado materno-neonatal, del cuidado pediátrico, entre otros. Cursos de interés contenidos en el currículo de estudios: Fundamentos de Enfermería, Práctica de Fundamentos de Enfermería, Aspectos Farmacológicos, Fundamentos en el Cuidado del Adulto, Práctica Adulto, Fundamentos en el Cuidado MaternoNeonatal, Práctica en el Cuidado Materno-Neonatal, Fundamentos de Cuidado Pediátrico, Práctica en el Cuidado Pediátrico, Fundamentos en el Cuidado Sicosocial, Práctica Sicosocial y Seminario de Transición, Dimensiones de la Práctica Profesional, Introducción al Proceso de Investigación en Enfermería, Estimado de Salud, Intervención en Transiciones Sicosociales, Intervenciones Profesionales en el Ciclo de Vida, Cuidado de Enfermería a la Familia y Comunidad, Práctica en Intervenciones Profesionales en el Ciclo de Vida, Práctica en Cuidado de Enfermería a la Familia y la Comunidad y Taller Integrador.
| AGU | ARE | BAR | BAY | INTER-CAG | INTER-HUM | GUA | MET | PON | SG |
| PON |
73 inter.edu AGU • AGUADILLA ARE • ARECIBO BAR • BARRANQUITAS BAY • BAYAMON INTER-CAG • CENTRO UNIVERSITARIO DE CAGUAS-METRO FAJ • FAJARDO GUA • GUAYAMA HUM • INTER HUMACAO MET • METRO PON • PONCE SG • SAN GERMÁN
Ciencias de la Salud (B.S.)

El programa está diseñado para promover el desarrollo de un profesional de la salud sensible y que demuestra el conocimiento y destrezas para ofrecer servicios de salud de calidad. Estos conocimientos están fundamentados en conceptos y principios de las ciencias naturales, las ciencias sociales y las ciencias de la salud. El estudiante puede optar por una subespecialidad en administración o en educación, lo que le permitirá ocupar puestos de mayor rango y de liderato en su trabajo. Cursos de interés contenidos en el currículo de estudios: Desarrollo Humano, Conceptos Esenciales en Ciencias de la Salud, Salud y Enfermedad a través del Ciclo de Vida, Métodos de Investigación en Ciencias de la Salud, Garantía y Mejoramiento de Calidad, Promoción de la Salud Colectiva, Psicología General y Métodos Estadísticos.
| PON |
» Educación

Cursos de interés contenidos en el currículo de estudios: Métodos y Técnicas de Enseñanza en Ciencias de la Salud, Diseño y Desarrollo de un Plan Educativo en Salud, Internado, Historia y Filosofía de la Educación, Sociedad y Educación, Psicología del Desarrollo y Psicología del Aprendizaje.
| PON |
» Administración
Cursos de interés contenidos en el currículo de estudios: Planificación y Mercadeo de Servicios de Salud, Principios de Auditoría aplicados a los Servicios de Salud, Internado, Fundamentos de Gerencia y Supervisión.

| PON |
Emergencias Médicas (B.S.)
El Bachillerato en Emergencias Médicas aspira a preparar profesionales paramédicos capaces de ofrecer cuidado prehospitalario de emergencia de forma competente, sensible, efectiva, segura y de calidad, a clientes en situaciones relacionadas con una amenaza a la salud y que ocurren por causa fortuita. Cursos de interés contenidos en el currículo de estudios: Destrezas en el Lenguaje de Señas, Conceptos y Principios Básicos de Emergencias Médicas, Patofisiología, Conceptos Básicos de Biología, Anatomía y Fisiología, Estimado del Cliente, Farmacología Aplicada, Función Cardiorrespiratorio, Sistema de Transporte y Comunicación, Operación Rescate, Manejo de Trauma, Fundamentos de Microbiología, Dimensiones de la Práctica y la Ética Profesional, Seminario de Investigación, Emergencias, Dimensiones Éticas, Bienestar y Calidad de Vida, Poblaciones Especiales, Manejo de Escenarios Complejos y Práctica Profesional.
| SG |

74 Bachillerato Grado Asociado * Se ofrece presencial y a distancia ** Solamente se ofrece a distancia
Enfermería (A.A.S)

El programa de Enfermería tiene como misión formar enfermeras y enfermeros capaces de ofrecer cuidado competente, sensible, efectivo, seguro y de calidad al cliente persona, familia y comunidad. El estudiante aprenderá fundamentos de enfermería, del cuidado del adulto, del cuidado materno-neonatal, del cuidado pediátrico, entre otros. Los cursos de interés contenidos en el currículo del programa: Fundamentos de Enfermería, Práctica de Fundamentos de Enfermería, Aspectos Farmacológicos, Fundamentos en el Cuidado del Adulto l y II, Práctica Adulto I y II, Fundamentos en el Cuidado Materno-Neonatal, Fundamentos de Cuidado Pediátrico, Práctica en el Cuidado

Asistente del Terapista Físico (A.S.)
El programa de Asistente del Terapista Físico va dirigido a desarrollar un para-profesional capacitado para que pueda brindar servicios de alta calidad en el campo de la rehabilitación. Provee conocimientos científicos en conceptos y principios de las ciencias naturales, las ciencias sociales y las humanidades, para aplicarlos al campo de la terapia física. Te ofrece principios de cuidado al paciente, anatomía y fisiología, modalidades terapéuticas, dimensión emocional de la incapacidad, terapia física cardiopulmonar, crecimiento y desarrollo humano, rehabilitación ortopédica y rehabilitación neurológica, entre otros.
 | PON |
| PON |
75 inter.edu AGU • AGUADILLA ARE • ARECIBO BAR • BARRANQUITAS BAY • BAYAMON INTER-CAG • CENTRO UNIVERSITARIO DE CAGUAS-METRO FAJ • FAJARDO GUA • GUAYAMA HUM • INTER HUMACAO MET • METRO PON • PONCE SG • SAN GERMÁN
Tecnología en Ciencias Ópticas (A.A.S.)
El programa en Ciencias Aplicadas en Ciencias Ópticas ofrece una preparación universitaria que propicia el desarrollo de las destrezas técnicas y las competencias de la profesión; ofrece, además, una base científica y los conocimientos más recientes en el campo profesional. Los cursos preparan al estudiante para la ejecución de las funciones y operaciones que se requieren en la profesión del óptico. Algunos de ellos son Fundamentos de Óptica, Principios de Biología, Materiales Oftálmicos I y II, Anatomía y Fisiología del Ojo, Fundamentos de Física I y II, Consideraciones Ético Legales, Lentes de Contacto I y II, Despacho de Recetas, Visión Subnormal, Desarrollo Empresarial, Materiales Oftálmicos, entre otras.
Técnico de Farmacia (A.A.S.)
El programa en Ciencias Aplicadas en Técnico de Farmacia te permite llegar a ser un Técnico de Farmacia con los conocimientos y destrezas necesarias. Encontrarás cursos como: Farmacia Teórica, Legislación Farmacéutica, Posología, Anatomía y Fisiología Humanas, Farmacia Práctica I, Farmacología Aplicada I, Matemática Farmacéutica, Integración de Conceptos de Farmacia, Química General para Técnico de Farmacia, entre otros.


| AGU | BAR | INTER-MET | GUA | PON |
Tecnología Radiológica (A.A.S)
El programa fue creado para preparar tecnólogos radiológicos, los que constituyen los profesionales de la salud responsables por la ejecutoria de procedimientos radiográficos mediante el uso de equipos de radiología diagnóstica. Algunos cursos que se ofrecen en el currículo son: Protección Radiológica, Biología y Anatomía Radiográfica I, II, Cuidado del Paciente, Introducción a la Tecnología Radiológica, Principios de Exposición y Procesado Radiográfico, Medios de Contraste, Crítica y Control de Calidad Radiográfica, Procedimientos y Evaluaciones Radiográficas I, II y III, Física Radiológica I y II, entre otros.
| AGU | BAR | FAJ | INTER-HUM | PON | SG |

| PON |
76 Bachillerato Grado Asociado * Se ofrece presencial y a distancia ** Solamente se ofrece a distancia
Terapia Ocupacional (A.A.S)
El Grado Asociado en Ciencias Aplicadas en Terapia Ocupacional está diseñado para ofrecer conocimientos científicos fundamentados en conceptos y principios de las ciencias naturales, sociales y humanísticas. En Terapia Ocupacional, el ser humano es visto como un ente holístico: cuerpo, mente y espíritu. Te prepararán en: Introducción a Terapia Ocupacional, Modalidades Terapéuticas I, II, III, Sociología Ocupacional, Ocupación a través del Ciclo de Vida, Anatomía y Fisiología Aplicada, Procesos en Terapia Ocupacional, Terapia Ocupacional Aplicada a Pediatría I, II Terapia Ocupacional Aplicada a Psicosocial I, II, Disfunción Física I, II, Terapia Ocupacional en las Actividades del Diario Vivir, entre otros temas y cursos.
Ciencias en Emergencias Médicas (A.S.)
El Grado Asociado en Emergencias Médicas aspira a preparar profesionales paramédicos capaces de ofrecer cuidado prehospitalario de emergencia de forma competente, sensible, efectiva, segura y de calidad, a clientes en situaciones relacionadas con una amenaza a la salud y que ocurren por causa fortuita. Cursos de interés contenidos en el currículo de estudios: Destrezas en el Lenguaje de Señas, Conceptos y Principios Básicos de Emergencias Médicas, Patofisiología, Conceptos Básicos de Biología, Anatomía y Fisiología, Estimado del Cliente, Farmacología Aplicada, Función Cardiorrespiratorio, Sistema de Transporte y Comunicación, Operación Rescate, Manejo de Trauma y Práctica Integrada.

| BAR | INTER-CAG | SG |
Ultrasonido Diagnóstico (AAS)
El Grado de Asociado en Ciencias Aplicadas en Ultrasonido Diagnóstico desarrollara profesionales de la salud competentes en la preparación de imágenes de calidad que apoyen el diagnóstico y tratamiento de pacientes. lncluye una base de conocimientos científicos y fundamentados en conceptos y principios de ciencias naturales y destrezas de ultrasonido en las áreas de obstetricia, ginecología, abdominal y partes superficiales. A través de las experiencias clínicas, el programa desarrolla destrezas en el manejo de equipos especializados y tecnología altamente avanzada.
Los cursos de interés contenidos en el currículo del programa de estudios: Introducción a los Principios y Protocolos del Ultrasonido Diagnóstico, Anatomía y Fisiología en Ultrasonido, Cuidado del Paciente en Ultrasonido Diagnóstico , Física Básica en Ultrasonido Diagnóstico, Física Intermedia en Ultrasonido Diagnóstico, Procedimiento y Evaluación de Ultrasonido Diagnóstico de Abdomen y Pelvis, Patología Abdomino-Pelvica, Práctica en Ultrasonido I, II y III, Patología en Obstetricia y Ginecología, Procedimiento y Evaluación del Ultrasonido en Obstetricia y Ginecología, Procedimiento y Evaluación de Ultrasonido en Anatomía Superficial, Patología en Anatomia Superficial y Taller Integrador.
 | AGU |
| AGU |
PON
|
|
77 inter.edu AGU • AGUADILLA ARE • ARECIBO BAR • BARRANQUITAS BAY • BAYAMON INTER-CAG • CENTRO UNIVERSITARIO DE CAGUAS-METRO FAJ • FAJARDO GUA • GUAYAMA HUM • INTER HUMACAO MET • METRO PON • PONCE SG • SAN GERMÁN



78 SOLICITA ADMISIÓN AQUÍ admisiones.inter.edu
Comunicaciones
Comunicaciones en Relaciones Públicas y Publicidad (B.A.)
El Bachillerato en Artes en Comunicaciones provee una preparación teórica y práctica en el campo de la comunicación social, enfatizando las áreas de relaciones públicas y publicidad. Incluye el conocimiento y manejo de los medios de comunicación y destrezas administrativas, investigativas y técnicas. Cursos de interés contenidos en el currículo de estudios: Introducción a la Comunicación, Fundamentos de la Comunicación Gráfica, Introducción a los Medios de Comunicación, Redacción para los Medios de Comunicación, Comunicación y Sociedad, Procesos Investigativos en las Comunicaciones, Psicología de la Comunicación, Producción para Multimedios, Aspectos Legales y Éticos, Fundamentos de Gerencia e Introducción al Mercadeo, Fundamentos de Periodismo, Fundamentos de Relaciones Públicas, Fundamentos de Publicidad, Plan de Relaciones Públicas, Proyectos de Publicidad, Comunicación Integral de Marca, Temas de Actualidad en Comunicaciones, Internado y Seminario en Relaciones Públicas y Publicidad.


| PON |
Comunicación Corporativa (B.A.)
El programa aspira a preparar especialistas capaces de responder a los retos sociales y económicos de este campo. El currículo relaciona a los estudiantes con el diseño, la estructura, la gestión y el análisis de las estrategias de comunicación dentro del contexto corporativo interno y externo. De igual forma, aspira a desarrollar el pensamiento estratégico corporativo a la luz de las comunicaciones integradas de mercadeo. Cursos de interés contenidos en el currículo de estudios: Introducción a los Medios de Comunicación, Comunicación Corporativa, Gestión de la Comunicación Corporativa, Tendencias en la Tecnología de la Comunicación, Planificación Estratégica, Plan de Relaciones Públicas, Aspectos Legales y Éticos, Diseño Gráfico y Animación, Composición Avanzada, Redacción de Documentos Profesionales, Discurso Público, Taller de Traducción, Estadística Básica, Introducción al Mercadeo, Gerencia de Mercadeo, Comunicación Integrada de Mercadeo, Principios de Publicidad, Psicología Industrial –Organizacional, Comunicación Oral, Taller de Redacción, Redacción de Documentos Profesionales y Taller de Traducción.
Comunicación en Producción para Medios (B.S.)
El Bachillerato en Ciencias en Comunicación en Producción para Medios provee una preparación teórico-práctica en la producción de contenidos para medios. Las áreas de los medios que se estudian son: la redacción, la fotografía, el diseño gráfico, el sonido, el vídeo y la Internet. El programa, fomenta el empresarismo y tiene un énfasis en la integración de medios a tono con las tendencias en la industria de la Comunicación. Cursos de interés contenidos en el currículo de estudios: Introducción a los Medios de Comunicación, Introducción a la Producción Gráfica, Técnicas Fotográficas, Redacción Creativa para Medios, Producción Gráfica para Publicaciones, Técnicas de Producción de Sonido, Redacción Periodística para Medios, Planificación para Medios, Técnicas de Producción de Televisión, Diseño de Identidad Visual de Marcas, Iluminación de la Fotografía, Producción para la Radio, Manipulación Fotográfica Digital, Producción de Vídeo Fuera de Estudio, Producción Avanzada para Radio, Administración y Producción de Contenido para Medios Sociales, Producción de Contenidos Multimedios para Internet, Producción Avanzada de Televisión, Aspectos Legales y Éticos, Gerencia y Empresarismo para los Medios de Comunicación, Fundamentos de la Investigación para los Medios de Comunicación, Práctica Supervisada y Estadística Básica.
| BAY |
| MET |
Grado Asociado
Se ofrece presencial y a distancia
Solamente se ofrece a distancia 79 inter.edu AGU • AGUADILLA ARE • ARECIBO BAR • BARRANQUITAS BAY • BAYAMON INTER-CAG • CENTRO UNIVERSITARIO DE CAGUAS-METRO FAJ • FAJARDO GUA • GUAYAMA HUM • INTER HUMACAO MET • METRO PON • PONCE SG • SAN GERMÁN
Bachillerato
*
**
Lenguas Modernas (B.A.)
El Bachillerato en Artes en Lenguas Modernas está diseñado para desarrollar las competencias que le permitan al estudiante conocer la historia y la cultura de los países de las lenguas estudiadas. Identificar las principales corrientes literarias y los aspectos lingüísticos de las lenguas estudiadas. Expresarse en las lenguas modernas de forma oral y escrita con fluidez, propiedad y corrección, en situaciones tanto formales como informales. Cursos de interés contenidos en el currículo de estudios: Italiano I- IV, Literatura de Italia I, II, Cultura e Historia Italiana, Alemán I-IV, Literatura de Alemania I, II, Cultura e Historia Alemana, Francés I-IV, Literatura Francesa I, II, Cultura e Historia Francesa, Portugués I-IV, Literatura Portuguesa I, II, Cultura e Historia Portuguesa, Fonética y Dicción, Redacción Avanzada y Cine Europeo.
Fotografía (A.)
Este grado asociado está diseñado para proveer preparación teóricopráctica en la disciplina de la fotografía. El egresado podrá desempeñarse como un profesional en el campo fotográfico en el ámbito artístico o comercial. Los cursos de interés son Introducción a la Producción Gráfica, Técnicas Fotográficas, Producción Gráfica para Publicaciones, Teoría y Técnicas de Iluminación en la Fotografía, Manipulación Fotográfica Digital, Fotografía Avanzada, Portafolio Fotográfico, Seminario de Nuevas Tendencias en la Fotografía y Fundamento Empresarial. | BAY |


80
Comunicaciones (A.A.)
El Grado Asociado en Artes en Comunicaciones provee una preparación básica en el campo de la comunicación social, que incluye las perspectivas teóricas, tendencias emergentes, destrezas de redacción y producción, además de técnicas de investigación y desarrollo creativo. Permite que el estudiante pueda continuar hacia el Bachillerato en Artes en Comunicaciones. Tomarás cursos como: Introducción a la Comunicación, Fundamentos de la Comunicación Gráfica, Introducción a los Medios de Comunicación, Fundamentos de Periodismo, Redacción para los Medios de Comunicación, Procesos Investigativos en las Comunicaciones, Producción para Multimedios, Temas de Actualidad en las Comunicaciones, Aspectos Legales y Éticos, Introducción al Mercadeo, entre otros.

Producción y Postproducción de Sonido (A.A.S.)
El Grado Asociado en Ciencias Aplicadas en Producción y Postproducción de Sonido está diseñado para proveer una preparación teórico-práctica en el campo del sonido. El egresado podrá desempeñarse como un profesional en las áreas de producciones musicales, producción de sonido en y fuera de estudio, programación y musicalización para vídeo, así como en otras en las que debe dominar técnicas relacionadas con la producción avanzada de sonido. Cursos de interés contenidos en el currículo de estudios: Técnicas de Producción de Sonido, Locución, Fundamentos de la Música, Introducción a las Grabaciones Multicanales, Técnicas de Grabación de Sonido, Mezcla y Postproducción de Sonido, Sonido en Vivo en y fuera de Estudio, Producción Avanzada de Sonido, Seminario de Musicalización para Video, Aspectos Legales y Éticos del Sonido, Portafolio / Proyecto Final y Fundamento Empresarial.

| PON |
| BAY| 81 inter.edu AGU • AGUADILLA ARE • ARECIBO BAR • BARRANQUITAS BAY • BAYAMON INTER-CAG • CENTRO UNIVERSITARIO DE CAGUAS-METRO FAJ • FAJARDO GUA • GUAYAMA HUM • INTER HUMACAO MET • METRO PON • PONCE SG • SAN GERMÁN



ADMISIÓN AQUÍ admisiones.inter.edu 82
SOLICITA
El programa está dirigido a la formación de maestros dentro de un plan de estudio que provea un cúmulo de experiencias articuladas y que, a su vez, promueva espacios para la construcción de los conocimientos pedagógicos y de contenido que desarrollará el futuro docente. Estas experiencias se caracterizarán por la reflexión continua, la práctica en escenarios reales, la investigación, la colaboración, la pertinencia de los contenidos, el modelaje pedagógico y la búsqueda y uso de medios que permitan dar soluciones a problemas propios de los procesos de enseñanza y de aprendizaje en diferentes contextos. En este plan de estudio estarán integrados los componentes de educación general, medular y concentración.
Educación en la Niñez Temprana: Nivel Preescolar (B.A.)
Cursos de interés contenidos en el currículo de estudios: Salud, Nutrición y Primeros Auxilios, Estimulación del Lenguaje, Naturaleza y Necesidades de los Infantes y Niños de Edad Preescolar con Deficiencias en el Desarrollo, Literatura Infantil, Influencias Psico-filosóficas en los Modelos Curriculares para la Educación Temprana, Las Bellas Artes en el Proceso Educativo, Los Padres y las Madres como Educadores, Organización y Administración de Servicios a la Niñez y El Juego del Niño como Proceso de Aprendizaje.
| AGU | ARE* | INTER-CAG | FAJ | GUA | MET | SG |
Educación en la Niñez Temprana: Nivel Elemental Primario (K-3) (B.A.)
Cursos de interés contenidos en el currículo de estudios: Salud, Nutrición y Primeros Auxilios, Currículo, Enseñanza y “Assessment” de las Matemáticas en los Grados Primarios (K-3), Currículo, Enseñanza y “Assessment” de los Estudios Sociales en los Grados Primarios (K-3), Literatura Infantil, Las Bellas Artes en el Proceso Educativo, El Kindergarten en el Programa Escolar, Los Padres y las Madres como Educadores, Currículo, Enseñanza y “Assessment” del Inglés en los Grados Primarios (K-3), Lecto-escritura en los Grados Primarios, Currículo, Enseñanza y “Assessment” de las Ciencias Naturales en los Grados Primarios (K-3) y El Juego del Niño como Proceso de Aprendizaje.

AGU | ARE* | FAJ | MET | SG |
Educación en la Niñez
Temprana: Nivel Elemental (4-6) (B.A.)
Cursos de interés contenidos en el currículo de estudios: Salud, Nutrición y Primeros Auxilios, Currículo, Enseñanza y “Assessment” de las Matemáticas en el Nivel Elemental, Currículo, Enseñanza y “Assessment” de los Estudios Sociales en el Nivel Elemental, Literatura Infantil, Las Bellas Artes en el Proceso Educativo, Los Padres y las Madres como Educadores, Currículo, Enseñanza y “Assessment” del Inglés en el Nivel Elemental (4-6), Currículo, Enseñanza y “Assessment” de las Artes del Lenguaje en el Nivel Elemental (4-6), Currículo, Enseñanza y “Assessment” de las Ciencias Naturales en el Nivel Elemental (4-6) y El Juego del Niño como Proceso Educativo.
| ARE* | FAJ | MET | PON | SG |
Bachillerato Grado Asociado * Se ofrece presencial y a distancia ** Solamente se ofrece a distancia 83 inter.edu AGU • AGUADILLA ARE • ARECIBO BAR • BARRANQUITAS BAY • BAYAMON INTER-CAG • CENTRO UNIVERSITARIO DE CAGUAS-METRO FAJ • FAJARDO GUA • GUAYAMA HUM • INTER HUMACAO MET • METRO PON • PONCE SG • SAN GERMÁN
Educación Especial Interdisciplinaria (PK-12) (B.A.)
Cursos de interés contenidos en el currículo de estudios: Naturaleza y Necesidades del Estudiante con Autismo, Estimulación del Lenguaje, Naturaleza y Necesidades de los Estudiantes con Retardación Mental y Disturbios Emocionales, Naturaleza y Necesidades de los Estudiantes con Problemas Específicos de Aprendizaje, Trastorno de Déficit de Atención y Trastorno de Déficit de Atención e Hiperactividad, Naturaleza y Necesidades de los Infantes y Niños de Edad Preescolar con Deficiencias en el Desarrollo, Manejo de la Conducta en el Salón de Clases, Contenido Curricular, Diagnóstico y Tratamiento de Problemas de Aprendizaje en las Matemáticas, Contenido Curricular, Diagnóstico y Tratamiento de Problemas de Lecto-Escritura, Diseño y Desarrollo del Currículo y Materiales para Estudiantes con Discapacidades, Seminario: El Estudiante con Discapacidades y su Familia, Técnicas e Instrumentos de Evaluación (Assessment) para Estudiantes con Discapacidades, Asistencia Tecnológica, Currículo y Materiales para la Enseñanza de Estudiantes con Limitaciones.
| GUA |
Educación Elemental en Educación Especial (B.A.)
Cursos de interés contenidos en el currículo de estudios: Salud, Nutrición y Primeros Auxilios, Currículo, Enseñanza y “Assessment” en las Matemáticas en el Nivel Elemental (4-6), Currículo, Enseñanza y Assessment” de los Estudios Sociales en el Nivel Elemental (4-6), Las



Bellas Artes en el Proceso Educativo, Currículo, Enseñanza y “Assessment” del Inglés en el Nivel Elemental (4-6), Currículo, Enseñanza y “Assessment” de las Artes del Lenguaje en el Nivel Elemental (4-6), Currículo, Enseñanza y “Assessment” de las Ciencias Naturales en el Nivel Elemental (4-6). Requisitos de Subconcentración: Naturaleza y Necesidades del Estudiante con Retardación Mental y Disturbios Emocionales, Naturaleza y Necesidades de los Estudiantes con Problemas Específicos de Aprendizaje, Trastorno de Déficit de Atención y Trastorno de Déficit de Atención e Hiperactividad, Lenguaje y Lectura, Diagnóstico Educativo, Evaluación, y “Assessment” para Estudiantes con Limitaciones, Manejo de la Conducta en el Salón de Clases, Contenido Curricular, Diagnóstico y Tratamiento de Problemas de Aprendizaje en las Matemáticas, Contenido Curricular, Diagnóstico y Tratamiento de Problemas de Lectoescritura, Asistencia Tecnológica, Currículo y Materiales para la Enseñanza de Estudiantes con Limitaciones, Estrategias, Métodos y Técnicas de Enseñanza para Estudiantes con Limitaciones.
| AGU | PON |
Educación Secundaria en Español (B.A.)
Cursos de interés contenidos en el currículo de estudios: Gramática Superior, Lingüística, Taller de Redacción, Literatura Española, Literatura Hispanoamericana, Literatura Puertorriqueña, Taller de Lectura, Metodología y Técnicas de Enseñanza de la Lengua Materna.
| AGU | ARE* | SG |
Bachillerato Grado Asociado * Se ofrece presencial y a distancia ** Solamente se ofrece a distancia 84
Educación Secundaria en Biología (B.A.)
Cursos de interés contenidos en el currículo de estudios: Biología General, Laboratorio de Destrezas de Biología, Zoología, Botánica, Genética, Anatomía y Fisiología Humana, Ecología, Química General, Teorías de la Instrucción, Metodología y Recursos para la Enseñanza de la Biología, Precálculo y Física General.

| AGU | ARE | FAJ | SG |
Enseñanza del Arte (B.A.)
Cursos de interés contenidos en el currículo de estudios: Fundamentos Técnicos y Prácticas del Dibujo, Diseño, Diseño en Tres Dimensiones, Introducción a la Cerámica, Fotografía Digital, Dibujo, Pintura, Introducción al Grabado, Historia del Arte, Historia del Arte Moderno y Contemporáneo, Historia del Arte Puertorriqueño, Historia del Arte Latinoamericano y del Caribe, Obras Maestras del Arte, Arte y Tecnología y Género, Representación y las Artes Visuales.
| SG |

85 inter.edu AGU • AGUADILLA ARE • ARECIBO BAR • BARRANQUITAS BAY • BAYAMON INTER-CAG • CENTRO UNIVERSITARIO DE CAGUAS-METRO FAJ • FAJARDO GUA • GUAYAMA HUM • INTER HUMACAO MET • METRO PON • PONCE SG • SAN GERMÁN
Educación Secundaria en Estudios Sociales (B.A.)
Cursos de interés contenidos en el currículo de estudios: Introducción a la Antropología, Métodos y Técnicas de Enseñanza de Estudios Sociales, Introducción a la Geografía Cultural, Geografía de Puerto Rico, Historia de Puerto Rico, Historia de los Estados, Introducción a las Ciencias Políticas, Economía Política, Introducción a la Sociología y Problemas Sociales de Puerto Rico.
| SG |
Educación Secundaria en Matemáticas (B.A.)
Cursos de interés contenidos en el currículo de estudios: Teorías de la Instrucción, Metodología y Recursos Tecnológicos para la Enseñanza de Matemáticas en el Nivel Secundario, Precálculo, Métodos Discretos o Estructuras Computacionales Discretas, Introducción a la Probabilidad y la Estadística, Cálculo, Temas de Geometría, Teoría de Números, Álgebra, Álgebra Abstracta y Física General.
| ARE | MET | SG |
Educación Especial (B.A.)

El Bachillerato en Educación Especial tiene como principios los fundamentos, las teorías y las metodologías, pertinentes a la enseñanza en el salón de clases. Esto permitirá que el egresado pueda aplicar en el salón de clases el contenido (conocimientos, destrezas y actitudes), la metodología (estrategias, métodos y técnicas) y los modos de evaluación del aprendizaje, aprendidos durante su programa de estudios. Cursos de interés contenidos en el currículo de estudios: Naturaleza y Necesidades de los Estudiantes con Retardación Mental y Disturbios Emocionales, Naturaleza y Necesidades de los Estudiantes con Problemas Específicos de Aprendizaje, Trastorno de Déficit de Atención y Trastorno de Déficit de Atención e Hiperactividad, Lenguaje

86
y Lectura, Diagnóstico Educativo, Evaluación, y “Assessment” para Estudiantes con Limitaciones, Manejo de la Conducta en la Sala de Clases, Contenido Curricular, Diagnóstico y Tratamiento de Problemas de Aprendizaje en las Matemáticas, Contenido Curricular, Diagnóstico y Tratamiento de Problemas de Lectoescritura, Asistencia Tecnológica, Currículo y Materiales para la Enseñanza del Estudiante con Limitaciones Leves, Estrategias, Métodos y Técnicas de Enseñanza para Estudiantes con Limitaciones.

| ARE* | INTER-CAG | FAJ | MET | SG |
Educación Secundaria en Historia (B.A.)
Cursos de interés contenidos en el currículo de estudios: El Mundo Antiguo, El Mundo Medieval, El Mundo Moderno, El Mundo Contemporáneo, América Latina Colonial, América Latina desde la Independencia, Historia de Puerto Rico, Historia de los Estados Unidos, Historiografía, Investigación Histórica, Métodos y Técnicas de Enseñanza de Historia, El Caribe a partir del Siglo XVII, El África al Sur del Sahara, Asia, Rusia hasta el Siglo XIX, Rusia durante los Siglos XIX y XX, Introducción a la Geografía Cultural, Geografía Economía y Geografía Política.

| MET | SG |
Educación Especial en Autismo (B.A.)
Cursos de interés contenidos en el currículo de estudios: Naturaleza y Necesidades del Estudiante con Autismo, Aspectos Psicosociales del Estudiante con Autismo, Problemas y Métodos de Comunicación del Estudiante con Autismo, Técnicas de Diagnóstico, Evaluación y “Assessment” del Estudiante con Autismo, Currículo y Métodos de Enseñanza del Estudiante con Autismo y Manejo de la Conducta del Estudiante con Autismo.

| PON |
Educación Especial en Sordo y Sordo Parcial (B.A.)
Cursos de interés contenidos en el currículo de estudios: Naturaleza y Necesidades del Estudiante Sordo y Sordo Parcial, Lenguaje de Señas en el Contexto de la Cultura del Sordo y Sordo Parcial, Currículo, Metodología y Materiales para la Enseñanza del Estudiante Sordo y Sordo Parcial, Métodos de Enseñanza de la Lectura y Preparación de Materiales para el Estudiante Sordo y Sordo Parcial, Desarrollo del Lenguaje en los Sordos y Sordo Parcial, Teoría y Práctica, Métodos de Evaluación, Evaluación Alterna, Diagnóstico y “Assessment” del Estudiante Sordo y Sordo Parcial.
| PON |
87 inter.edu AGU • AGUADILLA ARE • ARECIBO BAR • BARRANQUITAS BAY • BAYAMON INTER-CAG • CENTRO UNIVERSITARIO DE CAGUAS-METRO FAJ • FAJARDO GUA • GUAYAMA HUM • INTER HUMACAO MET • METRO PON • PONCE SG • SAN GERMÁN
ENSEÑANZA DE INGLÉS COMO SEGUNDO IDIOMA
El programa de Enseñanza de Inglés como Segundo Idioma descansa sobre los principios fundamentales del desarrollo del ser humano que es capaz de pensar, analizar y evaluar sus procesos de aprendizaje. El egresado de este programa, por lo tanto, será capaz de autoevaluarse mediante la reflexión continua. Esto permite que el egresado de este programa pueda incorporar en su salón de clases las técnicas innovadoras para la enseñanza y evaluación del inglés como segundo idioma. Se mantendrá al tanto de las guías curriculares que le sirven de dirección y de los cambios o ajustes que deben hacerse cuando así lo exige la población estudiantil que atiende.
Enseñanza de Inglés como Segundo Idioma en el Nivel Elemental (B.A.)
Cursos de interés contenidos en el currículo de estudios: Redacción Avanzada, Introducción a la Lingüística, Discurso Público, Estructuras Fundamentales de la Gramática, Fundamentos de la Fonética, Análisis Comparativo del Inglés y del Español, Literatura Infantil, Adquisición del Inglés como Segundo Idioma y Currículo, Enseñanza y “Assessment” del Inglés en el Nivel Elemental K-6.
| AGU | FAJ | MET | PON | SG |
Enseñanza de Inglés como Segundo Idioma en el Nivel Secundario (B.A.)

Cursos de interés contenidos en el currículo de estudios: Redacción Avanzada, Introducción a la Lingüística, Discurso Público, Estructuras Fundamentales de la Gramática, Fundamentos de la Fonética, Análisis Comparativo del Inglés y el Español, Análisis de los Géneros Literarios, Literatura para Jóvenes Adultos, Adquisición del Inglés como Segundo Idioma, Currículo, Enseñanza y “Assessment” del Inglés en el Nivel Secundario 7-12.
| AGU | ARE* | MET | PON | SG
88
SALUD, EDUCACIÓN FÍSICA Y RECREACIÓN
Ofrece un variado y sólido currículo de instrucción orientado hacia el desarrollo orgánico, mental, emocional, social e intelectual de sus estudiantes. Se ofrecen programas de estudio para el Bachillerato en Artes en la Enseñanza de la Educación Física en el Nivel Elemental, en el Nivel Secundario y en Educación Física Adaptada.
Educación Física en el Nivel Elemental (B.A.)
Cursos de interés contenidos en el currículo de estudios: Juegos Educativos, Recreativos y de Integración Curricular para el Nivel Elemental, Teoría y Diseño de Programas de Educación Física en el Nivel Elemental K-6, Evaluación, Avalúo e Investigación de la Enseñanza y Aprendizaje en Educación Física K-6, Teorías Educativas y Recursos Tecnológicos para la Enseñanza de la Educación Física en el Nivel Elemental K-6.
| AGU | ARE | GUA | SG |
Educación Física en el Nivel Secundario (B.A.)
Cursos de interés contenidos en el currículo de estudios: Teoría y Diseño de Programas de Educación Física, Evaluación, Avalúo e Investigación de la Enseñanza y Aprendizaje en Educación Física, Metodología del Entrenamiento Deportivo, Teorías Educativas y Recursos Tecnológicos para la Enseñanza de la Educación Física en el Nivel Secundario.

| AGU | SG |
Educación Física Adaptada (B.A.)
Cursos de interés contenidos en el currículo de estudios: Terapia Motora para Niños con Impedimentos, Teoría y Diseño de Programas para Poblaciones Especiales, Principios de la Recreación Terapéutica, Evaluación, Avalúo e Investigación de la Enseñanza y Aprendizaje en Educación Física Adaptada, Teorías Educativas y Recursos Tecnológicos para la Enseñanza de la Educación Física Adaptada.
| SG |
Asistente de Servicios Educativos Especiales (A.A.)
El programa de Asistente de Servicios Educativos Especiales tiene como meta la formación de un asistente educativo que posea los conocimientos, las destrezas y actitudes que le permita asistir adecuadamente a un estudiante con
dificultades en el aprendizaje. Cursos de interés contenidos en el currículo de estudios: Experiencias de Campo en el Escenario Educativo, Historia y Filosofía de la Educación, Psicología del Aprendizaje, Naturaleza y Necesidades del Estudiante con Autismo, Aspectos Psicosociales del Estudiante con Autismo, Problemas y Métodos de Comunicación del Estudiante con Autismo, Población Estudiantil Excepcional, Experiencias de Campo en el Escenario Educativo, Naturaleza y Necesidades de los Estudiantes con Retardación Mental y Disturbio Emocionales, Experiencias Clínicas en el Escenario Educativo, Currículo y Método de Enseñanza del Estudiante con Autismo, Contenido Curricular, Diagnóstico y Tratamiento de Problemas de Aprendizaje en las Matemáticas y Contenido Curricular, Diagnóstico y Tratamiento de Problemas de Lecto-escritura.
PON | 89 inter.edu AGU • AGUADILLA ARE • ARECIBO BAR • BARRANQUITAS BAY • BAYAMON INTER-CAG • CENTRO UNIVERSITARIO DE CAGUAS-METRO FAJ • FAJARDO GUA • GUAYAMA HUM • INTER HUMACAO MET • METRO PON • PONCE SG • SAN GERMÁN
|
Informática y Tecnología Informática y Tecnología



SOLICITA ADMISIÓN AQUÍ admisiones.inter.edu 90
Tecnología de la Información (B.B.A.)
El programa ha sido diseñado para propiciar un entendimiento cabal de las metas, funciones y operaciones de las organizaciones empresariales y de las necesidades de información y el papel de la tecnología de la información en dichas organizaciones. Cursos de interés contenidos en el currículo de estudios: Introducción a la Tecnología de la Información, Algoritmos de Programación, Programación Visual en Sistemas de Información, Introducción a la Internet en la Empresa, Programación de Aplicaciones Móviles, Diseño y Manejo de Bases de Datos, Telecomunicaciones y Redes en los Negocios, Análisis y Diseño de Sistemas de Información, Programación de Internet, Auditoría y Seguridad de los Sistemas de Información, Práctica, Proyecto y Seminario en Sistemas de Información.

Tecnología de Ingeniería Electrónica (B.S.)
El programa en Tecnología de Ingeniería Electrónica está diseñado para desarrollar en los estudiantes los conocimientos y las destrezas del campo de la electrónica, de modo que al terminar el currículo sean profesionales competentes en uno de los campos de mayor demanda en la industria y el gobierno.
Cursos de interés contenidos en el currículo de estudios: Seguridad Industrial, Laboratorio de Circuitos Lógicos, Circuitos Lógicos, Dibujo Electrónico, Laboratorio de Circuitos Electrónicos, Circuitos Electrónicos, Laboratorio de Electrónica Industrial, Electrónica Industrial, Laboratorio de Comunicaciones, Comunicaciones, Laboratorio de Instrumentación y Tecnología de Control, Precálculo, Cálculo y Física para Ingenieros.
| AGU | SG |
Redes y Telecomunicaciones (B.S.)

El programa de Redes y Telecomunicaciones ofrece los más avanzados cursos en el campo de las redes de datos, telecomunicaciones, ambientes de recursos computadorizados compartidos mediante redes corporativas y administración de dichos sistemas basados en las plataformas Windows, Netware, Linux, IBM iSeries y Cisco, entre otros. Cursos de interés contenidos en el currículo de estudios: Introducción a las Redes y Telecomunicaciones, Protocolos de Redes, Diseño de Distribución de Telecomunicaciones, Redes Linux, Instalación y Administración de Sistemas de Redes, Introducción a la Programación en JAVA, Servidor de Correo Electrónico, Operaciones de Minicomputadoras, Administración y Programación de Internet, Servidor de Bases de Datos SQL, Redes Inalámbricas, Temas Especiales en Telecomunicaciones, Seguridad en las Redes, Auditoría y Controles en Sistemas de Redes, Redes de Voz y Vídeo, Redes de Almacenamiento, Administración de Redes, Práctica en Telecomunicaciones, Introducción a la Contabilidad Financiera, Fundamentos de Gerencia, Introducción a la Tecnología de la Información, Algoritmos de Programación, Fundamentos de Métodos Cuantitativos e Introducción al Mercadeo.

| *PON |
* Se ofrece presencial y a distancia ** Solamente se ofrece a distancia
AGU* | SG |
|
Grado
Bachillerato
Asociado
91 inter.edu AGU • AGUADILLA ARE • ARECIBO BAR • BARRANQUITAS BAY • BAYAMON INTER-CAG • CENTRO UNIVERSITARIO DE CAGUAS-METRO FAJ • FAJARDO GUA • GUAYAMA HUM • INTER HUMACAO MET • METRO PON • PONCE SG • SAN GERMÁN
Diseño Gráfico Digital y Multimedios (B.S.)
El Bachillerato en Ciencias en Diseño Gráfico Digital y Multimedios provee al estudiante los principios, conceptos y prácticas de la industria de la publicidad y de las comunicaciones. Se fundamenta en el desarrollo de profesionales de la comunicación visual dirigida a manejar nuevas formas de ofrecer servicios, planificar, diseñar y comunicar ideas y mensajes gráficos claros y efectivos.


Cursos de interés contenidos en el currículo de estudios: Historia del Diseño Gráfico, Fundamentos del Diseño Gráfico, Análisis de los Medios Gráficos, Fotografía Digital Aplicada al Diseño Gráfico, Diseño Gráfico Digital, Diseño y Composición Tipográfica Gráfica y Digital, Introducción al Diseño de Multimedios, Semiótica y la Comunicación Gráfica, Redacción para el Formato Digital y Producción de Vídeos, Diseño de Identidad Corporativa e Identidad Visual, Diseño de Empaques y Exhibidores, Principios de Animación, Diseño y Producción de Multimedios, Diseño y Producción Multimedios, Principios Éticos y Legales de la Comunicación Gráfica, Administración y Mercadeo de Medios Gráficos, Seminario Profesional, Diseño y Producción de Portafolio Profesional Digital, Seminario Campaña Publicitaria, Diseño Editorial, Animación y Gráfica Tridimensional (3D) y Práctica.
| AGU | FAJ |
Matemáticas (B.S.)
El Bachillerato en Ciencias en Matemáticas es un programa dirigido a la formación de profesionales comprometidos con el servicio y con la disciplina que han seleccionado. Propone preparar profesionales competentes que posean una base teórica y que estén familiarizados con métodos de investigación en matemáticas, así como, en las áreas de aplicación matemáticas. Cursos de interés contenidos en el currículo de estudios: Precálculo, Métodos Discretos, Introducción a la Probabilidad y la Estadística, Cálculo, Estadística Matemática, Álgebra
Lineal, Ecuaciones Diferenciales, Seminario Integrador, Introducción a las Ciencias de Cómputos, Lógica de Programación. Requisitos de Concentración en Matemáticas Puras: Análisis Numérico, Álgebra Abstracta, Cálculo Avanzado, Química General y Física General.
| SG | 92 Bachillerato Grado Asociado * Se ofrece presencial y a distancia ** Solamente se ofrece a distancia
Desarrollo de Aplicaciones (B.S.)
El Bachillerato en Ciencias en Desarrollo de Aplicaciones ofrece una preparación teórica y práctica dirigida a desarrollar profesionales centrados en las áreas técnicas con conocimiento de manejo de datos para las empresas. Propicia, además, destrezas en desarrollo de aplicaciones, análisis para la solución de problemas, manejo de bases de datos, redes de computadoras y su seguridad y el manejo de herramientas para poder manipular la información en las empresas.
Cursos de interés contenidos en el currículo de estudios: Desarrollo de Páginas Web, Lógica de Programación, Programación Estructurada, Programación Orientada a Objetos, Estructuras Computacionales Discretas, Bases de Datos, Estructura de Datos, Ingeniería de Software, Programación Web con Base de Datos, Computación Móvil, Computación en la Nube y Seguridad Computacional. |

Tecnología de Computadoras y Redes (B.S.)
El Bachillerato en Ciencias en Tecnología de Computadoras y Redes contiene un currículo moderno que atempera los conocimientos, teorías, técnicas y prácticas en el campo de la Administración de las Redes. Cursos de interés contenidos en el currículo de estudios: Programas de Computadoras, Electrónica, Matemáticas de Computadoras, Comunicación de Datos, Sistemas Operativos de Microcomputadoras, Administración de Redes, Electrónica de Microprocesadores, Instalación y Configuración de Programas en Microcomputadoras y Redes, Instalación de Redes, Ensamblaje y Mantenimiento Técnico de Computadoras Personales, Diseño, Mantenimiento y Servicio de Redes, Arquitectura de Sistemas Computadorizados, Análisis y Diseño de Bases de Datos, Análisis y Diseño de Sistemas Computadorizados, Creación de Presentaciones y Publicaciones Electrónicas, Seguridad en las Redes, Temas Emergentes en la Tecnología de Redes, Gerencia de Sistemas de Información, Internado y Gerencia y Organización Comercial.

| AGU | BAY | FAJ | GUA |

BAY |
93 inter.edu AGU • AGUADILLA ARE • ARECIBO BAR • BARRANQUITAS BAY • BAYAMON INTER-CAG • CENTRO UNIVERSITARIO DE CAGUAS-METRO FAJ • FAJARDO GUA • GUAYAMA HUM • INTER HUMACAO MET • METRO PON • PONCE SG • SAN GERMÁN
Diseño y Desarrollo de Videojuegos (B.S.)

El Bachillerato en Ciencias en Diseño y Desarrollo de Videojuegos ofrece al estudiante una preparación teórica y práctica adecuada para el complejo y competitivo mundo de la industria de videojuegos. Las destrezas y técnicas aprendidas en este programa ayudarán al estudiante a diseñar y desarrollar herramientas (videojuegos) que ayuden a los demás en diferentes ámbitos de sus vidas como lo son la educación, el aprendizaje, la salud, la cohesión familiar, la expresión artística, y la adquisición de conciencia social. Cursos de interés contenidos en el currículo de estudios: Introducción a las Ciencias de Cómputos, Lógica de Programación, Programación Visual, Programación Estructurada, Programación Orientada a Objetos, Estructuras Computacionales Discretas, Estructuras de Datos, Ingeniería de “software”, Precálculo, Cálculo, Física para Videojuegos, Diseño de Videojuegos, Programación de Videojuegos, Gráficas de Videojuegos, Proyecto de Diseño, Desarrollo y Publicación de un Videojuego en Computadoras, Ingeniería de “Software”, Sistemas Operativos, Computación Visual, Teleprocesamiento y Redes, Desarrollo e Implementación de Sistemas, Seguridad Computacional, Práctica y Ética Profesional, Precálculo, Cálculo y Física General. |

Ciencias en Computadoras (B.S.)
El programa ofrece una preparación teórica y práctica dirigida a desarrollar profesionales centrados en el dominio del conocimiento relacionado con las áreas técnicas y diversificadas de la disciplina. Propicia, además, el desarrollo de destrezas de razonamiento lógico, análisis para solución de problemas, metodologías de programación y uso de herramientas asociadas al campo de la computación. Cursos de interés contenidos en el currículo de estudios: Desarrollo de Páginas Web, Lógica de Programación, Programación Estructurada, Programación Orientada a Objetos, Estructuras Computacionales Discretas, Bases de Datos, Estructuras de Datos, Programación Web con Bases de Datos, Organización y Arquitectura.
| AGU* | ARE | BAR | BAY | FAJ | MET | PON | SG |
Informática Forense (B.S.)

El Bachillerato en Ciencias en Informática Forense presenta un currículo de naturaleza interdisciplinaria, que pretende desarrollar en el estudiante los conocimientos y las destrezas fundamentales para recolectar, manejar y preservar la evidencia digital. Cursos de interés contenidos en el currículo de estudios: Introducción a las Ciencias Forenses, Seguridad en las Redes Informáticas, Seguridad Computacional, Evidencia Digital, Temas Especiales, Análisis de Multimed, Investigación Forense, Práctica Forense y Seminario Integrador.
| BAY |
BAR | BAY | FAJ | INTER-PAN |
94 Bachillerato
* Se
** Solamente
Grado Asociado
ofrece presencial y a distancia
se ofrece a distancia
Seguridad Cibernética (“Cybersecurity”)

El Bachillerato en Ciencias en Seguridad Cibernética (Cybersecurity) presenta un currículo de formación teórica y destrezas prácticas en aspectos técnicos, de sistemas computadorizados, aspectos humanos, organizativos y sociales de la seguridad cibernética que le permitirán al egresado desempeñarse en diversas áreas del campo de la informática. Contiene un enfoque innovador e interdisciplinario enfocado en la protección de sistemas. Se enfatiza la seguridad en sistemas computadorizados, redes, programas y datos contra el acceso, cambio o destrucción autorizados o no autorizados de información. Cursos de interés contendidos en el currículo de estudios: Introducción a la Seguridad Cibernética, Forense Cibernético (Cyber-Forensics), Temas Especiales en Seguridad Cibernética, Hackeo
Cibernético (Ethical Hacking), Economía en la Ciberseguridad, Proyecto Práctico (Capstone Project), Lógica de Programación Programación Estructurada, Programación Orientada a Objetos , Estructuras Computacionales Discretas I, Bases de Datos, Estructuras de Datos, Programación Web con Bases de Datos, Comunicación de Datos, Sistemas Operativos de Microcomputadoras, Administración de Redes, Instalación de Redes y Configuración de Routers y Switches, Diagnóstico, Mantenimiento y Servicio de Redes, Seguridad en las Redes, Criptografía, Probabilidad y Estadísticas Precálculo, Cálculo I y II, Ingeniería de “Software”, Computación Móvil, Inteligencia Artificial, Temas Emergentes en la Tecnología de Redes, Seguridad en las Redes Informáticas, Seguridad Computacional, Física General I e Internet de las Cosas (Internet of Things (IoT).
 | BAY |
| BAY |
95 inter.edu AGU • AGUADILLA ARE • ARECIBO BAR • BARRANQUITAS BAY • BAYAMON INTER-CAG • CENTRO UNIVERSITARIO DE CAGUAS-METRO FAJ • FAJARDO GUA • GUAYAMA HUM • INTER HUMACAO MET • METRO PON • PONCE SG • SAN GERMÁN
Ciencias de Computadoras (A.A.S.)
El programa ofrece una preparación teórica y práctica dirigida a desarrollar profesionales centrados en el dominio del conocimiento relacionado con las áreas técnicas y diversificadas de la disciplina. Propicia, además, el desarrollo de destrezas de razonamiento lógico, análisis para solución de problemas, metodologías de programación y uso de herramientas asociadas al campo de la computación. El Grado de Asociado en Ciencias Aplicadas en Ciencias de Computadoras logra que aprendas a diseñar e implementar programas en lenguajes de alto nivel. Aplicarás los conocimientos de computación y los conceptos matemáticos a la solución de problemas propios de la disciplina. Utilizarás las metodologías, herramientas y técnicas para la planificación, el diseño e implementación de proyectos en las áreas de Ciencias de Computadoras. Incluye el desarrollo de páginas web, computación móvil, lógica de programación, programación estructurada y orientada a objetos y base de datos, entre otros.
Tecnología de Computadoras y Redes (A.A.S.)
El Grado Asociado en Tecnología de Computadoras y Redes contiene un currículo que atempera los conocimientos, teorías, técnicas y prácticas en el campo de la administración de las redes con las tecnologías actuales y emergentes. Cursos de interés contenidos en el currículo de estudios: Introducción a las Redes y Telecomunicaciones, Protocolos de Redes, Diseño de Distribución de Telecomunicaciones, Redes Linux, Instalación y Administración de Sistemas de Redes, Introducción a la Programación en JAVA, Servidor de Correo Electrónico, Operaciones de Minicomputadoras, Administración y Programación de Internet, Servidor de Bases de Datos SQL, Redes Inalámbricas, Temas Especiales en Telecomunicaciones, Seguridad en las Redes, Auditoría y Controles en Sistemas de Redes, Redes de Voz y Vídeo, Redes de Almacenamiento, Administración de Redes, Práctica en Telecomunicaciones, Introducción a la Contabilidad Financiera, Fundamentos de Gerencia, Introducción a la Tecnología de la Información, Algoritmos de Programación, Fundamentos de Métodos Cuantitativos e Introducción al Mercadeo.



| AGU* | ARE | BAR | BAY | FAJ | PON | SG |
| AGU | BAY | FAJ | GUA | 96 Bachillerato Grado Asociado * Se ofrece presencial y a distancia ** Solamente se ofrece a distancia
Tecnología de Ingeniería Electrónica (A.S.)
El Grado Asociado en Ciencias de Tecnología de Ingeniería Electrónica está diseñado para brindar al estudiante las destrezas y los conocimientos necesarios para poder competir exitosamente en el campo de la electrónica, tanto en la industria como en el gobierno. A su vez, el programa tiene el propósito de preparar a los estudiantes a proseguir estudios de bachillerato en el área de la electrónica. Aprenderás sobre Seguridad Industrial, Laboratorio de Circuitos Lógicos, Dibujo Electrónico, Laboratorio de Circuitos Eléctricos I y II, Circuitos Eléctricos I y II, entre otros.
| AGU | SG |
Videojuegos y Aplicaciones Móviles (A.A.S.)
El Grado Asociado en Ciencias Aplicadas de Videojuegos y Aplicaciones Móviles aspira formar a los estudiantes con las actitudes, conocimientos y destrezas en los procesos de diseño y programación de aplicaciones y videojuegos para dispositivos móviles. El estudiante integrará las ciencias de la programación multiplataforma con el arte del diseño de los elementos digitales esenciales en los videojuegos. Además, desarrollará las capacidades cognitivas, creativas y éticas necesarias para adaptarse al cambiante mundo de los dispositivos móviles. Los cursos de interes son:
Tecnologías de Dispositivos Móviles, Lenguajes de Programación, Artes Visuales Digitales, Diseño de Interfaz de Usuario, Matemática y Física para Videojuegos, Programación de Aplicaciones, Desarrollo y Narrativa Digital, Programación de Videojuegos, Computación en la Nube, Inteligencia Artificial y Trabajo Creativo.
Tecnología de Energía Renovable con Sistemas Fotovoltaicos (A.A.S.)

El Grado de Asociado en Ciencias Aplicadas en Tecnología de Energía Renovable con Sistemas Fotovoltaicos contiene curses que atemperan los conocimientos teóricoprácticos en el área, coma alternativa de energía verde. Las energías renovables son aquellas que se obtienen a partir de fuentes naturales que producen energía de forma inagotable e indefinida. Un sistema fotovoltaico es el resultado de la agrupación y el trabajo en conjunto de ciertos componentes eléctricos para lograr la transformación de la energía solar en energía eléctrica utilizable. Este tipo de energía renovable es una gran alternativa de reserva que puede ser muy útil en campos coma la salud, la alimentación, la educación, las telecomunicaciones, entre otros. Cursos de interés contenidos en el currículo de estudios: Introducción a las Energías Renovables, Dibujo Técnico, Componentes Sistemas de Energía Sola, Diseño y Dimensionamiento Sistemas de Energía Solar, Seguridad Industrial, Circuitos Eléctricos I y II, Electrónica, Física General, Precálculo y Fundamentos de Gerencia.
Tecnología de Ingeniería en Energía Renovable (A.S.)
El Grado de Asociado en Ciencias en Tecnología de Ingeniería en Energía Renovable contiene un curricular que atempera los conocimientos generales sobre las fuentes de energía renovable. El programa este diseñado para que el estudiante aprenda a evaluar la viabilidad económica de un sistema de generación de energía renovable, realizar una auditoria energética, y pueda diseñar e instalar sistemas fotovoltaicos, y éticos. Este programa preparara al estudiante para aspirar a la certificación que confiere la organización "North American Board of Certified Energy Practioners" (NABCEP). La preparación del estudiante, comprometido con su desarrollo continua y la conservación de la media ambiente, se forja con solidos principios éticos y morales. Al completar este Grado de Asociado el estudiante podrá optar para continuar un Bachillerato en áreas relacionadas. Los cursos de interés contenidos en el currículo del programa de estudios: Laboratorio de Circuitos Digitales I, Circuitos Digitales I, Circuitos Eléctricos II, Laboratorio de Circuitos eléctricos II, Circuitos Eléctricos I, Laboratorio de Circuitos eléctricos I, Laboratorio de Circuitos Electrónicos II, Circuitos Electrónicos I, Sistemas Eléctricos, Precálculo, Introducción a Sistemas de Energias Renovables, Auditoría y Eficiencia Enérgetica, Sistemas Eólicos Y Práctica Integrada y Etica Profesional. |
| GUA |
| FAJ |
97 inter.edu AGU • AGUADILLA ARE • ARECIBO BAR • BARRANQUITAS BAY • BAYAMON INTER-CAG • CENTRO UNIVERSITARIO DE CAGUAS-METRO FAJ • FAJARDO GUA • GUAYAMA HUM • INTER HUMACAO MET • METRO PON • PONCE SG • SAN GERMÁN
AGU |




ADMISIÓN AQUÍ
98
SOLICITA
admisiones.inter.edu
Ciencias Sociales (B.A.)
El programa provee una visión programática flexible, innovadora, que promueve el desarrollo integral del estudiante para desarrollar sus capacidades cognoscitivas y creativas, así como el juicio crítico necesario para desempeñarse en el mundo contemporáneo. Cursos de interés contenidos en el currículo de estudios: Los estudiantes tomarán 38 créditos de concentración seleccionados entre las siguientes disciplinas: sociología, antropología, arqueología, criminología, ciencia política y desarrollo comunitario, estudios de género y estudios culturales, entre otras. Los requisitos de concentración se establecerán en acuerdo entre el estudiante y el consejero académico con la aprobación del director de departamento.



| MET |
Ciencias Políticas (B.A.)
La misión del programa de Ciencias Políticas es proveer a los estudiantes la base teórica y filosófica de los principios políticos y las destrezas necesarias para analizar e interpretar los problemas políticos. Cursos de interés contenidos en el currículo de estudios: Introducción a las Ciencias Políticas, Gobierno de los Estados Unidos, Gobierno del Estado Libre Asociado de Puerto Rico, Análisis Político y Técnicas de Investigación, Economía Política, Gobierno y Política Comparados, Pensamiento Político Clásico y Moderno, Sistemas Políticos de Latinoamérica, Relaciones entre Estados Unidos y Puerto Rico, Gerencia Gubernamental, Procesos Electorales, Política Pública y Derecho, Seminario de Investigación Política y Relaciones Internacionales.
| MET | SG |
Grado Asociado
Bachillerato
* Se ofrece presencial y a distancia
** Solamente se ofrece a distancia
99 inter.edu AGU • AGUADILLA ARE • ARECIBO BAR • BARRANQUITAS BAY • BAYAMON INTER-CAG • CENTRO UNIVERSITARIO DE CAGUAS-METRO FAJ • FAJARDO GUA • GUAYAMA HUM • INTER HUMACAO MET • METRO PON • PONCE SG • SAN GERMÁN
Ciencias Naturales


100
SOLICITA ADMISIÓN AQUÍ admisiones.inter.edu
Ciencias Marinas (B.S.)
El Bachillerato en Ciencias en Ciencias Marinas presenta un currículo de naturaleza interdisciplinaria, que aspira a desarrollar en el estudiante los conocimientos, destrezas y actitudes fundamentales de las ciencias marinas y la aplicación de estas a la investigación ambiental científica, al manejo de recursos marinos, al uso responsable de estos y a la conservación de los ecosistemas marinos y costeros. Cursos de interés contenidos en el currículo de estudios: Fundamentos de la Oceanografía, Introducción a la Geología, Biología Marina, Laboratorio de Biología Marina, Oceanografía Avanzada, Métodos de la Investigación y Conservación y Manejo de Recursos Marinos.

Ciencias Naturales (B.S.)
El programa provee una visión programática flexible, innovadora que promueve el desarrollo integral del estudiante para desarrollar sus capacidades cognoscitivas y creativas, así como el juicio crítico necesario para desempeñarse en el mundo contemporáneo. Cursos de interés contenidos en el currículo de estudios: Los estudiantes tomarán 31 créditos de concentración seleccionados entre las siguientes disciplinas: Biología (BIOL), Química (CHEM), Matemáticas (MATH) o Ciencias de Computadoras (COMP). Los requisitos de concentración se establecerán en acuerdo entre el estudiante y el consejero académico con la aprobación del director de departamento.
| AGU | BAY | MET |
Ciencias en Química Aplicada (B.S.)
El Bachillerato en Ciencias en Química Aplicada presenta un currículo interdisciplinario que aspira a desarrollar en el estudiante las destrezas fundamentales para la aplicación de los principios y de las teorías de la química en la industria y laboratorios de investigación. Todo estudiante deberá tomar los créditos requeridos en una de las subconcentraciones: Química Forense, Nanotecnología o Bioquímica. Los cursos de interes son: Fundamentos de Química Aplicada, Química Orgánica, Química Analítica, Química Física: Termodinámica, Química Física: Cuántica y Cinética, Análisis Instrumental, Bioquímica y Química Inorgánica Avanzada.
→ Subconcentración en Bioquímica
Los cursos de interés son: Genética, Biología Celular y Molecular, Bioquímica y Métodos de Investigación en Bioquímica.
→ Subconcentración en Nanotecnología
Los cursos de interés son: Química de Nanomateriales, Nanomedicina, Nanotoxicología y Métodos de Investigación en Nanotecnología.
→ Subconcentración en Química Forense
Los cursos de interés son: Química Forense, Investigación Forense y Toxicología Forense.
| PON |
Ciencias en Toxicología (B.S.)

El Bachillerato en Ciencias en Toxicología aspira a desarrollar profesionales desde una perspectiva multidisciplinaria. Enfoca el estudio de las Ciencias en Toxicología y la investigación científica con el propósito de buscar soluciones a problemas en el campo de la toxicología. Los cursos de interés son: Fundamentos Biológicos de la Toxicología, Métodos en Toxicología, Introducción a la Toxicología, Introducción a la Farmacología, Toxicología Genética, Toxicología Clínica, Toxicología Ambiental y Avalúo de Riesgo, Salud Pública para Toxicólogos, Toxicología Molecular y Práctica.
* Se ofrece presencial y a distancia
** Solamente se ofrece a distancia
| BAY |
Bachillerato Grado Asociado
| AGU |
101 inter.edu AGU • AGUADILLA ARE • ARECIBO BAR • BARRANQUITAS BAY • BAYAMON INTER-CAG • CENTRO UNIVERSITARIO DE CAGUAS-METRO FAJ • FAJARDO GUA • GUAYAMA HUM • INTER HUMACAO MET • METRO PON • PONCE SG • SAN GERMÁN
Ingeniería



AQUÍ admisiones.inter.edu 102
SOLICITA ADMISIÓN
Preingeniería
El programa de Preingeniería permite al estudiante comenzar sus estudios de Ingeniería en los recintos de la Universidad Interamericana. El programa recalca en la preparación en matemáticas, ciencias e idiomas. Cursos de interés contenidos en el currículo de estudios: Química General para Ingenieros, Introducción a la Ingeniería, Introducción a la Ingeniería de Computación, Precálculo y Cálculo. |
Ingeniería Arquitectónica (B.S.)
El Bachillerato en Ciencias en Ingeniería Arquitectónica tiene como misión formar ingenieros capaces de analizar, diseñar, desarrollar y mantener todos los sistemas de ingeniería relacionados con las edificaciones arquitectónicas, tales como sistemas estructurales, eléctricos y mecánicos. Cursos de interés contenidos en el currículo de estudios: Arquitectura y Tecnología de la Construcción, Química General para Ingenieros, Introducción a la Ingeniería Sostenible, Física General para Ingenieros, Ecuaciones Diferenciales, Mecánica Vectorial para Ingenieros: Estática y Dinámica, Introducción a la Ingeniería de Computación, Gráficas de Ingeniería Computadorizadas, Mecánica Vectorial para Ingenieros: Dinámica, Termodinámica, Mecánica de Fluidos y sus Aplicaciones, Fundamentos de Ingeniería Eléctrica, Mecánica de Solidos, Probabilidad y Estadísticas, Algebra Lineal, Materiales de Ingeniería Arquitectónica, Análisis Estructural, Ingeniería de la Construcción, Aire Acondicionado y Refrigeración, Análisis Estructural por Computadora, Diseño de Sistemas Eléctricos, Dinámica Estructural, Diseño de Sistemas de Calefacción, Ventilación y Aire Acondicionado, Diseño de Estructuras en Hormigón, Diseño de Estructuras en Acero, Sistemas de Protección contra Incendios, Sistemas de Iluminación y Mecánica de Suelos y Fundaciones.


Ingeniería de Computadoras (B.S.)
El programa comprende el estudio y la aplicación de la teoría, principios y práctica de la ingeniería eléctrica y las matemáticas para resolver problemas que envuelvan el diseño de computadoras, dispositivos y programas que interactúan con usuarios y entre sí. El programa de Ingeniería de Computadoras está acreditado por la “Engineering Accreditation Commision” de la “Accreditation Board for Engineering and Technology (ABET)” (www.abet. org). Cursos de interés contenidos en el currículo de estudios: Introducción a la Programación, Programación Avanzada, Matemáticas Discretas para Ingeniería de Computadoras, Diseño y Construcción de “Software”, Sistemas Operativos, Arquitectura de Computadoras, Circuitos Eléctricos, Electrónica, Circuitos Lógicos, Señales y Sistemas, Microcontroladores, Diseño de Sistemas Digitales, Comunicación Análoga y Proyecto de Diseño en Ingeniería Eléctrica y Computadoras.
| BAY |
AGU | ARE | BAR | FAJ | GUA | MET | PON | SG |
| BAY |
Bachillerato Grado Asociado * Se ofrece presencial y a distancia ** Solamente se ofrece a distancia 103 inter.edu AGU • AGUADILLA ARE • ARECIBO BAR • BARRANQUITAS BAY • BAYAMON INTER-CAG • CENTRO UNIVERSITARIO DE CAGUAS-METRO FAJ • FAJARDO GUA • GUAYAMA HUM • INTER HUMACAO MET • METRO PON • PONCE SG • SAN GERMÁN
Ingeniería Eléctrica (B.S.)
El Bachillerato en Ciencias en Ingeniería Eléctrica (BSEE) comprende el estudio y diseño de sistemas de producción, transmisión y medición de señales eléctricas. Énfasis al análisis, diseño, implementación y prueba de estos sistemas. El programa de Ingeniería Eléctrica está acreditado por la “Engineering Accreditation Commision” de la “Accreditation Board for Engineering and Technology (ABET)” (www.abet.org).
Cursos de interés contenidos en el currículo de estudios: Circuitos Eléctricos, Electrónica, Circuitos Lógicos, Electromagnética, Señales y Sistemas, Microcontroladores, Instrumentación y Medición, Análisis de Sistemas de Potencia, Electric Machines and Drives, Sistemas de Control, Comunicación Análoga y Proyecto de Diseño en Ingeniería Eléctrica y Computadoras.
| BAY |
Ingeniería Industrial (B.S.)
El Bachillerato en Ciencias en Ingeniería Industrial comprende el estudio de sistemas compuestos por personas, materiales y equipo. El programa hace hincapié en el diseño, mejoramiento e instalación de estos sistemas con el propósito de aumentar su productividad, rentabilidad y efectividad. El programa de Ingeniería Industrial está acreditado por la “Engineering Accreditation Commission” de la “Accreditation Board for Engineering and Technology (ABET)” (www.abet. org). Cursos de interés contenidos en el currículo de estudios: Optimización, Estadística Avanzada, Análisis y Control de Costos, Simulación de Sistemas, Medición del Trabajo, Temas en Ingeniería Industrial, Medición y Análisis de Calidad, Ergonomía y Diseño de Estaciones de Trabajo. Control y Planificación de Operaciones, Diseño de Instalaciones, Seguridad Industrial, Gerencia de Proyectos, Manufactura Automatizada, Diseño de Experimentos, Experiencias de Diseño Comprensivo, Seminario en Ingeniería Industrial y Procesos de Manufactura.
 | BAY |
| BAY |
104 Bachillerato Grado Asociado * Se ofrece presencial y a distancia ** Solamente se ofrece a distancia
Ingeniería Mecánica (B.S.)
El Bachillerato en Ciencias en Ingeniería Mecánica comprende el estudio de la transformación de energía en una forma en la cual pueda ser controlada y utilizada en la producción de bienes y servicios. El programa de Ingeniería Mecánica está acreditado por la “Engineering Accreditation Commission” de la “Accreditation Board for Engineering and Technology (ABET)” (www.abet. org).



Cursos de interés contenidos en el currículo de estudios: Mecánica Vectorial para Ingenieros: Estática, Dinámica, Mecánica de Fluidos, Mecánica de Sólidos, Métodos Numéricos para Ingenieros, Vibraciones Mecánicas, Diseño de Mecanismos, Diseño de Elementos de Máquinas, Procesos de Manufactura, Termodinámica, Transferencia de Calor, Materiales de Ingeniería, Análisis de Ingeniería Asistido por Computadora, Mediciones, Mecánicas e Instrumentación, Sistemas de Control Automático y Proyecto de Diseño en Ingeniería Mecánica. | BAY |

105 inter.edu AGU • AGUADILLA ARE • ARECIBO BAR • BARRANQUITAS BAY • BAYAMON INTER-CAG • CENTRO UNIVERSITARIO DE CAGUAS-METRO FAJ • FAJARDO GUA • GUAYAMA HUM • INTER HUMACAO MET • METRO PON • PONCE SG • SAN GERMÁN



SOLICITA ADMISIÓN AQUÍ admisiones.inter.edu 106
Administración de Sistemas de Aviones (Piloto Profesional) (B.S.)


Esta concentración está diseñada para preparar pilotos profesionales con una base sólida de destrezas y teoría de vuelo, meteorología y seguridad. El programa cubre los requisitos establecidos por la Administración Federal de Aviación (FAA) para preparar a los estudiantes para obtener los certificados de Piloto Privado, Piloto Comercial Monomotor y Multimotor, la capacitación de Vuelo por Instrumentos y los Certificados de Instructor de Vuelo Inicial, Instructor de Vuelo por Instrumentos e Instructor de Vuelo Multimotor. Cursos de interés contenidos en el currículo de estudios: Teoría de Piloto Privado, Laboratorio de Vuelo para Piloto Privado, Vuelo por Instrumentos, Piloto Comercial, Principios de Control de Tráfico
Aéreo, Operaciones de Líneas Aéreas, Meteorología en Aviación, Sistemas de Aviones, Aerodinámica
Aplicado, Instructor de Vuelo, Técnicas de Adiestramiento para Tripulación de Vuelo (CRM Training), Instructor de Vuelo por Instrumentos, Instructor de Vuelo Multimotor, Piloto Comercial de Helicóptero. |
Gerencia de Aviación (B.S.)

Esta concentración prepara al estudiante para que pueda desempeñar funciones gerenciales o administrativas relacionadas con la industria de la transportación aérea. Cursos de interés contenidos en el currículo de estudios: Fundamentos de la Aviación, Gerencia de Aviación, Gerencia Estratégica de la Aviación, Introducción a la Contabilidad Financiera, Administración de Recursos Humanos, Sistemas de Información en los Negocios, Economía Gerencial, Gerencia de Operaciones, Finanza Gerencial, Servicios al Pasajero de Aerolíneas, Principios de Control de Tráfico Aéreo, Administración de Carga Aérea, Fundamentos de Finanzas de Líneas Aéreas, Administración de Negocios de Aviación General, Aviación y Comercio Internacional, Práctica en Transportación Aérea.
Piloto Comercial (A.A.)

El Grado Asociado en Ciencias Aplicadas en Piloto Comercial tiene como meta la formación de profesionales que posean los conocimientos, las destrezas y las actitudes que les permitan ejercer como piloto comercial. Cursos de interés contenidos en el currículo de estudios: Historia del Arte, Introducción a la Aeronáutica y Espacio, Piloto Privado, Dominio del Inglés para Profesionales de la Aviación, Vuelo por Instrumentos, Piloto Comercial, Leyes de la Aviación, Principios de Control de Tráfico Aéreo, Seguridad en Aviación, Desarrollo Profesional de la Industria Aeroespacial, Meteorología en Aviación y Factores Humanos en la Aviación.
Grado Asociado
Bachillerato
* Se ofrece presencial y a distancia
** Solamente se ofrece a distancia
107 inter.edu AGU • AGUADILLA ARE • ARECIBO BAR • BARRANQUITAS BAY • BAYAMON INTER-CAG • CENTRO UNIVERSITARIO DE CAGUAS-METRO FAJ • FAJARDO GUA • GUAYAMA HUM • INTER HUMACAO MET • METRO PON • PONCE SG • SAN GERMÁN
BAY |
Empresarismo y Negocios



SOLICITA ADMISIÓN AQUÍ admisiones.inter.edu
108
Desarrollo Empresarial y Gerencial (B.B.A.)
El Bachillerato en Desarrollo Empresarial y Gerencial está diseñado para proveer al estudiante conocimientos de los principios que rigen el desarrollo de empresa y las actividades comerciales de esta. Cursos de interés contenidos en el currículo de estudios: Comportamiento Humano en las Organizaciones, Derecho Mercantil, Administración de Recursos Humanos, Legislación Protectora del Trabajo, Gerencia de Operaciones, Fundamento Empresarial, Estrategias Empresariales y Gerenciales, Empresas de Familia, Diseño y Desarrollo de un Plan de Negocio, Práctica Empresarial y Gerencial o Proyecto Empresarial o Gerencial.

| TODOS | BAY* | INTER-CAG* |
Finanzas (B.B.A.)
El programa de estudios en esta concentración adiestra al estudiante a usar los instrumentos de análisis en la solución de problemas y en la formulación de decisiones en el campo de las finanzas, tales como finanzas corporativas, banca e inversiones. Además, el programa ofrece la oportunidad de explorar las áreas de hacienda pública, seguros y bienes raíces. Cursos de interés contenidos en el currículo de estudios: Finanza Gerencial Avanzada, Principios de Inversiones, Mercado de Valores, Introducción al Riesgo y al Seguro, Finanza Internacional, Seminario en Finanzas, Moneda y Banca y Finanza Pública y Política Fiscal.
| BAY | MET | PON* | SG |
Gerencia de Operaciones de Manufactura y Servicio (B.B.A.)
La Gerencia de Operaciones de Manufactura y Servicio es un área de impacto significativo en la operación de las organizaciones. El objetivo de este programa es proveer al estudiante los conocimientos relacionados con la utilización efectiva de los factores de producción en actividades manufactureras y de servicios. Cursos de interés contenidos en el currículo de estudios: Gerencia de Transportación, Política y Estrategias Gerenciales, Ciencias Gerenciales, Gerencia de Operaciones, Gerencia de Compra y de Materiales, Fundamento Empresarial y Seguridad Industrial y Salud (Bienestar) Ocupacional.
| BAY | MET | PON* |
Contabilidad (B.B.A.)
El Bachillerato en Administración de Empresas en Contabilidad aspira a desarrollar un profesional en el campo de la Contabilidad que sea exitoso en el desempeño de sus funciones en el sector privado y público. Cursos de interés contenidos en el currículo de estudios: Sistema Contributivo de Puerto Rico para Individuos, Contabilidad de Costos, Contabilidad Intermedia, Introducción a Contribuciones Federales para Individuos, Sistemas Computadorizados Aplicados a la Contabilidad, Contabilidad para Organizaciones sin Fines de Lucro y Auditoría y Ética del Contador.
BAR* | GUA* | PON* | TODOS |
Economía Gerencial (B.B.A.)
La concentración en Economía Gerencial prepara al estudiante para conocer, analizar y aplicar los principios de economía, finanzas, contabilidad, sistemas de información, mercadeo y aplicarlos a las situaciones y problemas que surgen a diario en la administración de empresas públicas y privadas dentro del contexto económico y social de un país. Cursos de interés contenidos en el currículo de estudios: Economía Laboral, Finanza Pública y Política Fiscal, Economía Internacional, Macroeconomía Aplicada a los Negocios, Fundamentos Empresarial, Estrategias Empresariales y Gerenciales, Diseño y Desarrollo de un Plan de Negocios. | MET
* Se ofrece presencial y a distancia ** Solamente se ofrece a distancia
|
Bachillerato Grado Asociado
109 inter.edu AGU • AGUADILLA ARE • ARECIBO BAR • BARRANQUITAS BAY • BAYAMON INTER-CAG • CENTRO UNIVERSITARIO DE CAGUAS-METRO FAJ • FAJARDO GUA • GUAYAMA HUM • INTER HUMACAO MET • METRO PON • PONCE SG • SAN GERMÁN
Administración de Empresas General (B.B.A.)
El pograma provee una visión programática flexible, innovadora, que promueve el desarrollo integral del estudiante para desarrollar sus capacidades cognoscitivas y creativas, así como el juicio crítico necesario para desempeñarse en el mundo contemporáneo. Cursos de interés contenidos en el currículo de estudios: 38 créditos de concentración seleccionados entre los cursos de concentración de las siguientes disciplinas: Mercadeo, Gerencia de Recursos Humanos, Desarrollo Empresarial y Gerencial, Gerencia de Operaciones de Manufactura y Servicios, Administración de Sistemas de Oficina, Contabilidad, Finanzas, Tecnología de la Información, Economía Gerencial o cualquier área relacionada con administración de empresas. Los requisitos de concentración se establecerán en acuerdo entre el estudiante y el consejero académico, con la aprobación del director de departamento.
| AGU | BAY | MET |
Mercadeo (B.B.A.)
Mercadeo es una de las áreas funcionales de mayor importancia en la Administración de Empresas. Consiste en una variedad de actividades encaminadas a suplir bienes y servicios a consumidores, ya sean estos personas o empresas. Cursos de interés contenidos en el currículo de estudios: Gerencia de Mercadeo, Conducta del Consumidor, Comunicación Integrada de Mercadeo, Mercadeo Estratégico Contemporáneo, Investigación de Mercadeo, Mercadeo Global y Mercadeo Electrónico.

| AGU* | ARE | BAY | FAJ | MET | PON*
| SG |
Servicios de Salud (B.B.A.)
El Bachillerato en Administración de Empresas con concentración en Administración de Servicios de Salud se propone preparar egresados para desempeñarse en posiciones administrativas a nivel gerencial de primera línea o intermedias que no requieran una licencia profesional. Fundamentos en el Cuidado de Servicios de Salud, lntroducción a la Política de Salud Pública, Aspectos Éticos y Legales en el Servicio de Cuidado de Salud, Sistemas de Información en los Negocios, Administración de Recursos

Humanos, Bienestar y Calidad de Vida, Tecnología de la Información y Comunicación en la Administración de Servicios de Salud, Política y Estrategia Gerencial y Aspectos Financieros en el Servicio de Cuidado de Salud.
| ARE |
Entrenamiento y Gerencia Deportiva (B.A.)
Cursos de interés contenidos en el currículo de estudios: Introducción a Contabilidad Financiera, Fundamentos de Gerencia, Comunicación, Gerencia, Administración de Recursos Humanos, Supervisión, Legislación Protectora del Trabajo, Fundamento Empresarial, Kinesiología y Anatomía Funcional, Prevención y Seguridad Personal para Niños, Jóvenes y Adultos, Fundamentos Legales en el Deporte, Nutrición en el Deportivo, Ejercicio y Actividad Física, Fisiología del Movimiento Humano, Metodología del Entrenamiento Deportivo, Metodología del Entrenamiento Funcional, Diseño de Programas de Ejercicios, Experiencias Clínicas en Entrenamiento, Fundamentos del Deporte y la Recreación, Introducción al Mercadeo Deportivo y Desarrollo de Programaciones de Centros Deportivos y Recreativos.

110 Bachillerato Grado Asociado * Se ofrece presencial y a distancia ** Solamente se ofrece a distancia
| MET |
Gerencia de Recursos Humanos (B.B.A.)
Cursos de interés contenidos en el currículo de estudios: Comportamiento Humano en las Organizaciones, Administración de Recursos Humanos, Supervisión, Seguridad e Higiene en el Ambiente de Trabajo, Capacitación y Desarrollo de los Recursos Humanos, Legislación Protectora del Trabajo, Sindicación y Negociación Colectiva, Administración de Compensaciones y Seminario Integrador en Recursos Humanos.

| TODOS |
AGU y PON lo ofrecen presencial y a distancia
Administración de Sistemas de Oficina (B.A.)
Cursos de interés contenidos en el currículo de estudios: Escritura Abreviada en Español, Procesamiento de Información I y II, Producción de Documentos Comerciales, Hoja de Cálculo Electrónica, Administración de Documentos y Bases de Datos, Procesamiento de Información en Oficinas de Asuntos Legales, Procesamiento de Información en Oficinas de Servicios de Salud, El Recurso Humano en el Ambiente Organizacional, Facturación de Servicios de Salud, Comunicación Empresarial en Español, Comunicación Empresarial en Inglés, Diseño de Arte en la Oficina, Administración de Oficina, Comunicación Empresarial Interactiva en Inglés, Integración de Programas de Aplicaciones en la Administración de Oficinas, Telecomunicaciones en la Oficina, Práctica Profesional, Diseño y Administración de Adiestramientos, Seminario Integrador. |
Bienes Raíces (B.B.A.)
El programa pretende desarrollar las siguientes competencias: conocer las funciones inherentes al campo de Bienes Raíces, así como las tareas técnicas relacionadas a la industria inmobiliaria, tales como: la compraventa, el alquiler y otros derechos reales y la administración de la propiedad inmueble. Asimismo, el programa persigue concienciar al estudiante en los principios éticos que deben regir en este escenario laboral. Los egresados de este programa que aspiran obtener la licencia de vendedor y corredor deberán cumplir con los requisitos establecidos por la Junta de Corredor Vendedora. Los cursos de interes son: Sistemas de Información en los Negocios, Introducción a los Bienes Raíces, Comunicación Integrada de Mercadeo, Venta Personal, Economía de Bienes Raíces, Principios Legales de Bienes Raíces, Obligaciones y Contratos en Bienes Raíces, Financiamiento de Bienes Raíces, Principios de Administración de Propiedades Inmuebles, Introducción a la Evaluación de Bienes Raíces, Ética en Negocios de Bienes Raíces, Derecho Mercantil, Fundamento Empresarial, Finanza Personal, Gerencia de Ventas, Mercados Financieros y el Sector Bancario en los Bienes Raíces.
Gerencia de Empresas de la Música (B.B.A.)
El Bachillerato en Administración de Empresas en Gerencia de Empresas de la Música tiene como propósito principal capacitar a los estudiantes con las destrezas necesarias para desempeñarse con éxito en la gestión de cualquier organización vinculada con el negocio de la música. Los cursos de interés son: Introducción a los Negocios en la, Industria de la Música, Mercadeo de la Música, Principios de Manejo y Gerencia de Artistas, Fundamentos Musicales para Empresarios, Aspectos Legales en las Empresas de la Música, Difusión, Promoción y Distribución de la Música en Internet. Introducción a la Producción Musical, Gerencia de Proyectos en la Industria de la Música, Gerencia Estratégica de Mercadeo, Conducta del Consumidor, Comunicación, Integrada de Mercadeo y Relaciones Públicas Mercadeo Internacional.
| MET |
SG
MET y PON lo ofrecen presencial y
distancia
AGU | ARE | BAR | FAJ | GUA | PON |
|
a
| MET |
111 inter.edu AGU • AGUADILLA ARE • ARECIBO BAR • BARRANQUITAS BAY • BAYAMON INTER-CAG • CENTRO UNIVERSITARIO DE CAGUAS-METRO FAJ • FAJARDO GUA • GUAYAMA HUM • INTER HUMACAO MET • METRO PON • PONCE SG • SAN GERMÁN
Mercadeo para Medios Digitales (B.B.A.)
El Bachillerato en Administración de Empresas en Mercadeo para Medios Digitales provee una preparación práctica que propicie el desarrollo de las destrezas técnicas y las competencias que ayudan al entendimiento del papel del mercadeo en el comercio electrónico y al conocimiento de los medios digitales en este campo. Entre los cursos de interés se encuentran: Fundamentos de Mercadeo para Medios Digitales, Análisis de los Medios Gráficos, Desarrollo de Herramientas Web, Estrategias de Posicionamiento en Buscadores, Mercadeo para Medios Sociales, Mercadeo para Correo Electrónico, Estrategia para Diseño de Contenido, Analítica Web, Mercadeo Inbound, Práctica en Mercadeo para Medios Digitales y Seminario en Mercadeo para Medios Digitales.
| FAJ* |
Artes Culinarias y Ciencias Gastronómicas (B.A.)
El programa está diseñado sobre la base de los fundamentos y teorías de las ciencias de la gastronomía, prácticas sustentables y empresariales con un componente robusto de práctica en los laboratorios de cocina. Cursos de interés contenidos en el currículo
de estudios: Fundamentos Culinarios, Selección de Materias Primas, Destrezas de Cocina, Nutrición y Horticultura Culinaria, Destrezas de Cocina, Gastronomía Puertorriqueña, Panadería Complementaria , Cocina Global, Práctica Profesional, Gerencia de Operaciones en la Industria de Alimentos y Bebidas, Innovación y Cocina Experimental, Vinos y Gastronomía, Cocina Avanzada, Diseño Culinario y Estética de Alimentos, Seminario Integrador, Saneamiento y Seguridad, Teorías y Prácticas de Servicio, Sistema de Compras, Control de Inventario y Almacenamiento, Servicio de Bufé y Catering, Servicios de Coctelería, Administración de Alimentos y Servicios, Fundamentos de Gerencia, Fundamento Empresarial, Taller de Comunicación Comercial en Español y Taller de Comunicación Comercial en Inglés.
| BAR |
Análisis de Datos para Empresas (B.S.)


El Bachillerato en Ciencias en Análisis de Datos para Empresas está dirigido a desarrollar profesionales que deseen ampliar sus conocimientos en el análisis de datos e inteligencia de negocios. Este grado analiza la labor gerencial, desde la óptica de la inteligencia de los negocios y el

112 Bachillerato Grado Asociado * Se ofrece presencial y a distancia ** Solamente se ofrece a distancia
análisis de los datos y la información necesaria para la toma de decisiones.
Cursos de interés contenidos en el currículo de estudios: Introducción al Análisis de Datos, Diseño de Redes e Infraestructura Segura, Aplicaciones para la Toma de Decisiones en la Empresa, Estadísticas para el Análisis de Datos, Análisis y Diseño de Sistemas de Información Seguros, Bases de Datos para el Análisis de Datos, Aplicaciones de Inteligencia Empresarial, Proyecto Integrador, Lógica de Programación, Programación Estructurada, Programación Orientada a Objetos, Estructuras Computacionales Discretas , Bases de Datos, Estructuras de Datos, Introducción a la Contabilidad Financiera, Finanzas Corporativas , Principios de Microeconomía, Principios de Macroeconomía, Precálculo, Introducción al Mercadeo, Estadísticas, Contabilidad Intermedia, Fundamentos de Gerencia
Empresarial, Extracción y Análisis Avanzado de Datos, Ingeniería de “Software” , Cálculo, Investigación Operativa, Gerencia de Mercadeo y Fundamento Empresarial.
| MET | Administración de Empresas (A.A.S.)
El Grado Asociado en Ciencias Aplicadas en Administración de Empresas te ofrece desarrollar las destrezas y conocimientos básicos en el área de administración de empresas y desarrollo empresarial. Recibirás introducción a la Contabilidad Financiera, a la Contabilidad Gerencial, al Mercadeo, aprenderás los fundamentos de Gerencia y los de Empresarial, conocerás principios de Economía y comunicación empresarial en español e inglés.
| TODOS |
AGU, BAR, BAY y PON lo ofrecen presencial y a distancia
Administración de Sistemas de Oficina (A.A.)
El Grado Asociado en Artes en Administración de Sistemas de Oficina está diseñado para que te desempeñes como un profesional de apoyo administrativo en la administración de sistemas de oficina. Aprenderás sobre el Procesamiento de Información, sobre el Procesamiento de Información en Oficinas de Asuntos Legales y en las de Servicios de Salud, sobre la Producción de Documentos Empresariales, sobre Administración de Oficina y Ambiente Organizacional.
| AGU | ARE | BAR | FAJ | GUA |
| PON | SG |
BAR y PON lo ofrecen presencial y a distancia MET lo ofrece solamente a distancia
Contabilidad (A.A.S)
El Grado Asociado en Ciencias Aplicadas en Contabilidad ofrece al estudiante la oportunidad de desarrollar las destrezas y conocimientos fundamentales en el área de la contabilidad. Provee la preparación técnica que le permite al egresado realizar tareas básicas en el campo de la contabilidad. Cursos de interés contenidos en el currículo de estudios: Introducción a la Contabilidad Financiera, Sistema Contributivo de Puerto Rico para Individuos, Introducción a Contribuciones Federales para Individuos, Contabilidad de Costos, Contabilidad Intermedia I y II, Sistemas Computadorizados Aplicados a la Contabilidad, Fundamentos de Gerencia, Finanzas Corporativas I, Principios de Economía (Micro) y Estadística Básica.
| TODOS | AGU, BAR, BAY, GUA y PON lo ofrecen presencial y a distancia
Administración de Restaurantes y Servicios de Alimentos (A.A.S.)
El Grado Asociado en Ciencias Aplicadas en Administración de Servicios de Restaurantes y Alimentos está dirigido a personas que desean adquirir destrezas en el manejo de servicios de alimentos. Este grado asociado no es para ser chef. Es para ser administrador y supervisor en la industria de los alimentos. Aprenderás sobre Saneamiento y Seguridad en Servicios de Alimentos, sobre los Sistemas de Compras, Control de Inventarios y de Almacenamiento, en Servicios de Bufé y Catering, en Administración de Restaurantes, de Alimentos y Bebidas. Además, te instruirá con Fundamentos de Gerencia, Empresarial y Contabilidad Financiera y con Fundamentos en Turismo y Leyes.
| AGU | Artes Culinarias y Ciencias de la Gastronomía (A.A.)
¿Quieres ser chef? Pues este es el grado asociado que buscas. El Grado de Asociado en Artes en Artes Culinarias y Ciencias de la Gastronomía está diseñado para ofrecer a los estudiantes los conocimientos y destrezas técnicas necesarios para el desarrollo culinario tanto a nivel local como global. Te ofrece Fundamentos Culinarios, Destrezas de Cocina, Nutrición y Horticultura Culinaria, Gastronomía Puertorriqueña, Panadería Complementaria, Cocina Global, Saneamiento y Seguridad en Servicios de Alimentos.
| BAR |
113 inter.edu AGU • AGUADILLA ARE • ARECIBO BAR • BARRANQUITAS BAY • BAYAMON INTER-CAG • CENTRO UNIVERSITARIO DE CAGUAS-METRO FAJ • FAJARDO GUA • GUAYAMA HUM • INTER HUMACAO MET • METRO PON • PONCE SG • SAN GERMÁN



Justicia Criminal SOLICITA ADMISIÓN AQUÍ admisiones.inter.edu 114
JUSTICIA CRIMINAL (B.A.)
El programa permite al estudiante adquirir una capacidad personal y profesional conforme con sus intereses y aptitudes. Se da importancia al desarrollo adecuado de actitudes y características de la personalidad del estudiante, además de subrayar el conocimiento de las causas del crimen, la proyección del crimen, los métodos y técnicas modernas de justicia criminal.
Investigación Criminal (B.A.)
Cursos de interés contenidos en el currículo de estudios: Derechos Humanos y Civiles, Entrevistas e Interrogatorios, Leyes Penales Especiales, Investigación Criminal, Tecnología Moderna en la Investigación Criminal, Manejo y Tramitación de la Prueba, Detección y Manejo de Fraude.
| AGU* | ARE | BAR | INTER-CAG | FAJ | GUA | MET | PON* | SG |
Investigación Forense (B.A.)
Cursos de interés contenidos en el currículo de estudios: Derechos Humanos y Civiles, Comunicación Oral y Escrita para la Investigación Forense, Leyes Penales Especiales, Investigación Forense, Temas Especiales y Análisis de Datos para Investigación Forense.


| AGU | ARE | BAR | BAY | FAJ | INTER-CAG | PON |
Investigación de Delitos Cibernéticos (B.A)
Los cursos de interés en el currículo del programa: Delitos Cibernéticos, Derechos Humanos y Civiles, Entrevistas e Interrogatorios y Jurisdicción Federal.
| FAJ |
115 inter.edu AGU • AGUADILLA ARE • ARECIBO BAR • BARRANQUITAS BAY • BAYAMON INTER-CAG • CENTRO UNIVERSITARIO DE CAGUAS-METRO FAJ • FAJARDO GUA • GUAYAMA HUM • INTER HUMACAO MET • METRO PON • PONCE SG • SAN GERMÁN
Bachillerato Grado Asociado
*
Se ofrece presencial y a distancia
**
Solamente se ofrece a distancia
Ciencias Forenses (B.S.)
El Bachillerato en Ciencias Forenses presenta un currículo de naturaleza interdisciplinaria, que aspira a desarrollar en el estudiante los conocimientos y las destrezas fundamentales para la aplicación de métodos científicos utilizados para contribuir a esclarecer las causas, los métodos y las circunstancias de muerte y otros delitos. Cursos de interés contenidos en el currículo de estudios: Introducción a las Ciencias Forenses, Temas Especiales, Toxicología Forense, Investigación Forense, Práctica Forense, Seminario Integrador, Introducción a la Criminología y Derecho Penal.


| AGU | BAR | BAY | PON |
Justicia Criminal (A.A.)
El Grado Asociado en Artes en Justicia Criminal aspira a preparar a los estudiantes para una carrera en Justicia Criminal dotándoles con la información necesaria para continuar su educación conducente al bachillerato. El currículo incluye investigación criminal, derecho penal, organización y administración del sistema penal, leyes constitucionales, evidencia criminal, conducta delincuente y administración de justicia. Cursos de interés concernidos en el currículo de estudios: Introducción a la Criminología, Víctimas del Crimen, Sistema de Justicia Juvenil, Derecho Penal, Introducción a las Ciencias Políticas, Psicología General I, Introducción a la Sociología, Sistema de Justicia Criminal, Derechos Humanos y Civiles, Entrevistas e Interrogatorios, Leyes Penales Especiales, Investigación Criminal y Manejo y Tramitación de la Prueba.

| AGU | ARE | BAR | FAJ |

116 Bachillerato Grado Asociado * Se ofrece presencial y a distancia ** Solamente se ofrece a distancia
Ciencias Policiales (A.A.)
El Grado Asociado en Artes en Ciencias Policiales está diseñado para desarrollar en los estudiantes las competencias necesarias para desempeñarse efectivamente como un oficial del orden público en las esferas estatal y municipal. Estudiarás cursos como Procedimiento Criminal en Sistemas de Justicia, Víctimas del Crimen, Derechos Humanos y Civiles, Ética en Procesos de Prevención e Intervención, Derecho Penal, Entrevistas e Interrogatorios, Leyes Penales Especiales, Manejo y Tramitación de la Prueba, Investigación Criminal, Psicología General, Sistema de Justicia Criminal, entre otros.
| AGU | ARE | BAR | BAY | FAJ | GUA | MET | INTER-CAG |
Investigación Criminal (A.A.)
El Grado Asociado en Artes en Investigación Criminal contiene un currículo que capacita al estudiante con los elementos esenciales en la investigación criminal y a su vez le prepara para continuar el Bachillerato en Justicia Criminal. Recibes cursos tan interesantes como Introducción a la Criminología, Derechos Humanos y Civiles, Sistema de Justicia Juvenil, Crímenes de Cuello Blanco, Entrevistas e Interrogatorios, Leyes Penales Especiales, Investigación Criminal, Introducción a la Sociología, Sistema de Justicia Criminal, Psicología General I, entre otros. | PON |

117 inter.edu AGU • AGUADILLA ARE • ARECIBO BAR • BARRANQUITAS BAY • BAYAMON INTER-CAG • CENTRO UNIVERSITARIO DE CAGUAS-METRO FAJ • FAJARDO GUA • GUAYAMA HUM • INTER HUMACAO MET • METRO PON • PONCE SG • SAN GERMÁN
Matemáticas
Matemáticas (B.A.)
El Bachillerato en Artes en Matemáticas provee al estudiante las oportunidades necesarias para adquirir las destrezas, el conocimiento de los conceptos fundamentales, el dominio de los procesos matemáticos y el fortalecimiento de los valores éticos que lo preparen para seguir una carrera en matemáticas relacionada con la enseñanza a nivel de escuela secundaria o en cualquier otra en la que se requieran destrezas analíticas. Cursos de interés contenidos en el currículo de estudios: Precálculo, Métodos Discretos, Introducción a la Probabilidad y la Estadística, Cálculo, Temas de Geometría, El Lenguaje de las Matemáticas, Teoría de Números, Álgebra Lineal, Álgebra Aplicada o Álgebra Abstracta.



ADMISIÓN AQUÍ
118
SOLICITA
admisiones.inter.edu
| **MET | SG |
Psicología
Biopsicología (B.S.)
El Bachillerato en Ciencias en Biopsicología está diseñado para desarrollar las competencias básicas relacionadas con el estudio de los fundamentos biológicos del comportamiento humano. El programa enfatiza en el desarrollo de la capacidad analítica y reflexiva para el abordaje de los problemas del comportamiento humano en un contexto interdisciplinario. Cursos de interés contenidos en el currículo de estudios: Bioquímica, Biología Moderna, Fundamentos de Biología Vegetal y Animal, Química Orgánica, Introducción a la Probabilidad y Estadística, Física General, Psicología Comparada, Psicología de la Personalidad 3, Introducción a la Neurobiología, Biospsicología General, Química General, Pre Cálculo, Psicología General, Neurociencia, Biología Celular y Molecular, Farmacología, Bioética, Cálculo, Aprendizaje, Psicología del Desarrollo, Motivación y Emoción, Psicología Social y Psicopatología.
Psicología (B.A.)
El Bachillerato en Artes en Psicología está diseñado para proveer al estudiante los conocimientos y destrezas básicas que necesita para iniciarse en el estudio de la psicología. El currículo tiene un énfasis particular en desarrollar en el estudiante la capacidad de juicio crítico y valores éticos profesionales. Cursos de interés contenidos en el currículo de estudios: Psicología General, Redacción en la Psicología, Psicología del Desarrollo, Métodos Estadísticos, Aprendizaje, Psicología Fisiológica, Psicología
Social, Fundamentos de Entrevistas Psicológicas, Psicología Comunitaria, Principios de la Medición Psicológica, Psicopatología, Psicología de la Personalidad, Psicología
Experimental, Seminario Integrador, Antropología Social y Fundamentos de Biología.

|
|
MET
| AGU | ARE | INTER-CAG | FAJ | MET | SG |
Bachillerato Grado Asociado * Se ofrece presencial y a distancia ** Solamente se ofrece a distancia 119 inter.edu AGU • AGUADILLA ARE • ARECIBO BAR • BARRANQUITAS BAY • BAYAMON INTER-CAG • CENTRO UNIVERSITARIO DE CAGUAS-METRO FAJ • FAJARDO GUA • GUAYAMA HUM • INTER HUMACAO MET • METRO PON • PONCE SG • SAN GERMÁN
Religión



SOLICITA ADMISIÓN AQUÍ admisiones.inter.edu 120
Estudios en Religión (B.A.)
El programa está diseñado para demostrar conocimiento y comprensión del trasfondo cultural, político, económico y social del mundo bíblico, los aspectos básicos de la arqueología bíblica y su relación con la formación de los escritos bíblicos, el trasfondo histórico del desarrollo del misticismo cristiano y sus diversas manifestaciones, los conceptos básicos de la teología y las ideas que sustentan el pensar religioso. Cursos de interés contenidos en el currículo de estudios: Religiones Comparadas, Introducción a la Biblia, Geografía y Arqueología Bíblicas, Historia y Teología, Antiguo Testamento, Nuevo Testamento, Espiritualidad, Ética Cristiana, Organizaciones Religiosas, La Religión en Latinoamérica, Educación

Cristiana, Análisis del Discurso Religioso, Currículo de Educación
Cristiana, Filosofía de la Religión, Temas Especiales, Historia y Filosofía de la Educación y Psicología del Desarrollo. | FAJ | MET* |
Capellanía Institucional (A.A.)
El Grado Asociado en Artes en Capellanía Institucional aspira a desarrollar profesionales religiosos comprometidos que posean las competencias, los conocimientos, destrezas y actitudes éticas ministeriales que le capaciten para llevar a cabo intervenciones efectivas en el entorno del ambiente clínico, carcelario, educativo, laboral y eclesiástico, entre otros. Aprenderás sobre la Teoría de la Capellanía Institucional, sobre Espiritualidad, Religión y Salud Mental, Intervención y Manejo de Crisis, Intervención en Cuidado Pastoral, Psicología General, entre otros temas.
Estudios en Religión (A.A)
El Grado Asociado en Artes en Estudios en Religión aspira a ofrecer un grado que permita la movilidad del estudiante hacia el Bachillerato en Artes en Estudios en Religión para formar facilitadores capacitados para ofrecer una instrucción ecuménica de acuerdo con las necesidades particulares de la sociedad. El Recinto Metropolitano está autorizado a ofrecer este programa de forma presencial y a distancia. Se ofrecen los cursos como: Religiones Comparadas, Introducción a la Biblia, Geografía y Arqueología Bíblicas, Historia y Teología I, II y III, Antiguo Testamento, Nuevo Testamento, Espiritualidad, Ética Cristiana, Historia y Filosofía de la Educación, Psicología del Desarrollo.
| MET* |
Bachillerato Grado Asociado * Se ofrece presencial y a distancia ** Solamente se ofrece a distancia 121 inter.edu AGU • AGUADILLA ARE • ARECIBO BAR • BARRANQUITAS BAY • BAYAMON INTER-CAG • CENTRO UNIVERSITARIO DE CAGUAS-METRO FAJ • FAJARDO GUA • GUAYAMA HUM • INTER HUMACAO MET • METRO PON • PONCE SG • SAN GERMÁN

122
Música (B.A.)
Con una actividad de intensa creatividad artística compartida con la facultad de Artes Visuales, se facilita la oportunidad para desarrollarse en áreas alternas a la ejecución como concertista o educador. Cursos de interés contenidos en el currículo de estudios: Conjunto de Cámara, Banda, Coro, Orquesta Universitaria, Instrumento, Teoría y Solfeo, Piano: Clase Grupal, Armonía y Contrapunto, Armonía al Teclado, Música Occidental: Historia y Literatura, Historia de la Música de Puerto Rico y América Latina, Forma y Análisis, Orquestación y Arreglos, Dirección, Recital, Tecnología en la Educación Musical.
Música Aplicada (B.M.)

Música Popular (B.A.)
El Bachillerato en Artes en Música Popular prepara a los estudiantes para enfrentarse al exigente mundo profesional de la música popular en las áreas de la ejecución vocal o instrumental y de la improvisación. Esta capacitación técnica se complementa con cursos de historia de la música clásica, popular y puertorriqueña para que los estudiantes desarrollen una actitud inquisitiva, analítica y crítica hacia el arte de la música en todas sus expresiones. Cursos de interés contenidos en el currículo de estudios: Historia Comparada de la Música, Conjunto Instrumental, Conjunto Coral, Teoría y Solfeo, Piano Grupal, Guitarra Grupal, Notación Musical Digital, Improvisación Armonía, Composición, Arreglos, Grabación y Concierto de Graduación.
El programa de estudios fomenta experiencias de intensa creatividad artística bajo la atención personal de una facultad especializada, exitosa en facilitar el acceso a conexiones profesionales que pueden definir la carrera del futuro concertista. Además, se promueve la participación en conjuntos y clases individuales que permiten el desarrollo de destrezas de ejecución en una amplia variedad de estilos musicales. Cursos de interés contenidos en el currículo de estudios: Conjunto de Cámara, Banda, Coro, Orquesta Universitaria, Instrumento, Teoría y Solfeo, Piano, Armonía y Contrapunto, Armonía al Teclado, Música occidental: Historia y Literatura, Historia de la Música de Puerto Rico y América Latina, Orquestación y Arreglos, Dirección, Recital y Tecnología en la Educación Musical.

Bachillerato Grado Asociado
**
ofrece a distancia 123 inter.edu AGU • AGUADILLA ARE • ARECIBO BAR • BARRANQUITAS BAY • BAYAMON INTER-CAG • CENTRO UNIVERSITARIO DE CAGUAS-METRO FAJ • FAJARDO GUA • GUAYAMA HUM • INTER HUMACAO MET • METRO PON • PONCE SG • SAN GERMÁN
| SG |
* Se ofrece presencial y a distancia
Solamente se
Educación Musical General – Vocal (B.M.)

El Bachillerato en Música en Educación Musical General-Vocal, ofrece el contenido curricular requerido por el Departamento de Educación de Puerto Rico para la Certificación de Maestros de Bellas Artes con especialización en Educación Musical General-Vocal, aplicable a los niveles elemental y secundario (K-12). El graduado del programa igualmente cualifica como maestro en las Escuelas Especializadas en Música. Cursos de interés contenidos en el currículo de estudios: Instrumento, Música Aplicada para Estudiantes de otras concentraciones, Conjunto de Cámara, Coro, Dirección Coral, Historia y Filosofía de la Educación, Sociedad y Educación, Psicología del Desarrollo, Psicología del Aprendizaje, Población Estudiantil Excepcional, Evaluación y “Assessment”, Diseño de Currículo, Integración de Conocimientos Fundamentales y Competencias de la Comunicación, Integración de Competencias Profesionales, Experiencias de Campo en la Educación Musical, Experiencias Clínicas en la Educación Musical, Estrategias y Técnicas - GeneralVocal, Metodología para la Enseñanza Musical en la Escuela Elemental, Metodología y la Enseñanza Musical en la Escuela Secundaria y Práctica Docente en la Enseñanza de la Música: General Vocal.

| SG |
Educación Musical Instrumental (B.M.)
El Bachillerato en Música en Educación Musical Instrumental, ofrece el contenido curricular requerido por el Departamento de Educación de Puerto Rico para la Certificación de Maestros de Bellas Artes con especialización en Educación Musical Instrumental, aplicable a los niveles elemental y secundario (K-12). El graduado del programa cualifica igualmente como maestro en las Escuelas Especializadas en Música. Cursos de interés contenidos en el currículo de estudios: Instrumento, Música Aplicada para Estudiantes de otras concentraciones, Conjunto de Cámara, Banda u Orquesta, Dirección Instrumental, Historia y Filosofía de la Educación, Sociedad y Educación, Psicología del Desarrollo, Psicología del Aprendizaje, Población Estudiantil Excepcional, Evaluación y “Assessment”, Diseño de Currículo, Integración de Conocimientos Fundamentales y Competencias de la Comunicación, Integración de Competencias Profesionales, Experiencias de Campo en la Educación Musical, Experiencias Clínicas en la Educación Musical, Estrategias y Técnicas Instrumentales: Cuerdas, Estrategias y Técnicas
Instrumentales: Percusión, Metodología para la Enseñanza Musical en la Escuela Elemental, Metodología y para la Enseñanza
Musical en la Escuela Secundaria, Práctica Docente en la Enseñanza de la Música: Instrumental, Proceso Histórico de los Estados Unidos de América, Estrategias y Técnicas

Instrumentales: Metales, Estrategias y Técnicas Instrumentales: VientoMaderas, Conjunto de Cámara o Música Aplicada para Estudiantes de Otras Concentraciones, Conjunto de Cámara, Conjunto de Cámara e Instrucción Vocal, Taller en Música Popular y Fundamentos de Audio Grabación.

| SG |
124 Bachillerato Grado Asociado * Se ofrece presencial y a distancia ** Solamente se ofrece a distancia

125 inter.edu AGU • AGUADILLA ARE • ARECIBO BAR • BARRANQUITAS BAY • BAYAMON INTER-CAG • CENTRO UNIVERSITARIO DE CAGUAS-METRO FAJ • FAJARDO GUA • GUAYAMA HUM • INTER HUMACAO MET • METRO PON • PONCE SG • SAN GERMÁN
Turismo





SOLICITA ADMISIÓN AQUÍ admisiones.inter.edu 126
Administración Turística (B.B.A.)
La especialidad en Administración Turística es para aquellos estudiantes que deseen desarrollarse profesionalmente en las áreas del turismo, tales como; gobierno, empresa privada, negocios propios e instalaciones turísticas como hoteles, restaurantes y otros. Podrá desempeñarse en áreas de consultorías, planificación y zonificación de áreas turísticas, así como en la industria de la hospitalidad, viajes y excursiones. Cursos de interés contenidos en el currículo de estudios: Fundamentos del Turismo, Calidad y Servicios
Turísticos, Administración
Hotelera, Las Leyes y el Turismo, Mercadeo Turístico, Cultura y Destinos Turísticos de Puerto Rico,
Gerencia de Hoteles y Restaurantes (B.B.A.)
El programa aspira a desarrollar en el estudiante las competencias en el manejo de empresas gastronómicas y hoteleras que promuevan una operación eficiente, productiva y ética en las siguientes áreas: administración de recursos humanos, servicios a los clientes, tarifas,


Gestión Cultural y Ecoturismo (A.A.)
El Grado Asociado en Gestión Cultural y Ecoturismo tiene el propósito de proveer una formación integral del estudiante mediante el desarrollo de conocimientos, destrezas y actitudes que fortalezcan su formación profesional a través de los estudios multidisciplinarios. Se prepararán profesionales que aplicarán los conocimientos para satisfacer las necesidades en la región caribeña relacionadas con la gestión cultural y ecoturística y la creación de pequeñas empresas con esos fines. Cursos de interés contenidos en el currículo de estudios: Fundamentos del Turismo, Guía Intérprete del Patrimonio Natural, Las Leyes y el Turismo, Ecoturismo y Turismo Sustentable, Puerto Rico y el Caribe Insular, Fundamento Empresarial, Taller y Seminario Gestión Cultural y Ecoturismo, Estudios de Cultura Popular, Geografía Centroamérica y Caribe y Geografía de Puerto Rico.
Guía Turístico (A.S.)
El Grado Asociado en Ciencias en Turismo en Guía Turístico provee los principios, conceptos y prácticas de la industria turística y áreas relacionadas. Está dirigido a las personas con la habilidad para comunicarse en inglés y en español que deseen proseguir una carrera en la industria turística y para aquéllos que tienen experiencia en la misma y aspiren a puestos de supervisión. Algunos cursos son: Fundamentos del Turismo, Las Leyes y el Turismo, Mercadeo Turístico, Cultura y Destinos Turísticos de Puerto Rico, Introducción a la Contabilidad Financiera, Fundamentos de Gerencia, Destrezas de Comunicación y Técnicas de Interpretación, El Guía Turístico, entre otros.

127 inter.edu AGU • AGUADILLA ARE • ARECIBO BAR • BARRANQUITAS BAY • BAYAMON INTER-CAG • CENTRO UNIVERSITARIO DE CAGUAS-METRO FAJ • FAJARDO GUA • GUAYAMA HUM • INTER HUMACAO MET • METRO PON • PONCE SG • SAN GERMÁN
Trabajo Social
Trabajo Social (B.A.)
Este programa aspira a formar de manera amplia y profunda al profesional del trabajo social generalista en áreas teóricas y metodológicas, en el desarrollo de las competencias necesarias, así como en la clarificación de valores y actitudes para ejercer la profesión de manera efectiva. Además, incluye la oportunidad de obtener experiencias de educación práctica con agencias de bienestar social en Puerto Rico. Cursos de interés contenidos en el currículo de estudios: Introducción al Trabajo Social, Teorías y Debates en el Contexto Social de

la Profesión, La Política Social y los Servicios Sociales, El Ser Humano y su Ambiente Social, Introducción a la Administración y Supervisión de Agencias Sociales, Proceso de la Comunicación y la Entrevista, Redacción de Historiales, Metodología de la Investigación Social, Experiencias de Práctica Generalista de Trabajo Social, Trabajo Social Generalista con Individuos y Familias, Trabajo Social Generalista con Grupos, Trabajo Social Generalista con la Comunidad y Seminario de Educación Práctica.

128
| AGU | ARE | FAJ | MET*|
Bachillerato Grado Asociado * Se ofrece presencial y a distancia ** Solamente se ofrece a distancia SOLICITA ADMISIÓN AQUÍ admisiones.inter.edu

129
→ El Programa de Certificados
Técnicos aspira a ser la principal opción de estudios vocacionales, técnicos y de altas destrezas para aquellos que buscan nuevas alternativas de empleo.

130
ADMINISTRACIÓN HOTELERA
El Certificado Técnico en Administración Hotelera provee la oportunidad para que el estudiante se capacite en el desempeño de tareas afines con las principales áreas administrativas de la Industria Turística: hoteles, hostales, paradores, villas turísticas u otras instalaciones análogas.
El estudiante de Administración Hotelera podrá desarrollar las destrezas necesarias para desempeñarse en la prestación de servicios administrativos que comprende la hotelería con un énfasis especial en las áreas de Recepción y Reservaciones, Administración en Servicio de Alimentos y Bebidas, Administración de Habitaciones y Mantenimiento en General. Se espera que el estudiante desarrolle las competencias necesarias y las destrezas básicas dando atención especial al idioma inglés y el uso y manejo de la computadora. | SG |

AYUDANTE DE LABORATORIO
El Certificado Técnico de Ayudante de Laboratorio capacita al participante para trabajar como ayudante de laboratorios de química y microbiología. El contenido del programa permite el desarrollo de destrezas en el uso y manejo de técnicas e instrumentos de análisis químico y microbiológico.
Este programa provee una práctica de laboratorio para aplicar las destrezas adquiridas y familiarizarse con aspectos de salud y seguridad ocupacional. Los cursos de concentración tienen que ser aprobados con nota mínima de C. El curso de internado requiere ser aprobado con nota mínima de B. La admisión a este programa requiere el certificado de vacuna de Hepatitis B (tres dosis).
| ARE |
ENFERMERÍA PRÁCTICA
El Certificado Técnico de Enfermería Práctica tiene el propósito de formar recursos humanos para trabajar en el campo de la Enfermería Práctica. Asiste al enfermero profesional y al enfermero con grado de asociado en actividades relacionadas con el cuidado directo de pacientes con enfermedades agudas y crónicas en poblaciones de niños, adultos y viejos. El contenido de este programa, les proveerá a los estudiantes las competencias necesarias para solicitar el examen de reválida, o la certificación, conforme requerido para poder ejercer la profesión en Puerto Rico.
| ARE | SG |
ENTRENADOR PERSONAL
El Certificado Técnico en Entrenador Personal está diseñado para desarrollar competencias profesionales en el campo del entrenamiento personal. Promueve estilos de vida saludable, libre de drogas y alcohol, mediante discusiones socializadas y otras actividades de aprendizaje. El programa incluye aspectos administrativos de la profesión. Incluye además un período de práctica en un gimnasio certificado durante el cual los estudiantes aplicarán los conocimientos adquiridos en la sala de clase bajo la estricta supervisión de un entrenador personal certificado. El currículo está diseñado por las guías establecidas por el “American College of Sports Medicine” (ACSM) y por la “National Strength and Conditioning Association” (NSCA). El contenido de este programa, les proveerá a los estudiantes las competencias necesarias para solicitar el examen de reválida, o la certificación, conforme requerido para poder ejercer la profesión en Puerto Rico.
| AGU | ARE | BAR | BAY | FAJ | MET | PON | SG |
AGU | AGUADILLA
ARE | ARECIBO
BAR | BARRANQUITAS
BAY | BAYAMÓN
COA | CENTRO EXT. COAMO
FAJ | FAJARDO
GUA | GUAYAMA
HUM | CENTRO EXT. HUMACAO
MET | METRO
PON | PONCE
SG | SAN GERMÁN
131
ESPECIALISTA EN SISTEMAS COMPUTADORIZADOS Y REDES
El Certificado Técnico en Especialista en Sistemas Computadorizados y Redes ofrece al estudiante una preparación básica para el uso de computadoras en áreas técnicas y profesionales. Incluye conocimientos generales de la organización, reparación, diseño de páginas para internet, programación de sistemas computadorizados y redes.
ESTÉTICA INTEGRAL
El Certificado Técnico en Estética Integral prepara al estudiante en el desarrollo de destrezas y conocimientos generales en el campo de la salud y el cuidado de la piel. El estudiante adiestrado recibirá las competencias para poder trabajar en oficinas de dermatólogos, en salones de belleza, salones de Spa o como propietarios de su propia clínica de estética.
Los estudiantes no podrán comenzar su internado si no han aprobado los cursos de concentración.
GASTRONOMÍA INTERNACIONAL

El Certificado Técnico en Gastronomía Internacional permite que los estudiantes desarrollen destrezas que beneficien la salud y la alimentación de la población. A su vez, pretende colaborar en la economía del país a través del emprendimiento. Actualmente, reconocidos empresarios y chefs de la industria gastronómica y turística se mueven a desarrollar empresas, necesitando emplear personal adiestrado en esa área, representando una gran oportunidad de empleo o autoempleo. En el programa, los estudiantes aprenderán a diseñar menús internacionales, preparar banquetes, confeccionar desayunos locales e internacionales, sopas, ensalada, y salsas, y recetas de diferentes países.
El estudiante disfrutará su tarea mediante el aprendizaje de como las culturas han dado vida a diferentes fusiones de recetas, agregando sabores e ingredientes. La gastronomía es protagonista de las festividades culturales, a nivel internacional. En este programa de estudios, la cocina reúne los mejores sabores del mundo, desde una comida rápida y saludable, hasta platos gourmet e internacionales. El estudiante obtendrá las competencias para obtener un empleo en la competitiva industria de la gastronomía.
| MET |
| PON |
| AGU | BAY | MET | SG |
132
GUÍA TURÍSTICO
El Certificado Técnico en Guía Turístico tiene como propósito adiestrar al estudiante para emplearse o auto-emplearse en posiciones relacionadas con turismo. Este certificado incluye un ofrecimiento de experiencias reales y práctica externa en diversos centros asociados al turismo que complementan la educación formal del estudiante.
| SG |
MANEJO DE INFORMACIÓN Y FACTURACIÓN A PLANES MÉDICOS

El Certificado Técnico en Manejo de Información y Facturación a Planes Médicos Prepara a los estudiantes con los conocimientos y destrezas que se requieren para trabajar en la facturación a los planes médicos en cualquier institución proveedora de servicios de salud. Además, desarrolla las destrezas para la recopilación de información, manejo y análisis de datos, tanto en el sistema mecanizado, como de forma manual.
| AGU | BAR | PON |
OPERADOR DE COMPUTADORAS
El Certificado Técnico en Operador de Computadoras le ofrece al estudiante una preparación básica para el uso de las computadoras en áreas técnicas y profesionales. Incluye conocimientos generales de la organización, arquitectura y operación de sistemas computadorizados. Además, le permitirá al estudiante manejar y operar la computadora para el desarrollo de las destrezas necesarias para aplicar los programas computadorizados de mayor demanda en la industria, el comercio y la educación. Ofrece un trasfondo práctico-teórico que le facilita al egresado conseguir un empleo o continuar estudiando y desarrollándose en el campo de las ciencias de las computadoras.
| ARE |

AGU | AGUADILLA ARE | ARECIBO BAR | BARRANQUITAS BAY | BAYAMÓN COA | CENTRO EXT. COAMO FAJ | FAJARDO GUA | GUAYAMA HUM | CENTRO EXT. HUMACAO MET | METRO PON | PONCE SG | SAN GERMÁN
133
ARTES CULINARIAS
El Certificado Técnico en Artes Culinarias provee al estudiante los conocimientos y destrezas que se requieren en la preparación y servicio de alimentos. Desde un enfoque práctico-teórico, el estudiante adquiere conocimientos en el manejo, preparación y presentación de alimentos fríos y calientes, tanto de la cocina criolla como internacional. Este certificado prepara al estudiante para una carrera de alta demanda en la industria de alimentos.

| AGU | BAR | BAY | COA | FAJ | PON | SG |
BARBERÍA
El Certificado Técnico en Barbería provee al estudiante los conocimientos y destrezas requeridas para realizar las funciones de barbero en el campo de la belleza, diseño y gerencia del salón de belleza: afeite de barba y bigote, cuidado del cabello y la piel, manicura, corte, rolos, ondas, estilos de peinado, química, electricidad, secado del cabello y técnicas de color.
Los conocimientos que el estudiante adquiera le ayudarán para desempeñarse en empleos en lugares tales como: barberías o salones de belleza, en la administración de un salón de belleza o de barbería y en el trabajo a domicilio. El certificado ha sido diseñado con el objetivo de adiestrar estudiantes en el campo
134
de la belleza de forma adecuada y en conformidad con los parámetros de la Junta Examinadora de esta profesión en Puerto Rico. El contenido de este programa, les proveerá a los estudiantes las competencias necesarias para solicitar el examen de reválida o la certificación, conforme requerido para poder ejercer la profesión en Puerto Rico.
| AGU | BAR | FAJ | GUA | SG |
COSMETOLOGÍA
El Certificado Técnico en Cosmetología provee al estudiante los conocimientos y destrezas requeridas para realizar las funciones de cosmetólogo(a) en el campo de la belleza, diseño y gerencia del salón de belleza: cuidado del cabello y la piel, manicura, pedicura, corte, rolos, ondas, estilos de peinado, química, electricidad, secado del cabello y técnicas de color.
Los conocimientos que el estudiante adquiera le ayudarán a desempeñarse en un empleo donde pueda realizar trabajo en salones de belleza, la administración del salón de belleza y el trabajo a domicilio. El certificado fue diseñado con el objetivo es adiestrar estudiantes en el campo de la belleza de forma adecuada y en conformidad con los parámetros de la Junta Examinadora de Junta Examinadora de Especialistas en Belleza de Puerto Rico. El estudiante que participa de este certificado se prepara para trabajar y administrar salones de belleza.
TÉCNICO DE CONSTRUCCIÓN

El estudiante adquirirá los conocimientos y desarrollará las destrezas en las áreas de carpintería, plomería, electricidad, ebanistería, soldadura, albañilería, mantenimiento, remodelación y construcción residencial. Se da énfasis a la calidad del trabajo a través de experiencias seguras y productivas, incluyendo la construcción de un proyecto especial en los laboratorios de práctica. Incluye prácticas seguras, el uso de materiales de construcción, herramientas eléctricas y manuales, reglas de seguridad y reglamentos aplicables en los procesos de construcción. Su formación está orientada al desarrollo del trabajo en equipo el cual le permitirá ser asertivo en la planificación y solución de problemas. Se caracteriza por tener un alto contenido práctico orientado al desarrollo de competencia en el área de la construcción.
| SG |
AGU | AGUADILLA
ARE | ARECIBO
BAR | BARRANQUITAS
BAY | BAYAMÓN
COA | CENTRO EXT. COAMO
FAJ | FAJARDO
GUA | GUAYAMA
HUM | CENTRO EXT. HUMACAO
MET | METRO
PON | PONCE
SG | SAN GERMÁN
| AGU | BAR | BAY | FAJ | GUA | SG |
135
TÉCNICO DE CUIDADO RESPIRATORIO

El Certificado Técnico en Cuidado Respiratorio está diseñado para desarrollar en el estudiante competencias profesionales en el campo de las ciencias de la salud. Se espera que los estudiantes sean capaces de interactuar de forma integrada y efectiva con los pacientes y el equipo de trabajo, en la implantación de toda modalidad terapéutica de la profesión. Los estudiantes tendrán la oportunidad de desarrollar las destrezas necesarias en los procesos de diagnóstico, evaluación, tratamiento y rehabilitación de un paciente con enfermedades cardiopulmonares. Al completar el currículo, los estudiantes contarán con los requisitos académicos necesarios para solicitar el examen de reválida para la profesión de Técnico de Cuidado Respiratorio en Puerto Rico.
| ARE | SG |
TÉCNICO DE CUIDADO INFANTIL
El Certificado Técnico en Cuidado Infantil tiene como propósito adiestrar para emplearse o autoemplearse en posiciones de cuidado de niños e infantes. Toma en cuenta el aspecto físico, emocional, social, recreativo y de salud mediante el ofrecimiento de experiencias reales y práctica externa en los diversos centros de práctica.
| ARE | MET | PON | SG |
ELECTRICIDAD CON PLC Y ENERGÍA RENOVABLE
El Certificado Técnico en Electricidad con PLC y Energía Renovable provee a los estudiantes los conocimientos, destrezas y habilidades requeridas en el campo de la electricidad residencial, comercial e industrial. El programa está diseñado para satisfacer las demandas laborales en el campo de la electricidad. Los estudiantes integran la teoría y la práctica, adquieren conocimientos, desarrollan su talento y aplican sus destrezas para comprender la generación, transmisión y distribución de los sistemas eléctricos.
El estudiante adquiere conocimientos sobre destrezas
básicas aplicadas a su profesión y el uso y manejo de la computadora. El programa comprende un currículo integrador que abarca los principios básicos de la electricidad, normas y reglamentos de diferentes sistemas electrónicos y de energía renovable. La admisión a este programa requiere que presente un certificado médico certificando condición de salud satisfactoria para trabajar en proyectos de construcción con aparatos y circuitos electrónicos. El contenido de este programa, les proveerá a los estudiantes las competencias necesarias para solicitar el examen de reválida, o la certificación, ofrece la Junta Examinadora de Peritos Electricistas para poder ejercer la profesión en Puerto Rico.
| BAY | SG |
DISEÑO DE PÁGINA EN INTERNET
El Certificado Técnico en Diseño de Página en Internet ofrece al estudiante una preparación técnica en el uso de los programas más comunes en el ambiente electrónico para la creación, diseño y utilización de páginas electrónicas en Internet. El egresado recibirá las competencias para poder desempeñarse en la creación de páginas electrónicas para uso personal, informativo y comercial.
| SG |
136
FACTURACIÓN EN SERVICIOS DE SALUD
El Certificado Técnico en Facturación en Servicios de Salud ofrece a los estudiantes la oportunidad de iniciarse en el área administrativa de la prestación de servicios médicos. El estudiante desarrollará las destrezas básicas para llevar a cabo los procedimientos del manejo de una oficina de servicios de salud, incluyendo expedientes médicos. El certificado hace énfasis especial en los procedimientos de facturación a planes médicos tales como: servicios médicos, dentales, de laboratorio y hospital. El estudiante, también, conocerá la terminología médica y federal asociada a estos procedimientos, los métodos de contabilidad básica y los de auditoría.
| ARE | FAJ | GUA | HUM | SG |
DISEÑO Y MERCADEO DE MODAS
El Certificado Técnico en Diseño y Mercadeo de Modas está diseñado para desarrollar las competencias de conocimientos, destrezas y actitudes que le permitan al estudiante generar los conocimientos teóricos relacionados con el área de mercadeo de modas atemperadas a la industria actual local e internacional. Analizar las tendencias de la moda, la promoción y su importancia en el mercadeo de modas. Utilizar la investigación para integrar las tendencias de la moda y su aplicación en el mercadeo. Analizar estudios de casos e identificar oportunidades de mercadeo de modas.
 | SG |
| SG |
AGU | AGUADILLA
ARE | ARECIBO
BAR | BARRANQUITAS
BAY | BAYAMÓN
COA | CENTRO EXT. COAMO
FAJ | FAJARDO
GUA | GUAYAMA
HUM | CENTRO EXT. HUMACAO
MET | METRO
PON | PONCE
SG | SAN GERMÁN
TÉCNICO DE FARMACIA
El Certificado Técnico en Farmacia está diseñado para desarrollar competencias profesionales en el escenario laboral de las farmacias. Se espera que los estudiantes dominen los conocimientos y las destrezas que les permitan asistir al farmacéutico en la preparación de recetas y en algunas tareas administrativas en la farmacia.
El Certificado Técnico en Farmacia se divide en dos años. Durante el primer año, el estudiante se prepara con los conocimientos y destrezas básicas de la disciplina y en el segundo año realiza el internado. El estudiante, bajo la supervisión de un farmacéutico autorizado, completará un mínimo de 1,000 horas de práctica requeridas para tomar el examen de reválida, según lo establece el Reglamento General de la Junta de Farmacia de Puerto Rico. Para tomar el examen de reválida la Junta de Farmacia requiere que el estudiante haya aprobado el curso de Química de escuela superior (un año).
| ARE | BAY | FAJ | MET | SG |
137
REPOSTERÍA Y PANADERÍA COMERCIAL

El Certificado Técnico en Repostería y Panadería Comercial prepara al estudiante con los conocimientos y las destrezas necesarias para la confección de panes, dulces clásicos, postres internacionales, bizcochos, entre otros. Bajo un enfoque completamente práctico el estudiante adquirirá los conocimientos en el manejo,
PROGRAMACIÓN DE COMPUTADORAS
(Modalidad a distancia)
Preparación básica en la programación de las computadoras en áreas técnicas y profesionales. Incluye conocimientos generales de la organización, operación y programación de sistemas computadorizados. Este certificado provee al estudiante los conocimientos para el manejo
demanda en la industria, el comercio y la educación, entre otros. Tiene un contenido práctico y teórico que permite al estudiante continuar estudios y desarrollarse en el campo de la programación en computadoras. Este programa se ofrece mediante la modalidad de educación a distancia.

138
TÉCNICO QUIRÚRGICO
El Certificado Técnico en Técnico Quirúrgico está diseñado para desarrollar las competencias profesionales para asistir de forma directa con los médicos y el personal de enfermería durante los procesos quirúrgicos. Identificara los instrumentos necesarios, materiales y suplido estéril durante la operación. El escenario de trabajo principal son hospitales y centros de cirugías ambulatorias.
| ARE | BAR |
ENFERMERÍA PRÁCTICA CON ÉNFASIS EN CUIDADO PROLONGADO
El Certificado Técnico en Enfermería Práctica con Énfasis en Cuidado Prolongado tiene el propósito de capacitar a personas para ofrecer cuidado de enfermería con las competencias requeridas en una enfermera practica con estudios en flebotomía y cuidado de ulceras. En el transcurso de su desarrollo académico adquirirá conocimientos y destrezas en venopunción y manejo de pacientes con ulceras. Se trata de formar enfermeras especialistas que puedan satisfacer las necesidades de una población con condiciones médicas específicas.
AGU | BAY |
EMPRENDEDURISMO
El Certificado Técnico en Emprendedurismo provee a los estudiantes las competencias básicas para preparar un plan de negocio para desarrollar una empresa o negocio. El programa provee un currículo que abarca los principios básicos de las leyes estatales, federales e internacionales, la contabilidad y finanzas desde una perspectiva empresarial.

| ARE |

SISTEMA DE FACTURACIÓN Y COBRO EN SERVICIOS DE SALUD
El Certificado Técnico en Sistema de Facturación y Cobro en Servicios de Salud permite al estudiante asumir responsabilidades de la administración de una oficina de servicios de salud destacando su aprendizaje en el proceso de facturación y cobro a distintos planes médicos. El estudiante utilizará la terminología propia de este campo de estudios, conocerá el ciclo del proceso de facturación y manejará un expediente médico conforme a reglamentación federal y local.

| MET |
AGU | AGUADILLA
ARE | ARECIBO
BAR | BARRANQUITAS
BAY | BAYAMÓN
COA | CENTRO EXT. COAMO
FAJ | FAJARDO
GUA | GUAYAMA
HUM | CENTRO EXT. HUMACAO
MET | METRO
PON | PONCE
SG | SAN GERMÁN
REPARACIÓN Y REDES
En la actualidad el sector tecnológico experimenta cambios rápidos y constantes. Esto provoca que las empresas se mantengan a la orden del día en las necesidades del usuario y las del mercado. Por una parte, los usuarios en su ambiente doméstico requieren cada vez más de la ayuda de los técnicos a que les resuelvan los problemas que surgen en relación al uso y manejo de servicios profesionales. Por otro lado, se ha destacado que las empresas requieren empleados capacitados en las áreas de programación y redes con destrezas para diagnosticar problemas y ofrecer apoyo directo o mediante comunicación telefónica a los usuarios.
| MET |
139
TÉCNICO DE COMPUTADORAS
El Certificado Técnico en Computadoras ofrece al estudiante una preparación básica para el uso de las computadoras en áreas técnicas y profesionales. Incluye conocimientos generales de la organización, arquitectura, operación y programación de sistemas computadorizados. Este certificado provee al estudiante los conocimientos para el manejo y operación de la computadora y el desarrollo de las destrezas para la aplicación de programas computadorizados de mayor demanda en la industria, el comercio y la educación, entre otros. El programa tiene un contenido práctico-teórico que permite al estudiante continuar estudios y desarrollarse en el campo de los sistemas de información.

| SG |
Se ofrece en modalidad presencial y a distancia.
TERAPEUTA DE MASAJE
El Certificado Técnico en Terapeuta de Masaje permite al estudiante adquirir los conocimientos y las técnicas de manipulación, estiramiento y la aplicación del masaje terapéutico según los diversos problemas físicos o emocionales que presente el cliente. En el trascurso de su desarrollo académico el estudiante aprenderá a desarrollar habilidades de terapia manual destinadas a producir una serie de reacciones fisiológicas controladas, en el sistema musculo-esquelético y/u otros sistemas del cuerpo, que conducen al alivio terapéutico de la condición tratada. Como requisito de graduación el estudiante deberá certificarse en las técnicas de resucitación cardiopulmonar, CPR.
| BAY | FAJ | MET |
TÉCNICO EN SEGURIDAD DE REDES
El Certificado Técnico en Seguridad de Redes capacita al estudiante en destrezas esenciales para el manejo de situaciones de seguridad en las redes informáticas. Incluye conocimientos generales de los sistemas operativos utilizados en redes, la discusión sobre fallas de seguridad, ataques cibernéticos e informática forense. El estudiante podrá atender problemas relacionados con la seguridad de las redes mediante el uso de programas especializados y el desarrollo de estructuras de defensa a posibles amenazas cibernéticas.
Cursos de interés contenidos en currículo de estudios: Uso y Manejo de la Computadora, Ensamblaje, Reparación y Mantenimiento de Computadoras, Principios de Telecomunicaciones y Fundamentos de Redes, Sistemas Operativos, Técnicas de Hacking I y II, Introducción a las Bases de Datos, Principios de Auditoría de Redes, Introducción a la Seguridad en las Redes, Fundamentos de Informática Forense, Seminario de Seguridad en Redes y Aspectos Éticos y Legales en las Redes.
| MET |
TÉCNICO DE AGRICULTURA TECNOLÓGICA
El programa ofrece una preparación básica en la agricultura con componentes tecnológicos. Incluye conocimientos generales de la organización, operación y programación de fincas. Este certificado provee los conocimientos para el manejo y operación en la agricultura y usos de recursos de la tierra, entre otros. El programa tiene un contenido teórico-práctico que permite al estudiante continuar estudios y desarrollarse en el campo de la agricultura, así como administrar pequeños negocios.
| SG |
140
ESPECIALISTA EN FACTURACIÓN DE SERVICIOS DE SALUD
Este programa capacita al estudiante para realizar tareas relacionadas con la administración de la oficina médica, la codificación de diagnósticos y procedimientos, la facturación y la auditoría. El estudiante tendrá la oportunidad de utilizar la tecnología adecuada, programas y programas especializados para procesamiento de información, récord médico, facturación y contabilidad. El programa incluye un internado de práctica para reforzar los conocimientos y adquirir experiencias.

Se ofrece en modalidad a distancia.
EVALUACIÓN Y TERAPIA EDUCATIVA
Técnico de Evaluación y Terapia
Educativa: Los estudiantes adquirirán conocimientos en las áreas de formación del terapeuta educativo y ética en su práctica, función cerebral en relación con el aprendizaje según las neurociencias, integración sensorial y sus implicaciones educativas, elaboración del perfil psicopedagógico, técnicas informales para detectar dificultades de aprendizaje, intervención con tecnología en terapia educativa, tecnología asistida en terapia educativa, terapia educativa y estrategias de intervención, estrategias para el desarrollo de habilidades en la administración de evaluaciones formales en el proceso psicoeducativo y elaboración de un plan de intervención.
Se ofrece en modalidad a distancia.
| MET |
AGU | AGUADILLA
ARE | ARECIBO
BAR | BARRANQUITAS
BAY | BAYAMÓN
COA | CENTRO EXT. COAMO
FAJ | FAJARDO
GUA | GUAYAMA
HUM | CENTRO EXT. HUMACAO
MET | METRO
PON | PONCE
SG | SAN GERMÁN
TÉCNICO EN GERONTOLOGÍA
Este programa provee al estudiante los conocimientos, destrezas y actitudes necesarias para trabajar con la población de edad avanzada. Está orientado a desarrollar nuevos conceptos, ideas, valores y destrezas que preparan al estudiante para ofrecer un servicio adecuado a la población de edad avanzada. El estudiante adquirirá las competencias para poder prestar servicios en agencias públicas y privadas que atiendan a la persona de edad avanzada, así como ofrecer sus servicios a familias en carácter privado. El estudiante desarrollará una mayor sensibilidad hacia el cuidado de la persona de edad avanzada el cual es un área de mayor demanda, llenando así las necesidades de la sociedad puertorriqueña.
| SG |
|
MET |
141
REDES Y FORENSE
Este programa prepara al estudiante para el manejo correcto de sistemas de computadoras, lógica y administración básica de redes. Se capacitarán para manejar, de forma básica, incidentes de seguridad e investigación forense de sistemas de redes de computadoras. Esto le permitirá laborar como asistente o entry level security and incident management para cualquier industria. El curso explora los conceptos de auditoria y base de datos lo que les permitirá generar reportes acerca de señalamientos y planes de acción correctiva en cuanto a manejo de redes de computadoras.
Se ofrece en modalidad a distancia. | MET |
REPARACIÓN Y REDES
Este programa capacita al estudiante con las destrezas esenciales para desenvolverse como especialista de reparación de computadoras. Estará capacitado en las mejores prácticas sobre el uso de equipos de computadoras y redes, para reducir y resolver problemas de funcionamiento. Además, tendrá destrezas básicas de lógica de programación, instalación y mantenimiento de sistemas operativos. Finalmente, el estudiante desarrollará las destrezas básicas de reparación administración y seguridad de redes.

Se ofrece en modalidad a distancia.
TÉCNICO EN SEGURIDAD DE REDES
Este programa capacita al estudiante en destrezas esenciales para el manejo de situaciones de seguridad en las redes informáticas. Incluye conocimientos generales de los sistemas operativos utilizados en redes, la discusión sobre fallas de seguridad, ataques cibernéticos e informática forense. El estudiante podrá atender problemas relacionados con la seguridad de las redes mediante el uso de programas especializados y el desarrollo de estructuras de defensa a posibles amenazas cibernéticas.
Se ofrece en modalidad a distancia. | MET |
TÉCNICO DE UÑAS Y EL ARTE DE LA PINCELADA
Este programa prepara al estudiante en el desarrollo de destrezas y conocimientos generales del diseño de uñas. De forma práctica, se instruirá a los estudiantes en todas las áreas de cuidado de las uñas, incluyendo las aplicaciones prácticas, teorías, control infeccioso y servicio al cliente. El estudiante obtendrá el conocimiento para realizar manicura básica, así como mostrar su lado artístico, creando diseños de arte en las uñas. El egresado del programa podrá trabajar en salones de belleza o como propietario de su propio negocio. | AGU |

|
|
MET
142
TÉCNICO DE ASISTENTE EN ADMINISTRACIÓN DE OFICINA
El programa ofrece a los estudiantes la oportunidad de desempeñarse como un profesional de apoyo en el área administrativa y procedimientos del manejo de la oficina médica.
Presentar evidencia de graduación de una escuela superior acreditada o su equivalente. 1
2
Presentar certificado de inmunización (PVAC-3) si es menor de 21 años.
Participar en una orientación, individual o grupal. 3
AYUDAS ECONÓMICAS, SI CUALIFICAS.
AGUADILLA
(787) 891-0925 ext. 2360 aguadilla.inter.edu
ARECIBO
(787) 878-5475 exts. 3521, 3522 arecibo.inter.edu
BARRANQUITAS
(787) 857-3600 ext. 2034 br.inter.edu
BAYAMÓN
(787) 279-1912 exts. 2033, 2012 bayamon.inter.edu
METRO
(787) 250-1912 exts. 2107, 2308, 2280 metro.inter.edu
PONCE
(787) 510-7030
(787) 284-1912 ext. 3240 ponce.inter.edu
FAJARDO
(787) 863-2390
exts. 2217, 2248, 2351 fajardo.inter.edu
GUAYAMA
(787) 864-2222
exts. 2231, 2230 guayama.inter.edu
SAN GERMÁN
(787) 264-1912, exts. 7423, 7433 sg.inter.edu
OFICINA CENTRAL
(787) 766-1912
exts. 2267, 2397 intertec.pr
Para información de nuestras tasas de graduación, deuda, promedio de los estudiantes e información adicional, acceda http://intertec.pr/empleoremunerado/
 La UIPR posee Licencia de la Junta de Instituciones Post Secundarias de Puerto Rico y está acreditada por la Middle States Commission on Higher Education, 1007 North Orange Street 4th Floor, MB #166 Wilmington, DE 19801. (267-284-5000). La Middle States Commission on Higher Education es una agencia de acreditación reconocida por el Secretario de Educación de los EE.UU. y por el Council for Higher Education Accreditation.
La UIPR posee Licencia de la Junta de Instituciones Post Secundarias de Puerto Rico y está acreditada por la Middle States Commission on Higher Education, 1007 North Orange Street 4th Floor, MB #166 Wilmington, DE 19801. (267-284-5000). La Middle States Commission on Higher Education es una agencia de acreditación reconocida por el Secretario de Educación de los EE.UU. y por el Council for Higher Education Accreditation.
143
| ARE |
CONVIÉRTETE EN UN
PROFESIONAL MODA

Y LA BELLEZA DE LA
Si te fascina el mundo de la belleza, la estética y la moda, y tienes el talento, te ayudamos a convertirte en un profesional de primera. Nuestros cursos están diseñados para fortalecer las destrezas y técnicas que te permitirán desempeñarte en la fascinate industria de la belleza y la moda a nivel local e internacional.





En INTERTEC te preparamos en corto tiempo para trabajar en diversos escenarios de empleo o establecer tu propio negocio.

ESTÉTICA INTEGRAL COSMETOLOGÍA TÉCNICO DE UÑAS BARBERÍA DISEÑO Y MERCADEO DE MODAS AGUADILLA BARRANQUITAS BAYAMÓN FAJARDO GUAYAMA METRO SAN GERMÁN Impulsa tus La INTER metas ESTÉTICA INTEGRAL COSMETOLOGÍA DISEÑO Y MERCADEO DE MODAS TÉCNICO DE UÑAS Y EL ARTE DE LA PINCELADA BARBERÍA
CIENCIAS AGRÍCOLAS EN AGRONOMÍA
BACHILLERATO
INNOVACIÓN EDUCATIVA PARA LOS FUTUROS
AGRICULTORES
El nuevo programa de Bachillerato en Ciencias Agrícolas en Agronomía que se ofrece en el Recinto de Guayama, prepara profesionales con los conocimientos y destrezas para integrar la tecnología en el desarrollo de la agricultura y promoverla como un estilo de vida sustentable.


Contamos con excelentes instalaciones laboratorios, extensiones de terreno y acuerdos colaborativos para un escenario práctico en el ambiente agropecuario. El programa te prepara para trabajar en la producción y venta de productos agrícolas, como administrador de fincas, investigador o consultor, entre otros.
ÁREAS DE INTERÉS:
• Investigación
• Integración tecnológica
• Producción de ambientes controlados
• Agricultura urbana
• Emprendimiento agrícola



• Micropropagación
• Granja cunícula
Impulsa tus La INTER metas GUAYAMA
LA
Cuenta con la participación de los siguientes deportes en la Liga Atlética Interuniversitaria
→ ATLETISMO (F/M)


- CAMPEONATO CAMPO TRAVIESA
- CAMPEONATO RELEVOS UNIVERSITARIOS
- CAMPEONATO JUSTAS LAI
→ BALONCESTO (F/M)

- TORNEO DE CANCHA
- TORNEO DE 3X3
→ BÉISBOL (M)
→ FÚTBOL (F/M)
→ HALTEROFILIA (F/M)
→ JUDO (F/M)
→ LUCHA OLÍMPICA (M)
→ NATACIÓN (F/M)
- CAMPEONATO PISCINA CORTA
- CAMPEONATO PISCINA LARGA
→ TAEKWONDO (F/M)
→ TENIS DE CAMPO (F/M)
→ TENIS DE MESA (F/M)
→ VOLEIBOL (F/M)
- TORNEO DE VOLEIBOL DE CANCHA
- CAMPEONATO DE VOLEIBOL
UNIVERSIDAD INTERAMERICANA DE PUERTO RICO ofrece un programa deportivo cuya misión está dirigida a lograr la mayor participación de la comunidad universitaria.
Para más información: 787.892.5700 146










deportes.inter.edu 147
Servicios ESTUDIANTILES
→ Consejería profesional


Los servicios de consejería profesional facilitan el ajuste de los estudiantes al ambiente universitario. A través de los consejeros profesionales se brindan servicios de orientación académica y consejería vocacional y personal. Se ayuda al estudiante en el desarrollo de sus metas educativas, vocacionales y personales y en el logro de una mejor integración y participación en la comunidad universitaria.

148
→ Actividades estudiantiles

Durante el año académico, la universidad y los consejos de estudiantes de las diferentes unidades docentes patrocinan diversas actividades culturales, sociales, deportivas, educativas, religiosas y recreativas, en las cuales se invita a participar al estudiantado y a la comunidad universitaria.
Tal participación fomenta el enriquecimiento personal y brinda la oportunidad de desarrollo de liderato mediante la comprensión y la cooperación mutua y el énfasis en ideales de servicios, la buena ciudadanía y el respeto por los valores humanos. La universidad se esfuerza por fomentar estas actividades.
Existen varios clubes y organizaciones en las unidades académicas de la universidad. Estas organizaciones pueden ser de carácter académico, profesional, cultural, recreativo, social, deportivo o religioso. Las oficinas de los decanos de estudiantes de las diferentes unidades docentes proveerán, si así se solicita, la información más reciente sobre estas organizaciones, sus funcionarios y matrícula.


→ Centro de acceso a la información
Cada recinto cuenta con un Centro de Acceso a la Información (CAI) con recursos humanos debidamente capacitados, recursos educativos y espacios físicos adecuados. Un catálogo en línea provee acceso a todos los recursos bibliográficos que posee la Institución, así como a materiales audiovisuales, revistas y libros impresos y electrónicos disponibles para el estudio y la investigación.
Los Centros de Acceso a la Información proveen acceso remoto a las bases de datos electrónicas que suscribe la Institución, a las que se preparan internamente y a otras de interés científico que están disponibles gratuitamente.
El sistema cuenta con una colección que sobrepasa el millón de ítemes, tales como libros impresos y electrónicos, bases de datos de revistas académicas, videos educativos, microfichas y micropelículas.

→ Centros de estudiantes
La mayoría de las unidades de la universidad cuentan con centros de estudiantes para atender las necesidades de la comunidad universitaria: estudiantes, facultad, administración, exalumnos, padres y amigos. Dichos locales proveen el lugar adecuado para el desarrollo de actividades sociales, educativas y artísticas, culturales y recreativas.

149
Intercambios ESTUDIANTILES
UNA UNIVERSIDAD SIN FRONTERAS

→ Educación internacional
Nuestro objetivo y compromiso es promover una educación internacional. Esto incluye, la adquisición de una visión global, el conocimiento de otras culturas e idiomas y el desarrollo de las destrezas necesarias para desempeñarse en un ambiente internacional. La Universidad fomenta el intercambio - tanto presencial como virtual - de estudiantes y profesores con el fin de exponerlos a experiencias enriquecedoras que añaden valor a su educación. La Inter prepara a sus estudiantes para que muestren sensibilidad multicultural, capacidad de comunicarse efectivamente y respeto por la diversidad.
150
→ Experiencias internacionales para nuestros estudiantes




A partir del segundo año de estudios, nuestros estudiantes podrán seleccionar entre una gran variedad de países internacionales de acuerdo a su programa académico, intereses e inquietudes profesionales. Esto gracias a los más de noventa acuerdos de colaboración que tenemos con otras instituciones y organizaciones internacionales.
Algunos países a escoger son: Argentina, Brasil, Chile, Colombia, España, Estados Unidos de América, Italia, Panamá, Reino Unido, República Dominicana y la República Popular de China.
Además, los estudiantes tienen a su disposición los centros universitarios internacionales de la Inter donde constantemente se desarrollan nuevos proyectos y oportunidades:
• Centro Universitario Inter Panamá en la Ciudad del Saber, Ciudad Panamá
• Inter Philadelphia Education Center, Pensilvania
• Centro Cibernético de Orlando, Florida
→ Programas de internado
Los estudiantes que tengan aprobados 12 créditos o más y le interese enriquecer lo aprendido en el salón de clase mediante experiencias reales de trabajo relacionadas con su especialidad, pueden solicitar participación en programas de internado, si cualifican.
La facultad del programa podrá recomendar dicha convalidación. Esta experiencia no sustituye la práctica requerida por su programa de estudios. A través del Decano de Estudiantes y del Decano de Asuntos Académicos de cada recinto se obtiene información de los programas de internado.
151
Acreditaciones de PROGRAMAS ACADÉMICOS
GRADOS ASOCIADOS
Grado Asociado en Ciencias
Aplicadas en Enfermería
Accreditation Commission for Education in Nursing (ACEN)

AGUADILLA Y METROPOLITANO
Grado de Asociado en Ciencias Aplicadas en Tecnología Radiológica
Joint Review Committee on Education in Radiologic Technology (JRCERT)
PONCE Y SAN GERMÁN
Grado de Asociado en Ciencias Aplicadas en Técnico Veterinario
American Veterinary Association (AVMA) Committee on Veterinary Technician Education (CVTEA)
BACHILLERATOS
Bachillerato en Artes en Trabajo Social Council on Social Work Education (CSWE) ARECIBO, AGUADILLA, FAJARDO Y METROPOLITANO
Bachillerato en Ciencias en Tecnología Médica
National Accrediting Agency for the Clinical Laboratory Sciences (NAACLS)
METROPOLITANO Y SAN GERMÁN
IMPORTANCIA DE LOS PROGRAMAS ACREDITADOS
La acreditación es un proceso voluntario de evaluación al que se someten las universidades. El mismo es realizado por equipos de pares. Esto significa que el proceso de evaluación es realizado por profesionales de diversas instituciones educativas. La acreditación es utilizada por las universidades y otras instituciones de educación superior para mantener y fortalecer la calidad de la oferta académica y de los procesos de apoyo relacionados a la academia. El fundamento de la acreditación es proteger y servir al interés público, así como proteger los fondos públicos asignados para la educación superior. Los estudiantes y la sociedad pueden tener confianza en el valor de los grados otorgados por una institución acreditada. La acreditación también puede facilitar la transferencia de créditos entre universidades.
Certificado Post Bachillerato en Tecnología Médica
National Accrediting Agency for the Clinical Laboratory Sciences (NAACLS)
METROPOLITANO Y SAN GERMÁN
Bachilleratos en Programas de Preparación de Maestros (PEM):
→ BA en Educación en la Niñez
Temprana: Nivel Preescolar
→ BA en Educación en la Niñez
Temprana: Nivel Elemental Primario (K-3)
→ BA en Educación en la Niñez
Temprana: Nivel Elemental (4-6)
→ BA en Educación Elemental en Educación Especial
→ BA en Educación Secundaria en Biología
→ BA en Educación Secundaria en Historia
→ BA en Educación en Español
→ BA en Educación Física en el Nivel
Elemental
→ BA en Educación Física en el Nivel Secundario
→ BA en Enseñanza del Inglés como Segundo Idioma en el Nivel
Elemental
→ BA en Enseñanza del Inglés como Segundo Idioma en el Nivel Secundario
152
→ BA en Educación Secundaria en Matemáticas
Council for the Accreditation of Education Preparation CAEP
AGUADILLA, ARECIBO, FAJARDO Y METROPOLITANO
(Oferta de programa puede variar por recinto)
Bachillerato en Ciencias de Enfermería
Accreditation Commission for Education in Nursing (ACEN)
AGUADILLA, ARECIBO Y METROPOLITANO
Bachillerato en Ciencias de Enfermería
Commission on Collegiate Nursing Education (CCNE)

SAN GERMÁN, BARRANQUITAS, BAYAMÓN, GUAYAMA Y PONCE
AVIACIÓN
Bachillerato en Ciencias de Aviación: Administración de Sistemas de Aviones (Piloto Profesional)
Aviation Accreditation Board International (AABI)
BAYAMÓN
Bachillerato en Ciencias de Aviación: Gerencia de Aviación
Aviation Accreditation Board International (AABI)
BAYAMÓN
INGENIERÍA
→ BS en Ingeniería Mecánica
→ BS en Ingeniería Industrial
→ BS en Ingeniería Eléctrica
→ BS en Ingeniería de Computadoras (N)
Accreditation Board for Engineering and Technology (ABET)
BAYAMÓN
ADMINISTRACIÓN DE EMPRESAS
→ BBA en Contabilidad
→ BBA en Administración de Empresas General
→ BBA en Desarrollo Empresarial y Gerencial
→ BBA en Finanzas
→ BBA en Gerencia de Operaciones de Manufactura y Servicio
→ BBA en Gerencia de Recursos
Humanos
→ BBA en Mercadeo
→ BA en Administración de Sistemas de Oficina
→ MBA con Especialidad en Recursos
Humanos
Accreditation Council for Business Schools and Programs (ACBSP)
BAYAMÓN, FAJARDO Y METROPOLITANO
→ BBA en Administración Turística
UNWTO-TedQual World Tourism Organization
FAJARDO
Bachillerato en Ciencias en Tecnología Veterinaria
American Veterinary Association (AVMA) Committee on Veterinary Technician Education (CVTEA)
MAESTRÍAS
Maestría en Ciencias en Anestesia
Council on Accreditation of Nurse Anesthesia Educational Program (COA)
ARECIBO
Maestría en Trabajo Social con Especialidad en Trabajo Social Clínico
Council on Social Work Education (CSWE)
METROPOLITANO
MA Trabajo Social con Especialidad en Administración
Council on Social Work Education (CSWE)
METROPOLITANO
PROGRAMAS DE ADMINISTRACIÓN DE EMPRESAS
→ BBA en Contabilidad
→ BBA en Desarrollo Empresarial y Gerencial
→ BBA en Finanzas
→ BBA en Gerencia de Recursos Humanos
→ BBA en Mercadeo
→ BBA en Tecnología de la Información
→ MBA Especialidad en Contabilidad
→ MBA Especialidad en Finanzas
→ MBA Especialidad en Programa General
→ MBA Especialidad en Gerencia de Recursos Humanos
→ MBA Especialidad en Gerencia Industrial
→ MBA Especialidad en Sistemas de Información Gerencial
→ MBA Especialidad en Mercadeo
→ PhD. en Desarrollo Empresarial y Gerencial con Especialidad en Recursos Humanos
→ PhD. en Desarrollo Empresarial y Gerencial con Especialidad en Negocios Interegionales e Internacionales
International Assembly for Collegiate Business Education (IACBE)
SAN GERMÁN
OTRAS ACREDITACIONES
Se acredita el esfuerzo internacionalización de los programas en:
Ciencias Económicas y Administrativas (CEA), en Negocios Network of International Business Schools NIBS
METROPOLITANO
Se acredita la calidad de los procesos académicos y administrativos de: Ciencias Económicas y Administrativas (CEA)
ISO 9001: 2015
METROPOLITANO
EDUCACIÓN CONTINUA
Actividades de Educación Continua International Association for Continuing Education and Training (IACET)
TODAS LAS UNIDADES ACADÉMICAS
JURIS DOCTOR
Juris Doctor
American Bar Association (ABA) FACULTAD DE DERECHO
DOCTORADO EN OPTOMETRÍA
Área Clínica Doctorado en Optometría
Accreditation Council on Optometric Education (ACOE) ESCUELA OPTOMETRÍA
153
Pasos para solicitar admisión y requisitos académicos
GRADOS ASOCIADOS Y BACHILLERATOS
Accede
http://admisiones.inter.edu o escanea el QR code: Solicita admisión aquí

Sigue las instrucciones para crear tu cuenta. No olvides completar todos los encasillados requeridos en tu solicitud de admisión electrónica. Si necesitas asistencia, puedes llamar al 787.766.1912, exts. 2618, 2351 o 2600.

Información detallada sobre requisitos de admisión en http://admisiones.inter.edu.
Los requisitos de admisión para programas académicos específicos prevalecen. Los solicitantes deben referirse al Catálogo General vigente. Información detallada en http://documentos.inter.edu, Asuntos Académicos/Catálogos Subgraduados.
Visite
www.inter.edu/homeschoolers para información detallada de los requisitos de admisión para estudiantes procedentes de aprendizaje en el hogar (Homeschooling).
154
NUEVAS RESIDENCIAS ESTUDIANTILES

Las residencias estudiantiles Inter Metro cuentan con servicios medidos de agua y electricidad, conexión Wi-Fi, generadores y cisterna, mobiliario, estufa, microondas-extractor, nevera, calentador y acondicionador de aire. También ofrece áreas comunes, salones de estudio, gimnasio y salón de juegos pasivos. Hay un salón para ver televisión y usar computadoras, capilla y lavandería. Las residencias proveen estacionamiento para residentes y visitantes, área de correo, espacios comerciales, puente peatonal, acceso controlado, seguridad y vigilancia electrónica.



¡RESERVA YA!
Para más información, puede comunicarse al teléfono 787.250.1912, ext. 2277 o escribir a:
asuntosestudiantiles@intermetro.edu.
La Universidad Interamericana de Puerto Rico posee licencia de renovación por la Junta de Instituciones Postsecundarias de Puerto Rico. La Universidad Interamericana es una institución acreditada y miembro de la Middle States Commission on Higher Education (MSCHE) www.msche.org. El estatus de acreditación de la Universidad Interamericana es de Acreditación Reafirmada. La acción más reciente de la Comisión sobre el estatus de acreditación de la institución en 2013 fue reafirmar la acreditación. La MSCHE es una agencia de acreditación institucional reconocida por el U.S. Secretary of Education y el Council for Higher Education Accreditation (CHEA). La oferta profesional y las acreditaciones de los programas académicos pueden variar según la unidad académica. Existen ayudas financieras, si el solicitante tiene derecho a ellas. Ningún estudiante/solicitante será discriminado por motivos de raza, color, religión, género, origen nacional, edad, estado civil, apariencia física, afiliación política o cualquier otra clasificación protegida por el Título IX de la Ley de Educación de 1972, por la Sección 504 de la Ley de Rehabilitación de 1973, por la Ley de Estadounidenses con Discapacidades de 1990, en su versión modificada, o por cualquier otra ley o reglamento estatal o federal aplicable.
OFERTA ACADÉMICA REVISADA A JULIO 2023



Chef Descubre todos los cursos disponibles y localidades alrededor de la Isla en www.inter.edu. Más de 300 programas académicos Certificados Técnicos • Grados Asociados • Bachilleratos • Maestrías • Doctorados • Certificados Profesionales Universidad Interamericana de Puerto Rico Oficina de Promoción y Reclutamiento Estudiantil PO Box 363255 San Juan, P.R. 00936-3255
































































































































































































 | PON |
| PON |




 | AGU |
| AGU |





































 | BAY |
| BAY |

| BAY |
| BAY |




























































 | SG |
| SG |









 La UIPR posee Licencia de la Junta de Instituciones Post Secundarias de Puerto Rico y está acreditada por la Middle States Commission on Higher Education, 1007 North Orange Street 4th Floor, MB #166 Wilmington, DE 19801. (267-284-5000). La Middle States Commission on Higher Education es una agencia de acreditación reconocida por el Secretario de Educación de los EE.UU. y por el Council for Higher Education Accreditation.
La UIPR posee Licencia de la Junta de Instituciones Post Secundarias de Puerto Rico y está acreditada por la Middle States Commission on Higher Education, 1007 North Orange Street 4th Floor, MB #166 Wilmington, DE 19801. (267-284-5000). La Middle States Commission on Higher Education es una agencia de acreditación reconocida por el Secretario de Educación de los EE.UU. y por el Council for Higher Education Accreditation.
















































